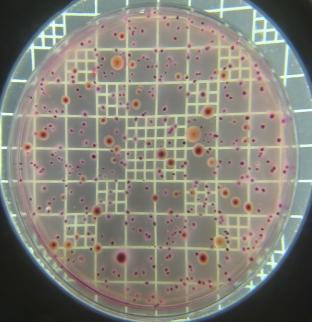
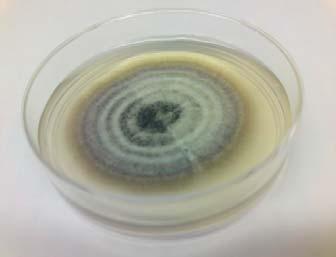
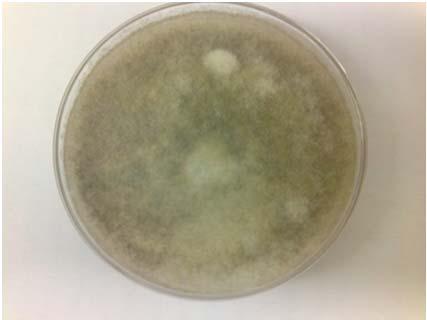

Temas Selectos de Ingeniería deAlimentos

DIRECTORIO
TEMAS SELECTOS DE INGENIERÍA DE ALIMENTOS
UNIVERSIDAD DE LAS AMÉRICAS PUEBLA
PUBLICACIÓN SEMESTRAL
VOLUMEN 4, NÚMERO 2 (AGOSTO-DICIEMBRE 2010)
EDITORA RESPONSABLE
María Eugenia Bárcenas Pozos
CONSEJO EDITORIAL
María Teresa Jiménez Munguía
Emma Mani López
María Elena Sosa Morales
Fidel Tomás Vergara Balderas
CERTIFICADO DE RESERVA DE DERECHOS:
04-2010-080615025900-102
CERTIFICADO DE LICITUD DE TÍTULO Y CONTENIDO: 15430
DOMICILIO:

Fundación Universidad de las Américas Puebla
Exhacienda Santa Catarina Mártir S/N
San Andrés Cholula, Pue.
C.P. 72810 México
Teléfono: 222 229 2126
DISTRIBUIDO POR:
Departamento de Ingeniería Química, Alimentos y Ambiental
Fundación Universidad de las Américas Puebla
IMPRESIÓN:
Gutiérrez Mora Carina
18 Sur 6130 Local A. Col. Jardines San Manuel
Puebla, Pue. C.P. 72570

Temas Selectos de Ingeniería de Alimentos Vol. 4 / No. 2

Cuerpo editorial
Dra. María Eugenia Bárcenas Pozos
Dra. María Teresa Jiménez Munguía
M. C. Emma Mani López
M. C. Fidel Vergara Balderas

Contenido
Volumen 4 / No. 2 Ago – Dic 2010

Cuerpo editorial ………………………………………………………………………………….
Artículos de Revisión
Acrilamida en alimentos: sus causas y consecuencias
B. E. Enríquez - Fernández* y M. E. Sosa - Morales…………………...……………………….....
Hongos fitopatógenos de alta importancia económica: descripción y métodos de control
G. P. Juárez-Becerra*, M. E. Sosa-Morales y A. López-Malo …………………...…..………...…
Estructura y funcionalidad de proteínas lácteas: Efecto de modificaciones inducidas por medios físicos, químicos y enzimáticos
K. Zimmermann - Stein* y H. Ruiz – Espinoza
Efectos del calentamiento con microondas en alimentos fluidos
V. Reyes-García*, A. López-Malo y M. E. Sosa-Morales …………………………………………
Probióticos: resistencia gastrointestinal y microencapsulación
V. Rodríguez - Guerrero*, J. A. Guerrero – Beltrán
Frutas conservadas por métodos combinados
M.E. González-Miguel*, A. López-Malo ……………………………………………….………….

Editorial
Temas Selectos de Ingeniería de Alimentos Vol. 4 / No. 2

Los profesores del Departamento de Ingeniería Química, Alimentos y Ambiental, estamos conscientes de la gran importancia que la escritura de artículos científicos tiene en la formación de los estudiantes de posgrado. Por ello, continuamos haciendo un esfuerzo por publicar la revista “Temas Selectos de Ingeniería de Alimentos”.
En esta ocasión presentamos el número 2 del volumen 4, correspondiente al periodo AgostoDiciembre de 2010, con el cual se cumplen tres años de publicación de la revista. Los artículos que constituyen este número estuvieron a cargo de las estudiantes que cursaron el tercer semestre de la Maestría en Ciencia de Alimentos. Todos ellos son revisiones del estado de la ciencia de los temas de tesis de las alumnas autoras.
Merece la pena comentar que el proceso de escritura y revisión de los artículos publicados en esta revista incluye varias etapas, de modo que los estudiantes centren su atención en aspectos como síntesis, análisis, coherencia, consistencia, fondo y forma, entre otros. La escritura es supervisada por los asesores de tesis y la revisión es llevada a cabo por dos miembros del comité editorial, teniendo presente que el propósito de la elaboración de los artículos es, más que la publicación, el aprendizaje. Dicho comité está formado por profesores del departamento, quienes participan en esta actividad de manera voluntaria y con el único fin de contribuir a la formación integral de los futuros investigadores. Por ello, a nombre de los estudiantes y de la facultad de la Maestría y el Doctorado en Ciencia de Alimentos, deseo agradecer a los profesores Fidel T. Vergara Balderas, María Teresa Jiménez Munguía y Emma Mani López su labor entusiasta en la realización de cada número de la revista, así como el ejemplo de compromiso y colaboración que con su participación brindan.
María Eugenia Bárcenas Pozos
Coordinadora de la Maestría y el Doctorado en Ciencia de Alimentos

Temas Selectos de Ingeniería de Alimentos 4-2 (2010): 1-13
Acrilamida
en alimentos: sus causas y consecuencias
B. E. Enríquez - Fernández* y M. E. Sosa - Morales

Departamento de Ingeniería Química, Alimentos y Ambiental, Fundación Universidad de las Américas Puebla. Sta. Catarina Mártir, Cholula, Puebla. C.P.72820. México.
Resumen
La acrilamida es un monómero utilizado ampliamente en la industria química y textil. Su relevancia en la industria alimentaria surgió luego de un estudio en 2002 en el cual se encontró la presencia de este compuesto en alimentos cocinados a altas temperaturas como papas fritas y galletas, entre otros. A partir de entonces diversos estudios han sido realizados con el propósito de conocer más sobre éste compuesto, sus características y potenciales riesgos. Esta revisión presenta estudios experimentales acerca del contenido de acrilamida en diversos alimentos, sus métodos de análisis, así como sus mecanismos de formación más estudiados, los métodos que permiten disminuir su formación clasificándolos con base en sus propósitos, y estudios realizados para determinar sus daños a la salud, con objetivo de dar un panorama general sobre el conocimiento actual de este compuesto, y las alternativas que existen a nivel industrial y como consumidor de disminuir su ingesta.
Palabras clave: acrilamida, procesamiento de alimentos, seguridad de alimentos, disminución, toxicidad.
Abstract
Acrylamide is a monomer widely used in the chemical and textile industries. In the food industry, it became important since 2002, when an investigation showed the presence of this compound in food cooked under high temperatures, such as potato chips, and cookies. Thereafter, several studies have been developed with the purpose to understand the characteristics and behavior of this compound, as well as its potential risks. This review summarizes some experimental studies about the acrylamide content in foods, the most reliable and studied formation mechanisms, methods to reduce this content, classified according to their purpose, and several studies to determine the potential risk to people. The objective is to present a general overview about the actual knowledge of this compound, and alternatives for the industry and consumers to diminish acrylamide intake from food.
Keywords: acrylamide, food processing, food security, reduction, toxicity.
Introducción
*Programa de Maestría en Ciencia de Alimentos
Tel.: +52 222 229 2126, fax: +52 222 229 2727
Dirección electrónica: blancae.enriquezfz@udlap.mx
La acrilamida (CH2=CH–CONH2) es un monómero utilizado a nivel industrial desde los años 50’s, está presente en el humo del tabaco, y es usado en la síntesis de poliacrilamida para su utilización en procesos como purificación de agua, separación de proteínas para bioquímica analítica y acondicionamiento de suelos (Allan, 2002). Su descubrimiento se origina a partir de
resultados de la formación de un aducto específico entre ésta y la hemoglobina humana (Masson et al., 2007).
Es un compuesto muy reactivo y se ha estudiado por los daños que puede provocar luego de exposiciones prolongadas. Al estudiar acerca de la presencia de acrilamida en la sangre, y encontrarla en personas que nunca habían estado expuestas directamente, Tareke et al. (2002) evaluaron diferentes alimentos, encontrando niveles desde moderados a altos de este compuesto en algunos de ellos. De esta manera, surgió el interés por evaluar la acrilamida en los alimentos, así como su origen y los daños que su ingesta puede ocasionar en el organismo humano.
Diversos estudios comprobaron la presencia de acrilamida en alimentos, particularmente en aquellos con alto contenido de carbohidratos (El-Ziney et al., 2009). Posteriormente los estudios fueron encaminados hacia los mecanismos mediante los cuales pudiera ocurrir la formación de acrilamida, conociéndose actualmente que el mecanismo más probable es mediante la reacción de Maillard, particularmente la que ocurre entre la glucosa y la asparagina (Mottran et al., 2002; Stadler et al,. 2002). Una vez conocidos sus mecanismos de formación, el énfasis ha estado en encontrar métodos o ingredientes que permiten la disminución del contenido final de acrilamida en alimentos, desde la modificación en las materias primas, hasta su inactivación y eliminación una vez que ha sido formada. Sin embargo, muchos de ellos no son muy recomendables ya que modifican las características de calidad y sensoriales de los productos (Anese et al., 2009).
Así mismo, debido a que se conoce que la exposición prolongada a la acrilamida a través de la piel puede provocar daños desde entumecimientos hasta carcinogénesis, diversos estudios han evaluado los riesgos que
conlleva la ingesta de acrilamida a través de los alimentos, realizando pruebas en animales y analizando a pacientes con cáncer, para determinar si la acrilamida fue un factor de riesgo (Friedman, 2003).
Esta revisión pretende dar un panorama general del conocimiento actual respecto a la acrilamida, resumiendo sus características generales, enumerando los alimentos que la contienen en mayor concentración, presentando los métodos más comunes y más confiables para su detección, y los estudios que han buscado determinar su riesgo a la salud, y finalmente presentando los métodos que permiten la reducción del contenido final de acrilamida.
Revisión Bibliográfica
1. Aspectos generales de la acrilamida
La acrilamida (2-propanamida) es un compuesto altamente soluble en agua y su peso molecular es bajo (71.09 g/mol). Es un monómero vinílico que se usa tanto a nivel industrial como en procesos de laboratorio. Su uso más importante es la producción de poliacrilamida de alto peso molecular, utilizada para proporcionar a los materiales propiedades iónicas (El-Ziney et al., 2009). Algunas de las aplicaciones más comunes de esos polímeros son: tratamiento de agua para beber, procesamiento de petróleo, papel, minerales, concreto y textiles, en la industria de los cosméticos, en cirugías oftálmicas, en plásticos, en lentes de contacto, y en emulsiones y adhesivos, además de estar presente en el humo del tabaco (Sharma et al., 2008).
A nivel comercial se produce por hidrólisis catalítica del acrilonitrilo. Puede encontrarse tanto en estado sólido o cristalino, como líquido o acuoso. El monómero sólido es
incoloro y es un cristal soluble en agua, metanol, etanol, acetona y dimetil éter, e insoluble en benceno y heptano (Sharma et al., 2008).
La acrilamida es absorbida por los animales y los seres humanos, vía ingestión, inhalación o a través de la piel. Tiene dos sitios reactivos, el grupo amida y el doble enlace conjugado, éste último puede participar en reacciones nucleofílicas con grupos funcionales que tengan hidrógeno activo como los grupos SH de la cisteína, homocisteína y el glutatión, o los radicales R-NH2 de aminoácidos libres y proteínas. La exposición de la acrilamida a pH muy alto o bajo provoca su hidrólisis a ácido acrílico y amoniaco (Friedman, 2003).
2. Acrilamida en alimentos
Desde el 2002 se ha demostrado que la acrilamida se forma en algunos alimentos, especialmente aquellos que involucran durante su procesamiento el uso de altas temperaturas como el freído, horneado o secado (El-Ziney et al., 2009). Tomando en cuenta que entre
4 – 2 (2010): 1-13
mayor concentración de acrilamida por cada kg de peso corporal se tiene un mayor riesgo, los niños están en mayor peligro que los adultos. En el caso de los bebés, Sorgel et al. (2002) encontraron que de 10 a 50% de la acrilamida consumida en la dieta de las mujeres embarazadas, es transferida vía sangre a los fetos, además de transferirse a través de la leche materna. Por tanto, se recomienda a mujeres embarazadas no consumir o reducir el consumo de alimentos con alto contenido de acrilamida.
2.1. Formación de acrilamida en alimentos
Desde que se detectó la presencia de acrilamida en alimentos, ha sido sumamente estudiado su mecanismo de formación. Entre las hipótesis de su formación, la reacción de Maillard de pardeamiento, que involucra la reacción a altas temperaturas entre los aminoácidos libres (especialmente la asparagina) y azúcares reductores como la glucosa o fructosa, ha sido de las más estudiadas (Mottran et al., 2002; Stadler et al.,

Fig. 1. Mecanismo de formación de acrilamida. (Adaptada de Friedman y Levin, 2008).

2002). Además es necesario considerar que otros aminoácidos que producen bajas cantidades de acrilamida son: alanina, arginina, ácido aspártico, cisteína, glutamina, metionina, treonina y valina (Masson et al., 2007).
La reacción de Maillard se ilustra mediante las Fig. 1 y 2, donde se aprecia la reacción entre la asparagina y un azúcar reductor mediante dos mecanismos, el primero (1) con la transformación de la asparagina y el azúcar a una base de Schiff descarboxilada, que posteriormente es transformada a acrilamida con 3-aminopropionamida como intermediario; mientras que en el mecanismo 2, el flujo de electrones lleva directamente a la acrilamida sin la formación del intermediario 3-aminopropionamida (Friedman y Levin, 2008).
Además del mecanismo anterior, se ha investigado el mecanismo de formación de acrilamida a partir de lípidos (Ehling et al., 2005), identificando al ácido acrílico como un precursor potencial. Esta teoría ha provocado estudios sobre la influencia del aceite de freído
en el contenido final de acrilamida, pues se ha observado que la acroleína (formada por la rancidez oxidativa) puede reaccionar por oxidación para dar ácido acrílico, o formar un radical acrílico intermedio, ambos compuestos en presencia de nitrógeno y bajo condiciones de reacción favorables, pueden dar lugar a la formación de acrilamida (Taeymans et al., 2004). Dicha formación puede ocurrir cuando la acroleína (producto de la oxidación de los ácidos grasos) es directamente transformada a acrilamida por una reacción con NH3 para luego oxidarse a acrilamida, o la acroleína puede reaccionar con asparagina directamente y formar un N-glicósido, que posteriormente se transforma a acrilamida (Friedman, 2003). Por su parte, en su estudio acerca del mecanismo de formación de acrilamida en alimentos, Zyzak et al. (2003) evaluaron diferentes compuestos carbonílicos (Dglucosa, 2-desoxiglucosa, ribosa y gliceraldehído) para observar la reacción con asparagina y el mecanismo de formación de acrilamida, confirmando mediante la presencia de espectrometría de masas, la presencia de los intermediarios de la reacción.
Fig. 2. Mecanismo de formación de acrilamida directamente mediante el flujo de electrones (Adaptada de Friedman y Levin, 2008).
2.2. Métodos de análisis
Debido a la alta solubilidad y reactividad y la carencia de un grupo cromóforo, la acrilamida no es fácilmente detectable (Mottran et al., 2002). Sin embargo, existen diversos métodos utilizados para su detección, inicialmente para agua, fluidos biológicos, y alimentos no cocinados, la mayoría de ellos basados en cromatografía líquida de alta resolución (HPLC) o cromatografía de gases. Sin embargo, debido a la complejidad de los sistemas alimenticios, ha sido necesario ir desarrollando otros métodos con alta sensibilidad. Los métodos posteriores se enfocaron en una combinación de cromatografía líquida o cromatografía de gases, con espectrometría de masas (LC-MS, o GC-MS, respectivamente, por sus nombres en Inglés) (Taeymans et al., 2004; Tareke et al., 2002). La ventaja de los métodos basados en LC-MS es que la acrilamida puede analizarse sin necesidad de realizar una derivatización previa, simplificando el análisis (Masson et al., 2007). Otro método es la Reacción de Transferencia de Protones seguida de espectometría de masas (PTR-MS), el cual es un método conveniente por sus rápidas mediciones (Masson et al., 2007).
Los estudios realizados han mostrado que la extracción incompleta es la causa más probable de error en la determinación de acrilamida, ya sea porque el alimento no se dividió correctamente, se usaron solventes orgánicos en la extracción, o el tiempo es corto y la temperatura baja durante la extracción. Otra causa de error ha sido la destrucción de la acrilamida durante la extracción. Por tanto, un reto existente es el desarrollo de métodos confiables y aplicables a diferentes sistemas, que permitan el análisis de alimentos complejos, ya que actualmente los métodos han mostrado gran variabilidad de una muestra a otra y no existe un método confiable y con alto umbral de detección aplicable a todos los
alimentos (Taeymans et al., 2004). Además, su análisis se complica debido a que la acrilamida es una sustancia reactiva y volátil que puede autodegradarse luego de su formación (Masson et al., 2007).
2.3. Alimentos con mayor contenido de acrilamida
Como se ha expuesto, la presencia de acrilamida en alimentos se ha observado principalmente en aquellos ricos tanto en glucosa como en asparagina, y que son sometidos a procesos de calentamiento como horneado o freído. La mayoría de esos alimentos son derivados de origen vegetal como las papas y cereales. Entre estos alimentos, los que han presentado niveles más altos son: las papas a la francesa, papas y tortillas fritas, corteza de pan, y pan tostado, entre otros.
El-Ziney et al. (2009) evaluaron diferentes alimentos de Arabia Saudita con alto contenido de carbohidratos expuestos durante su proceso de elaboración a altas temperaturas. Dichos alimentos los clasificaron en grupos dependiendo de sus características: papas fritas, maíz y extruidos, berenjenas, panes, bizcochos, galletas, pescados, dulces y caramelos, fórmulas infantiles, y fórmulas infantiles en polvo adicionadas con frutas o cereales. Los resultados obtenidos se muestran en la Tabla I junto con alimentos y su contenido reportado de acrilamida.
Sin embargo, la información reportada debe tomarse con precaución, ya que el contenido de acrilamida puede ser muy variable incluso con el mismo alimento producido en diferentes lugares, o entre productos de la misma marca, ya que depende en gran medida de la cantidad de precursores iniciales, y del proceso mediante el cual fue realizado (Friedman y Levin, 2008).
2.4. Métodos para disminuir su formación
Con el creciente interés en el contenido de acrilamida en alimentos, se han realizado diversos estudios con el propósito de plantear alternativas que permitan su reducción. Para lograrlo, se han tomado diferentes enfoques,
desde reducir la concentración de los precursores, hasta eliminar la acrilamida ya formada. Es por esto que a continuación se mencionan algunos de los enfoques, así como estudios realizados en este respecto, y sus resultados.
Tabla I. Niveles de acrilamida en algunos alimentos y bebidas.
GrupoAlimento
Palomitas de maíz
Totopos
Maíz
Papas
Pan
Extruidos con sal
Tortillas (de harina y maíz) 6 b
Papas fritas 466 b
Papas a la francesa 206a ; 413b
Pan tostado
Café
Galletas Cárnicos
Donas con levadura
Hot cakes y waffles
Pan blanco
Pastel
Café soluble variedad Robusta
Café tostado variedad Arábica
Café de grano
Integrales
Con chispas de chocolate
Con miel
Chile con carne
Pescado a la parrilla
Nuggets de pollo
Pescado frito
Almendras (fritas o tostadas)
Semillas
Cereales listos para comer
Otros
Cacahuates tostados
Cereal de avena
Hojuelas de maíz
Arroz inflado
Granola
Pizza
Fórmulas para bebés 10-30 a
a El-Ziney et al. (2009); b Friedman y Levin (2008)
a) Reducción en la concentración de los precursores:
Una disminución en el contenido de asparagina puede darse de varias maneras, una es seleccionar de los vegetales disponibles y sus variedades aquellos con el menor contenido de este aminoácido, ya que al estudiar la formación de acrilamida en productos derivados de cereales, se ha observado que mientras más alto es el contenido de asparagina inicial en el trigo, mayor es la concentración de acrilamida en el producto final. Se han evaluado los factores que propician la alta concentración de este aminoácido, encontrando por ejemplo que el trigo cultivado en suelos con bajos niveles de sulfatos tiene hasta 30 veces más asparagina que el cultivado en suelos regulares (Friedman y Levin, 2008). Lo mismo ocurre con las papas, donde la variedad y el suelo de cultivo generan diversas cantidades de carbohidratos y de asparagina, por lo que es necesario seleccionar la variedad con menor cantidad de esos azúcares reductores (Taeymans et al., 2004).
Otro método para disminuir el contenido de asparagina sería inducir su hidrólisis a ácido aspártico y amoniaco mediante bajos pH y/o catalizada por asparaginasa, y finalmente otra opción sería acetilar la asparagina a Nacetilasparagina, previniendo de esta manera la formación de intermediarios N-glicosídicos que forman la acrilamida. También debe cuidarse la temperatura de almacenamiento de papas ya que influye en la cantidad de almidón que es degradado a glucosa, pues se favorece a temperaturas menores a 8°C, pero por estabilidad se almacenan a menores temperaturas (Friedman, 2003).
b) Condiciones de procesamiento durante el horneado y tostado de pan:
Surdyk et al. (2004) evaluaron el contenido de acrilamida en pan, encontrando que más del
99% de la acrilamida, se encuentra en la corteza, debido a las temperaturas alcanzadas, y además ese contenido está fuertemente relacionado con el color final adquirido. En otro estudio, se concluyó que un mayor tiempo de horneado causa un incremento en la concentración de acrilamida, y que las partes más tostadas o ennegrecidas del pan son las del contenido más alto de acrilamida, por lo que se recomienda como consumidor no tostar en exceso el pan, o raspar para remover las partes ennegrecidas (Friedman y Levin, 2008).
Otra opción es la fermentación de la masa, pues por ejemplo en masa de trigo y centeno para la elaboración de donas, permite una reducción en el contenido de asparagina, siendo ésta reducción directamente proporcional al tiempo de fermentación (Friedman y Levin, 2008).
c) Efecto de los ingredientes:
La adición o sustitución de algunos ingredientes puede ser benéfica o inducir un mayor desarrollo de acrilamida, como en el caso del bicarbonato de amonio que causa mayor desarrollo, en comparación con el uso de bicarbonato de sodio (Amrein et al., 2006). En cambio, la adición de glicina permite una reducción en el contenido de acrilamida, por lo que se sugiere rociarla sobre la superficie de la masa fermentada (Friedman y Levin, 2008).
El reemplazo de azúcares reductores por otros edulcorantes como la sacarosa (siempre y cuando no se realice también un descenso en el pH), y trehalosa permiten reducir el contenido de acrilamida, lo cual también ocurre con adición de ácido cítrico a sistemas con glucosa. Por otro lado, la adición de antioxidantes en alas de pollo fritas, papas fritas y galletas permite disminuir la cantidad final de acrilamida, a diferencia de lo ocurrido en té donde a pesar de los antioxidantes, la cantidad de acrilamida llega a ser muy alta. También, el contenido de humedad juega un
papel muy importante en la formación de acrilamida ya que una baja humedad provoca que la energía de activación de la reacción sea mayor. De esta forma, a actividades de agua intermedias el contenido de acrilamida final será mayor, y a humedades muy altas el contenido de acrilamida y el oscurecimiento disminuyen (Friedman y Levin, 2008).
d) Efectos del procesamiento:
El uso de microondas para elaborar palomitas de maíz permite una reducción de la acrilamida en comparación con el procesamiento normal. De igual forma, un tratamiento de precocción con microondas de tiras de papa redujo la concentración de acrilamida hasta en un 60%, aún a temperaturas de 190°C (Friedman y Levin, 2008).
En el proceso de freído, la temperatura y el tiempo de freído son los factores que más afectan el contenido de acrilamida, por ejemplo se ha estudiado que el uso de presiones de vacío y menores temperaturas permiten reducciones de hasta 94% de acrilamida (Granda et al., 2004).
En relación con la temperatura, estudios de distintos autores demostraron que el límite inferior para formación de acrilamida es 120°C (Mottran et al., 2002; Becalski et al., 2003). A más de 150°C la producción de acrilamida aumenta significativamente, probablemente debido a que a esa temperatura la humedad del producto se encuentra debajo de los mínimos críticos y la reacción se acelera, aunque otros autores establecen que la temperatura crítica es 175°C (Masson et al., 2007). En la misma línea, Romani et al. (2008) evaluaron el tiempo de freído en papas fritas y su relación con el contenido de acrilamida, observando que este último se incrementó exponencialmente con el aumento tanto del tiempo como de la temperatura de freído. Y de acuerdo con el contenido de acrilamida, así
como la textura, contenido de grasa y color final del producto, concluyeron que 5 minutos de freído permitía las mejores condiciones finales.
La reutilización del aceite de freído ha sido también estudiada, encontrando que aunque los productos de la oxidación pueden ser precursores en la formación de acrilamida, no existió diferencia significativa en una prueba con papas a la francesa (Friedman y Levin, 2008). De la misma manera, Gertz et al. (2003) concluyeron que el tipo de aceite y su estado de rancidez no influyen significativamente en el contenido final de acrilamida. Sin embargo, en otro estudio, el contenido de acrilamida se incrementó hasta 10 veces en papas fritas a 150°C en aceite usado, comparadas con el freído en aceite fresco (Dunovská et al., 2004).
Un tratamiento alternativo propone el uso de radiofrecuencia para calentar las muestras durante el horneado, lo cual permite una reducción de hasta 50% respecto a aquéllos calentados únicamente mediante calentamiento convencional. Dichos tratamientos se basan en que los mecanismos de transferencia de calor cambian, de ser principalmente conducción a involucrar también la radiación. El proceso de horneado asistido con radiofrecuencia puede incluso ser aplicado a nivel industrial sin muchas dificultades (Anese et al., 2009).
e) Destrucción o inactivación de la acrilamida una vez formada:
Puede realizarse mediante hidrólisis ácida, con radiación UV o la inducción de la polimerización de la acrilamida para formar poliacrilamida, mediante la reacción con aminoácidos, ésteres o proteínas conteniendo el radical SH. En todos los casos, siempre y cuando no se afecte la calidad y segurida del producto (Friedman, 2003).
Fan y Mastovska (2006) evaluaron la posibilidad de utilizar radiación ionizante para reducir los niveles de furano y acrilamida en agua y algunos alimentos como embutidos y papas fritas. Los resultados mostraron que después de ser irradiada con 1.5 kGy, se logró la degradación de la mayor parte de la acrilamida contenida en el agua, sin embargo en aceite y las papas fritas, aún a dosis de hasta 10kGy, no se logró una inactivación significativa.
Es importante mencionar que aunque la Reacción de Maillard provoca el desarrollo de acrilamida, como sabemos es una reacción deseable en diversos alimentos por su aportación al sabor, color y aroma de los mismos, por lo que cualquier cambio en los procesos que se realice con el objetivo de disminuir la formación de acrilamida debe buscar también la menor alteración a las propiedades organolépticas finales de los alimentos (Taeymans et al., 2004).
2.5.
Toxicidad
Los estudios en animales reportan que dosis de acrilamida mayores a 203mg/kg de peso corporal causan daños en el desarrollo y en el sistema reproductivo de roedores (Friedman, 2003). Y aunque en seres humanos no se ha establecido un límite exacto, debido a que la Organización Mundial de la Salud ha establecido que el consumo de acrilamida proveniente de los alimentos en países desarrollados puede ser de 0.3 a 0.8 µg/kg de peso corporal/día (aunque puede variar mucho de un país a otro), es importante determinar los daños que la ingesta de alimentos conteniendo acrilamida pueden causar en el organismo humano (WHO, 2002).
Aunque la poliacrilamida es reportada como una sustancia no-tóxica, su forma monomérica, la acrilamida, ha sido estudiada por causar un amplio espectro de efectos tóxicos (Sharma et al., 2008), ya que ha sido
clasificada dentro del Grupo 2A de las sustancias carcinogénicas, es decir un posible carcinogénico para humanos por la Agencia Internacional para la Investigación del Cáncer, IARC por sus siglas en inglés, debido a la suficiente evidencia científica de provocar cáncer en experimentos con animales (IARC, 1994), y dentro de la Categoría 2 como carginogénico y como mutagénico por la Unión Europea (El-Ziney et al., 2009).
De acuerdo con Friedman (2003), el metabolismo de la acrilamida ocurre mediante su reacción con el glutatión en el hígado, dando como resultado la excreción de ácido mercaptúrico, excretado en la orina. En un estudio, Wu et al. (1993) usando un modelo del sistema digestivo humano observaron que la acrilamida es altamente permeable y puede pasar a través de la monocapa del epitelio intestinal vía difusión pasiva, y en ese sistema la albúmina de huevo redujo la biodisponibilidad de éstos compuestos. Por lo que se sugiere que una dieta alta en proteínas permitiría reducir la absorción intestinal de éste monómero hacia la circulación.
La exposición a la acrilamida en fábricas donde se maneja en altas cantidades, ha demostrado causar daños como debilidad, pérdida de reflejos y sensaciones en las extremidades, y entumecimiento de pies y manos. Mientras que la exposición en más altos niveles provoca daños más severos como disfunciones cerebrales y severas neuropatías (Friedman, 2003). Diversos estudios se han realizado con el propósito de evaluar el efecto de la acrilamida en la salud, a continuación se clasifican algunas de esas investigaciones de acuerdo con los efectos estudiados, así como los resultados obtenidos:
a) Efectos adversos en la reproducción
Se ha evaluado el efecto de la acrilamida en la disminución de la fertilidad, ya que afecta la movilidad y morfología del espermatozoide,
además de alterar los balances de estrógenos y progesterona (Tyl y Crump, 2002). De la misma manera, Friedman (2003) menciona que altas dosis de acrilamida (>203mg/kg) provocaron efectos adversos en el desarrollo y reproducción de roedores recién nacidos, como degeneración nerviosa, deficiencia de enzimas intestinales y reducción en la fertilidad.
b) Carcinogénesis
Diversos estudios en animales han mostrado mayor incidencia de algunos tumores relacionados con alto consumo de acrilamida en alimentos. Por ejemplo, induce tumores en las glándulas tiroides, suprarrenales, mamaria, y en la cavidad oral (Rice, 2005), así como tumores en el cerebro y órganos reproductivos de roedores (Friedman, 2003). De la misma manera, en un estudio con ratas que recibieron acrilamida en su agua, se encontró un incremento en la incidencia de tumores de tiroides y de cáncer de mama (Pelucchi et al., 2005).
En lo que respecta a seres humanos, Pelucchi et al. (2005) evaluaron la relación entre algunos tipos de cáncer, y el consumo de acrilamida proveniente de los alimentos. Para lograrlo, realizaron cuestionarios a pacientes diagnosticados con cáncer de mama o en órganos como el esófago, la faringe, el ovario y los intestinos. Al averiguar la dieta de los pacientes, encontraron que no había relación entre el contenido de acrilamida consumida en los alimentos, y el desarrollo de ningún tipo de cáncer. Lo mismo ocurrió en un estudio realizado por Mucci et al. (2003), para cáncer de intestino, vejiga y riñón. En cambio, en una investigación similar realizada por Hogervorst et al. (2007), se concluyó que sí existió un incremento en el riesgo de cáncer endometrial y de ovario en pacientes postmenopáusicos por un aumento en el consumo de acrilamida en la dieta, no observándose esa tendencia en cáncer de seno.
c) Genotoxicidad
Se ha encontrado que la acrilamida es genotóxica, ya que produce daños a nivel cromosómico, y síntesis anormal de ADN (Sharma et al., 2008). Así mismo, en estudios celulares, se mostró que la acrilamida y su principal metabolito, la glicilamida inducen un quiebre cromosómico y puntos de mutación (Rice, 2005).
d)
Daños al sistema nervioso
La acrilamida se ha reportado también como neurotoxina que induce parestesia (sensación anormal de los sentidos o de la sensibilidad general) en los dedos, y además provoca debilidad en las manos, alucinaciones, convulsiones, y daños en el Sistema Nervioso Central, degeneración nerviosa y daño neuronal (Sharma et al., 2008).
La posible explicación para la neurotoxicidad de la acrilamida es que es una molécula bipolar, donde en el doble enlace CH2=CH puede experimentar interacciones hidrofóbicas con los componentes celulares. Esa propiedad le daría la habilidad de alterar las estructuras de la membrana celular y acelerar su difusión y penetración a los sitios de las terminales nerviosas, asociados con sus funciones normales y las del sistema nervioso (Friedman, 2003).
e) Otros efectos
Al evaluar la hepatotoxicidad de la acrilamida, en ratones albinos suizos, Sharma et al. (2008), los resultados mostraron pérdida de peso corporal y aumento del peso del hígado a concentraciones altas, sin embargo dentro de sus conclusiones remarcan el hecho de que son necesarios aún más estudios que permitan extrapolar los daños en animales, a lo que podría causar en seres humanos.
Con base en lo anterior, se observa que aunque en animales se ha demostrado la carcinogénesis, genotoxicidad y la hepatotoxicidad de la acrilamida, en seres humanos los únicos efectos comprobados han sido los daños al sistema nervioso, y un mayor riesgo de cáncer en pacientes postmenopáusicos. Por tanto, aún son necesarios más estudios que permitan conocer sus efectos en la salud humana.
Agradecimientos
A la Universidad de las Américas Puebla y al Consejo Nacional de Ciencia y Tecnología (CONACyT, México) por el financiamiento recibido para la realización de este trabajo.
Referencias
Allan, S. 2002. Acrylamide angst: Another annoying distraction about food safety. Agrochemical and Environmental News. 198:2-13.
Conclusiones
La acrilamida está presente en alimentos sometidos a altas temperaturas durante su procesamiento que involucran la reacción de Maillard principalmente entre la asparagina y la glucosa. Existen diversos métodos para la detección de acrilamida, sin embargo, debido a la gran diversidad de matrices alimenticias, no existe un método general aplicable a todas, por lo que es aún un tema a desarrollar y para investigar al respecto.
La información de diferentes estudios realizados demuestra manifestaciones de que la acrilamida y su principal metabolito, la glicidamida producen neurotoxicidad en seres humanos. Otros efectos como la carcinogénesis, problemas reproductivos, y genotoxicidad sólo se han comprobado en estudios con animales, no así en seres humanos. Sin embargo, los efectos adversos que se han comprobado sugieren que como consumidores, debemos tratar de consumir en menor cantidad aquellos alimentos en los que se ha encontrado alto contenido de acrilamida, y a nivel industrial, deben empezar a implementarse métodos que permitan su reducción, sin afectar las características de calidad del producto.
Amrein, T. M., Andres, L., Manzardo, G. y Amado, R. 2006. Investigations on the promoting effect of ammonium hydrogen carbonate on the formation of acrylamide in model systems. Journal of Agricultural and Food Chemistry. 54:10253-10261.
Anese, M., Suman, M. y Nicolo, M. C. 2009. Technological strategies to reduce acrylamide levels in heated foods. Food Engineering Reviews. 1:169179.
Becalsky, A., Lau, B. P., Lewis, D., y Seaman, S. 2003. Acrylamide in foods: occurrence, sources and modeling. Journal of Agricultural and Food Chemistry. 51:802-808.
Dunovská, L., Hajlová, J., Áajka, T, Holadová, K., Hájková, K. 2004. Changes in acrylamide levels in food products during technological processing. Czech Journal of Food Sciences. 22:283-286. Citado en: Masson, L., Muñoz, J.R., Romero, N., Camilo, C., Encina, C., Hernández, L., Castro, J. y Robert, P. 2007. Acrilamida en patatas fritas: revisión actualizada. Grasas y Aceites. 58(2):185193.
Ehling, S., Hengel., M., Shibamoto, T. 2005. Formation of acrylamide from lipids. En: M. Friedman y D.S. Mottram (Eds). Chemistry and safety of acrylamide in food. Springer, New York. pp. 223-234. Citado en: Friedman, M., y Levin, C. 2008. Review of methods for the reduction of dietary content and toxicity of acrylamide. Journal of Agricultural and Food Chemistry. 56:6113-6140.
El-Ziney, M. G., Al-Turki, A. A. y Tawfik, M. S. 2009. Acrylamide status in selected traditional Saudi foods and infant milk and foods with estimation of daily exposure. American Journal of Food Technology. 4(5):177-191.
Fan, X. y Mastovska, K. 2006. Effectiveness of ionizing radiation in reducing furan and acrylamide levels in foods. Journal of Agricultural and Food Chemistry. 54:8266-8270.
Friedman, M. 2003. Chemistry, biochemistry, and safety of acrylamide. A review. Journal of Agricultural and Food Chemistry. 51:4504-4526.
Friedman, M., y Levin, C. 2008. Review of methods for the reduction of dietary content and toxicity of acrylamide. Journal of Agricultural and Food Chemistry. 56:6113-6140.
Gertz, C., Klostermann, S., Kochhar, P. 2003. Deep frying: the role of water from food being fried and acrylamide formation. Oléagineux, Corps Gras, Lipides. 10(4):297-303. Citado en: Masson, L., Muñoz, J. R., Romero, N., Camilo, C., Encina, C., Hernández, L., Castro, J. y Robert, P. 2007. Acrilamida en patatas fritas: revisión actualizada. Grasas y Aceites. 58(2):185-193.
Granda, C., Moreira, R. G. y Tichy, S. E. 2004. Reduction of acrylamide formation in potato crisps by low-temperature vacuum frying. Journal of Food Science. 69(8):405-411.
Hogervorst, J.G., Schouten, L.J., Konings, E.J., Goldbohm, A. y Van der Brandt, P. 2007. A prospective study on dietary acrylamide intake and the risk of endometrial, ovarian and breast cancer. Cancer Epidemiology, Biomarkers & Prevention. 16(11):2304-2313.
IARC. 1994. Acrylamide, IARC monographs on the evaluation of the carcinogenic risk of the chemicals to Humans. International Agency of Research on Cancer. 60. Citado en: El-Ziney, M. G., Al-Turki, A. A. y Tawfik, M. S. 2009. Acrylamide status in selected traditional Saudi foods and infant milk and foods with estimation of daily exposure. American Journal of Food Technology. 4(5):177-191.
Masson, L., Muñoz, J. R., Romero, N., Camilo, C., Encina, C., Hernández, L., Castro, J. y Robert, P. 2007. Acrilamida en patatas fritas: revisión actualizada. Grasas y Aceites. 58(2):185-193.
Mottram, D. S., Wedzicha, B. L. y Dodson, A. T. 2002. Acrylamide is formed in the Maillard reaction. Nature. 419:448-449. Citado en: Masson, L., Muñoz, J. R., Romero, N., Camilo, C., Encina, C., Hernández, L., Castro, J. y Robert, P. 2007. Acrilamida en patatas fritas: revisión actualizada. Grasas y Aceites. 58(2):185-193.
Mucci, L. A., Dickman, P. W., Steinek, G., Adami, H. O. y Augustsson, K. 2003. Dietary acrylamide and
cancer of the large bowel, kidney and bladder. Absence of an association in a population based study in Sweden. Journal of Cancer. 88:84-89. Citado en: Friedman, M. 2003. Chemistry, biochemistry, and safety of acrylamide. A review. Journal of Agricultural and Food Chemistry. 51:4504-4526.
Pelucchi, C., Galeone, C., Levi, F., Negri, E., Franceschi, S., Talamini, R., Bosetti, C., Giacosa, A. y La Vecchia, C. 2005. Dietary acrylamide and human cancer. International Journal of Cancer 118:467-471.
Rice, J. M. 2005. The carcinogenicity of acrylamide. Mutation Research. 580:3-20. Citado en Masson, L., Muñoz, J. R., Romero, N., Camilo, C., Encina, C., Hernández, L., Castro, J. y Robert, P. 2007. Acrilamida en patatas fritas: revisión actualizada. Grasas y Aceites. 58(2):185-193.
Romani, S., Bacchioca, M., Rocculi, P. y Rosa, M. 2008. Effect of frying time on acrylamide content and quality aspects of French fries. European Food Research and Technology. 226:555–560.
Sharma, A., Sharma, R. y Jain, J. 2008. Biochemical changes in the liver of Swiss albino mice orally exposed to acrylamide. Maejo International Journal of Science & Technology. 2(3):542-550.
Sorgel, F., Weissenbacher, R., Kinzig-Schippers, M., Hofmann, A., Illauer, M., Skott, A. y Landersdorfer, C. 2002. Acrylamide increased concentrations in homemade food and first evidence of its variable absorption from food, variable metabolism and placental and breast milk transfer In humans. Chemotherapy. 48:267-274. Citado en: Friedman, M. 2003. Chemistry, biochemistry, and safety of acrylamide. A review. Journal of Agricultural and Food Chemistry. 51:4504-4526.
Stadler, R. H., Blank, I., Varga, N., Robert, F., Hau, J., Guy, P. A., Robert, M. C. y Riediker, S. 2002. Acrylamide from Maillard reaction products. Nature. 419:449-450.
Surdyk, N. Rosén, J., Andersson, R. y Áman, P. 2004. Effects of asparagine, fructose and baking conditions on acrylamide content in yeast-leavened wheat bread. Journal of Agricultural and Food Chemistry. 52:2047-2051.
Taeymans, D., Wood, J., Ashby, P., Blank, I., Studer, A., Stadler, R., Gonde, P., Van Eijck, P., Lalljie, S., Lingnert, H., Lindblom, M., Matissek, R., Muller, D., Tallmadge, D., O´Brien, J., Thompson, S., Silvani, D. y Withmore, T. 2004. A Review of
acrylamide: an industry perspective on research, analysis, formation and control. Critical Reviews in Food Science and Nutrition. 44:323-347.
Tareke, E., Rydberg, P., Karlsson, P., Eriksson, S. y Tornqvist, M. 2002. Analysis of acrylamide, a carcinogen formed in heated foodstuffs. Journal of Agricultural and Food Chemistry. 50:4998-5006.
Tyl, R., y Crump, K. 2002. Acrylamide in food. Fd. Std. Agency. 5:215-222. Citado en: Sharma, A., Sharma, R. y Jain, J. 2008. Biochemical changes in the liver of Swiss albino mice orally exposed to acrylamide. Maejo International Journal of Science and Technology. 2(3):542-550.
WHO. 2002. Health implications of acrylamide in food. Report of a Joint FAO/WHO Consultation. Geneva, Suiza. Última consulta el 4 de noviembre de 2010.
4 – 2 (2010): 1-13
Disponible en: http://www.who.int/foodsafety/publications/chem/en /acrylamide_full.pdf
Wu, Y. Q., Yu, A. R., Tang, X. Y., Zhang, J y Cui, T. 1993. Determination of acrylamide metabolite, mercapturic acid by HPLC. Biomedical and Environmental Sciences. 6:273-280. Citado en: Friedman, M. 2003. Chemistry, biochemistry, and safety of acrylamide. A review. Journal of Agricultural and Food Chemistry. 51:4504-4526.
Zyzak, D. V., Sanders, R. A., Stoianovic, M., Tallmadge, D. H., Eberhart, B. L., Ewald, D. K., Gruber, D. C., Morsch, T. R., Strothers, M. A., Rizzi, G. P. y Villagran, M. D. 2003. Acrylamide formation mechanism in heated foods. A review. Journal of Agricultural and Food Chemistry. 51:4504-4526.

Temas Selectos de Ingeniería de Alimentos 4 – 2 (2010): 14-23

Hongos fitopatógenos de alta importancia económica: descripción y métodos de control
G. P. Juárez-Becerra*, M. E. Sosa-Morales y A. López-Malo
Departamento de Ingeniería Química, Alimentos y Ambiental, Fundación Universidad de las Américas Puebla. Sta. Catarina Mártir, Cholula, Puebla. C.P.72820. México.
Resumen
Las plantas sufren una serie de enfermedades y plagas durante su fase de crecimiento. Los hongos fitopatógenos no sólo manchan, desfiguran o causan la podredumbre de un número de frutos, sino también reducen su valor en el mercado. Las pérdidas económicas causadas por hongos fitopatógenos pueden ser altas. Los hongos, como Botrytis cinerea, Colletotrichum gloeosporioides y Penicillium spp, afectan a cultivos de alta importancia económica. anualmente, se aplican miles de toneladas de agroquímicos en todo el mundo, ante la necesidad de establecer un sistema de control. Esta revisión presenta información sobre algunos hongos fitopatógenos y las medidas de control que se han propuesto como alternativas al uso de pesticidas químicos y fungicidas, que ha sido cuestionado debido a los peligros de salud ambiental y humana.
Palabras clave: hongo, fitopatógenos, métodos de control.
Plants suffer a wide number of diseases and pest during their growth phase. Phytopathogenic fungi not only blemish, disfigure or cause rot to fruits, but also reduce their market value. Economic losses caused by phytopathogenic molds can be high. Fungi such as Botrytis cinerea, Colletotrichum gloeosporioides and Penicillium, affect every day to crops and annually lead to the implementation of thousands of tons of chemicals worldwide, before the need to establish a control system. This review shows information about some phytopathogenic fungi and the control system proposed as alternative to use of chemical pesticides and fungicides, which have been restricted due to environmental and human health hazards.
Keywords: fungi, phytopathogens, control methods.. párrafos antes =8 y después automático)
Introducción
*Programa de Maestría en Ciencia de Alimentos
Tel.: +52 222 229 2126, fax: +52 222 229 2727
Dirección electrónica: gladys.juarezba@udlap.mx
En la agricultura mundial los hongos fitopatógenos son causantes de enfermedades de pre y poscosecha en los cultivos de hortalizas, cereales y frutas, siendo éstos responsables de pérdidas económicas cuantiosas; el daño que ocasionan no sólo se refiere a las pérdidas de producción económica, sino también a las pérdidas en la producción biológica, es decir, a la alteración que existe en el crecimiento y desarrollo de las plantas hospedantes atacadas por estos microorganismos (Agrios, 2005).
Los patógenos más importantes que causan elevadas pérdidas de frutas y hortalizas son normalmente las bacterias y los hongos, sin embargo, con mayor frecuencia son especies de hongos las causantes del deterioro patológico de frutas, hojas, tallos y productos subterráneos (raíces, tubérculos, cormos, etc.). Algunas fuentes estiman que dichas pérdidas son del orden de 5-25% en países desarrollados y 20-50% en países en desarrollo (FHIA, 2007).
Una amplia gama de hongos han sido caracterizados como causantes del deterioro patológico en una variedad de productos, siendo los más comunes especies de Alternaria, Botrytis, Diplodia, Monilinia, Penicillium, Colletotrichum, Phomopsis, Fusarium, Rhizopus y Mucor (FHIA, 2007).
Las enfermedades de las plantas suelen ser una limitante en la producción de cualquier cultivo, por lo que un factor importante a considerar es su control (Investigación y Desarrollo, 2010). Existen diferentes métodos que pueden ser usados para el control de fitopatógenos, dentro de los que se pueden mencionar la aplicación de fungicidas químicos, tratamientos térmicos, aplicación de aceites esenciales entre otros.
Es por esto que la importancia de este trabajo radica en proporcionar información relevante de algunos hongos fitopatógenos que causan enfermedades en cultivos de alta importancia económica y dar a conocer los diferentes métodos de control que existen para erradicarlos.
causantes de enfermedades, antes o después de la cosecha y durante su almacenamiento; los hongos que causan estas enfermedades son denominados fitopatógenos (phyton: “planta”; pathos: “dolencia, enfermedad”) (Trigos et al., 2008; García, 2004).
Estos microorganismos constituyen un grupo de mucha importancia en la agricultura debido a su gran número y su enorme capacidad de reproducción, lo que con frecuencia dificulta su control. Estos hongos ocasionan grandes pérdidas económicas y aumentan, además, los costos de producción, al tener que establecer medidas para tratar de controlarlos (García, 2004). A nivel mundial los hongos fitopatógenos constituyen el grupo más importante desde el punto de vista económico en cuanto a su frecuencia de aparición y daño que pueden causar. El daño que ocasionan no sólo se refiere a las pérdidas de producción económica, sino también a las pérdidas en la producción biológica (FAO, 2004; Agrios, 2005).
Revisión bibliográfica
1. Hongos fitopatógenos
Las frutas son productos perecederos, susceptibles al ataque de microorganismos
Se considera que existen más de 8 000 especies de hongos que producen enfermedades en las plantas. La mayoría de las plantas pueden ser atacadas por algún tipo de hongo (por uno o varios) y también se sabe que un mismo hongo fitopatógeno puede infectar a uno o más tipos de plantas, aunque sean de diferentes familias. La mayor parte de los hongos fitopatógenos pasan la mayoría de su ciclo de vida en la planta que les sirve de huésped (como parásitos) y otra parte en el suelo, en los residuos vegetales que se encuentran ahí (como saprófitos), aunque algunos sólo se desarrollan como parásitos. Generalmente, los cuerpos reproductores del hongo se forman en la superficie de los tejidos de la planta huésped (o muy cerca de ella), lo cual causa que las esporas se dispersen rápida y fácilmente (García, 2004).
Los efectos que producen los hongos en las plantas pueden ser de tipo local, cuando
afectan una porción pequeña del tejido, o general, si causan un daño completo a toda la planta, lo cual depende del tipo de planta que parasiten. Sin embargo, en una misma planta pueden producir primero un efecto local y luego uno generalizado. El daño producido por los hongos es, principalmente, una muerte del tejido (necrosis) que infectan. También pueden producir atrofia de la planta completa o de algunas de sus partes y, en otros casos, pueden causar un crecimiento excesivo (hipertrofia). Además, los hongos que afectan la raíz, o bien el sistema vascular de la planta, tienden a producir color amarillo en la planta y marchitez (García, 2004).
Las manchas foliares, el tizón, la putrefacción de la raíz son algunos ejemplos de signos necróticos, mientras que los signos asociados con la hipertrofia de partes de las plantas pueden ser agallas de las raíces, verrugas o tumores. Todos los efectos mencionados pueden causar atrofia o disminución de la vitalidad de las plantas (o de los órganos infectados), lo que puede llevar a la muerte de la planta o a que ésta sea improductiva (García, 2004).
2. Especies de hongos fitopatógenos de importancia económica
2.1 Colletrotrichum gloeosporioides
C. gloeosporioides es un moho que forma conidios simples, aunque alargados y conidios hialinos, que son unicelulares, céreos, y generalmente de color oscuro (Fig. 1) (Jay, 1994).
Es una especie de interés en los alimentos, ya que produce la antracnosis (manchas pardas/negras) en muchos cultivos de importancia económica, como mangos y papayas (Jay, 1994), cítricos, guanábana, aguacate, café, cultivos ornamentales, entre otros (Silva et al., 2006). Entre las
Fig. 1. Crecimiento de Colletotrichum gloeosporioides en agar papa dextrosa.
enfermedades poscosecha del mango, la antracnosis es prevalente en las zonas húmedas y muy húmedas de crecimiento, la incidencia de esta enfermedad puede llegar a casi el 100% de las frutas bajo estas condiciones (Arauz, 2000).
La antracnosis de mango es una de las enfermedades más serias de este cultivo. El daño puede ocurrir en hojas, tallos y panículas florales, siendo el más el daño en los frutos (Holliday, 1995; Ploetz, 1999). Su efecto es limitante en la producción, debido a que ocasiona grandes pérdidas de frutos en el campo; durante la cosecha y poscosecha en algunos años ha afectado al 50% de la producción (Mendoza y Moreno, 2006).
En las hojas aparecen pequeñas manchas de color marrón, de forma circular o irregular, por lo general rodeadas por una zona más pálida que el tejido sano. Las manchas se ubican en los bordes o el ápice y pocas veces en la parte central del limbo de la hoja. Las lesiones se extienden y se unen unas con otras, formando grandes áreas, secas y oscuras, que luego se quiebran y caen. Los daños en las inflorescencias se manifiestan por pequeñas manchas oscuras que aparecen inicialmente en las flores. La invasión puede continuar en ejes, causar caída de flores y frutos o muerte parcial de la inflorescencia. Cuando están recién formados, los frutos toman una coloración
oscura, luego se momifican y caen. En frutos inmaduros, la enfermedad se expresa por medio de manchas de color pardo claro y de aspecto aceitoso, ubicadas en la zona aledaña al pedúnculo (Mendoza y Moreno, 2006).
Aunque la infección ocurre en etapas tempranas del crecimiento del fruto, las lesiones típicas de la antracnosis se hacen visibles con la maduración. En esta etapa se observan manchas circulares, hundidas y oscuras, con una superficie quebradiza. Cuando las lesiones crecen terminan uniéndose, formando una necrosis completa del fruto (Mendoza y Moreno, 2006).
La incidencia de la antracnosis se incrementa debido a prácticas inadecuadas, como la deficiente recolección de frutos afectados y el uso inadecuado de fungicidas. Para controlar la enfermedad se requiere conocer y entender la sintomatología y las características del agente causal (SosaMorales, 2009).
2.2 Botrytis cinerea
Es un moho que produce conidióforos largos, delgados y con frecuencia pigmentados. El micelio es septado; los conidios nacen en células apicales y son de color gris, aunque pueden ser negros; a veces producen esclerocios irregulares (Fig.2) (Jay, 1994).
B. cinerea es una especie importante en los frutos, se desarrolla mejor en clima fresco y húmedo, y puede ser devastador si en clima lluvioso coincide con la cosecha cuando la fruta está madura y muy susceptible. Este microorganismo es el agente causal de la podredumbre gris en manzanas, peras, frambuesas, fresas, uvas y limones (Jay, 1994), además de toronjas y frutos con hueso (Zhang et al., 2010; Guerra y Born, 2007). En la Fig. 3 puede observarse la propagación de Botrytis cinerea en fresas en dos diferentes etapas de la enfermedad.


B. cinerea se considera como uno de los causantes de las enfermedades más importantes de las uvas de mesa (He et al., 2010). Produce lesiones marrones y aparece un moho gris sobre las hojas, capullos y flores. También puede causar la muerte de plantas jóvenes y tiernas por putrefacción acuosa de la base de los tallos e infectada por heridas. Posee la capacidad de degradar la epidermis e ingresar a un fruto vecino desde un fruto podrido, generando una nueva podredumbre. Es así como se producen los denominados "nidos", donde se observan varios frutos cercanos afectados por el hongo. No obstante, la afección se inicia desde un primer fruto en el cual la espora ingresa por una herida (Di Masi y Colodner, 2010). La enfermedad causada por el moho gris Botrytis cinerea es una de las más graves de una amplia gama de cultivos de importancia en todo el mundo (Deferera et al., 2003).
Fig. 2. Crecimiento de Botrytis cinerea en agar papa dextrosa.
Fig. 3. Fresa contaminada con Botrytis cinerea en dos diferentes etapas de la enfermedad: (a) temprana y (b) avanzada (UC Davis, 2005)
2.3 Penicillium
Este género se caracteriza por formar conidios en una estructura ramificada semejante a un pincel que termina en células conidiógenas llamadas fiálides; sus colores típicos varían de azul a azul–verde (Fig. 4) (Jay, 1994).

Algunas especies producen la podredumbre azul y verde por mohos de los frutos cítricos y la podredumbre azul por mohos de las manzanas, uvas, peras y frutas con hueso. El Penicillium es un género grande encontrado casi por todas partes, siendo comúnmente el género de hongos más abundante en suelos. La fácil proliferación de los Penicillium en los alimentos es un problema. Algunas especies producen toxinas y pueden hacer el alimento no comestible o aún peligroso A escala mundial, Penicillium es una de las causas más importantes de podredumbre en cítricos (Jay, 1994; Smith et al., 1998).
Penicillium digitatum provoca la enfermedad conocida como moho verde de los cítricos, causa podredumbre blanda. El primer síntoma es una mancha redonda sobre la superficie del fruto; si la temperatura es la favorable, la lesión crece rápidamente y cubre con un moho blanco que pronto se hace verde oliva al producir esporas. Las esporas de P. digitatum pueden sobrevivir en el suelo y en naves de empaquetamiento o de almacén
durante periodos largos; las corrientes de aire las transportan hasta los frutos. Las esporas no germinan en la superficie del fruto hasta que la piel tiene daños. La humedad elevada favorece el crecimiento de este microorganismo en los frutos (Smith et al., 1998).
Penicillium italicum es un patógeno de los cítricos; causa la enfermedad del moho azul y produce podredumbre blanda como el moho verde. El área productora de esporas en la superficie del fruto en descomposición tiene un color azul brillante y está rodeada por micelio blanco. El hongo penetra en el fruto a través de heridas, pero también puede extenderse desde los frutos infectados a los sanos por contacto (Smith et al., 1998).
3. Métodos de control
El control de enfermedades, requiere de la utilización de diversos métodos o técnicas.
3.1 Aplicación de fungicidas químicos
Los fungicidas son productos químicos utilizados para eliminar o evitar el desarrollo de los hongos que atacan a los cultivos; son empleados ampliamente en la agricultura (Hamlen y Power, 1998; Mora, 2009).
Pueden ser un componente fundamental del programa de manejo de una enfermedad. Sin embargo, es importante recordar que su uso debe ser integrado con las buenas prácticas culturales, el conocimiento del patógeno, la biología de la enfermedad y la resistencia a las enfermedades. Siempre que sea posible, es importante recordar que los fungicidas sólo son eficaces si se siguen algunas reglas:
Seleccionar el material apropiado: esto depende de un correcto diagnóstico y de la identificación del patógeno.
Aplicar el fungicida en el momento adecuado del año y con la frecuencia
Fig. 4. Crecimiento de Penicillium spp. en agar papa dextrosa.
suficiente para proteger debidamente el material vegetal.
Aplicar el fungicida correctamente sobre las superficies de las plantas (Nameth y Chatfield, 2010).
Durante muchos años, una variedad de diferentes productos químicos sintéticos ha sido ampliamente utilizada para inhibir el crecimiento de hongos patógenos de plantas. En la actualidad existen más de 113 ingredientes activos registrados como fungicidas comerciales en todo el mundo. Sin embargo, hay una serie de problemas contra el uso eficaz de estos productos químicos en las zonas donde los hongos han desarrollado resistencia (Bajpai y Kang, 2010). Por otro lado, existe una preocupación internacional por erradicar el uso de fungicidas químicos a nivel mundial. El dibromuro de etileno fue el primer fumigante empleado, pero en 1984 fue reconocido como carcinogénico y su uso fue prohibido (USDHHS, 1992). Después, la fumigación con bromuro de metilo fue usada extensamente (Moffit et al., 1992), por ejemplo, en plantas madre para el cultivo de fresas contra Botrytis cinerea. Sin embargo, este compuesto fue identificado como un agente que provoca alto deterioro de la capa de ozono (UNEP, 1995). Así, la Agencia de Protección al Ambiente (EPA) de los Estados Unidos comenzó a establecer restricciones sobre el uso de fumigantes químicos (USEPA, 2001) y se ha generado un gran interés por desarrollar tratamientos poscosecha alternativos a la fumigación (Yahia, 2006; Wang et al., 2007). Los tratamientos alternativos deben ser técnicamente efectivos, no dañar el medio ambiente y ser económicamente factibles (Hansen y Johnson, 2007).
3.2 Tratamientos térmicos
Con el fin de reducir la dependencia del uso de compuestos químicos, se están desarrollando métodos alternativos para prevenir y controlar
el crecimiento de hongos fitopatógenos. Los tratamientos de desinfección con calor se han propuesto como una posibilidad, debido a que son relativamente fáciles de aplicar, no dejan residuos químicos y suelen ser eficaces en el control de hongos (Sosa-Morales et al., 2009b). A menudo se aplican tratamientos térmicos previos al almacenamiento, para evitar la descomposición durante este periodo y el de comercialización.
Los tratamientos térmicos contra los patógenos se aplican a frutas recién cosechadas durante tiempos relativamente cortos (minutos), ya que los hongos causantes del deterioro se encuentran en la superficie o en las capas celulares que están directamente bajo la piel de los productos frescos. Las formas de aplicación son varias: tratamientos con vapor, con aire caliente y hidrotérmicos (inmersión de los frutos en agua caliente por corto tiempo) (Tang et al., 2007).
Diversos tratamientos con calor han sido estudiados para el control de hongos. PérezCarrillo y Yahia (2004) encontraron como efectivos los tratamientos con aire (con 50% de humedad relativa) a 48.5ºC durante 4h, combinados con tiabendazol, contra el crecimiento de C. gloeosporioides inoculado en papaya ‘Maradol’. Waskar y Gaikwad (2005) reportó que la antracnosis fue controlada en mangos ‘Kesar’ usando un tratamiento con agua (52ºC durante 10 min), combinado con el fungicida bavistin al 0.1%. En el mismo trabajo se encontraron otros tratamientos efectivos contra C. gloeosporioides Penz, como tratamiento en agua a 55ºC, vapor, y la combinación de vapor y agua a 38ºC durante 5 min.
Villa-Rojas (2010) determinó la cinética de muerte de B. cinerea a diferentes temperaturas (42, 44, 46 y 48°C) en un medio modelo y en puré de fresa esterilizado. La determinación de muerte microbiana para B cinerea se hizo por medio de un análisis de tiempo de muerte
térmico o TDT (Thermal Death Time) que consiste en calentar una cantidad de microorganismos conocida en una solución a diferentes temperaturas y varios intervalos de tiempo para cada temperatura, de tal manera que se pueda obtener una curva de cinética de muerte microbiana de la cual se puedan derivar los parámetros D y z; para ello se utilizaron celdas TDT (thermal death time en su siglas en inglés), las cuales se llenaron con 100µL de inoculo y 900µL de SMF o FE, para dar una población inicial de 104 a 105 esporas/mL. El tratamiento térmico fue efectivo para la inactivación del hongo, incrementando la muerte con el aumento en la temperatura. Por ejemplo, se requirieron 40 min a 42°C para reducir en 2 ciclos-log la población del hongo, mientras que bastaron menos de 5 min para disminuir la población en 4 ciclos-log a 48°C.
El calentamiento con microondas también ha sido explorado como tratamiento térmico contra hongos. Sosa-Morales et al. (2009a) aplicaron diferentes tiempos de exposición a varias potencias en muestras de C. gloeosporioides en sistemas modelo. Los tratamientos duraron sólo 3-9 s para inhibir completamente al hongo crecido en agar papa dextrosa y tomaron hasta 4 min para lograr la muerte del Colletotrichum cuando estaba fijo en medio seco (papel filtro).
Los productos básicos agrícolas varían mucho en tamaño y forma y, por tanto, responden de manera diferente al tratamiento térmico aplicado. Un tratamiento inadecuado puede provocar la aceleración de la maduración o el daño por calor (Tang et al., 2007).
3.3 Aplicación de aceites esenciales
Los aceites esenciales son sustancias odoríferas de naturaleza oleosa encontradas prácticamente en todos los vegetales; son muy numerosos y están ampliamente distribuidos
en distintas partes del mismo vegetal: en las raíces, tallos, hojas, flores y frutos. Son mezclas de componentes heterogéneos de terpenos, sesquiterpenos, ácidos, ésteres, fenoles, lactonas (Vásquez et al., 2001; Arya y Perelló, 2010).
En la actualidad, los productos naturales gozan de amplia aceptación y reemplazan cada vez más a los productos sintéticos o materiales generados artificialmente. Como respuesta a esta tendencia, se ha producido un creciente interés en la investigación de la posible utilización de aceites esenciales y los extractos de plantas como fungicidas naturales, que sean relativamente menos perjudiciales para el medio ambiente (Benites et al., 2009; Bajpai y Kang, 2010). Por ello, en los últimos años su uso como bactericidas y fungicidas ha cobrado mayor importancia (Martínez, 2003; GamboaAlbarado et al., 2002).
El uso de productos vegetales, como los aceites esenciales, se necesita con urgencia, para reducir el uso de fungicidas sintéticos (De Corato et al., 2010).
Se pueden citar numerosos estudios de la evaluación antimicrobiana in vitro de aceites esenciales. Como ejemplo se tiene el trabajo desarrollado por García-Camarillo et al. (2006), en el cual se demostró la capacidad antifúngica de los aceites esenciales de canela y orégano sobre Aspergillius flavus. En el estudio realizado por Deferera et al. (2003) determinaron la eficacia de los aceites esenciales de orégano, tomillo, mejorana, lavanda, romero, salvia, y poleo sobre el crecimiento de Botrytis cinerea, Fusarium sp., Fusarium solani y Clavibacter.
Palhano et al. (2004) combinaron la aplicación de alta presión hidrostática con la adición de aceite esencial de citral y hoja de limón contra C. gloeosporioides. Las esporas de C. gloeosporioides fueron inhibidas de manera eficiente después de un tratamiento a
una presión de 350 MPa durante 30 min, así como a una presión de 150 MPa con una adición de 0.75 mg/mL de aceite esencial de citral. Bosquez-Molina et al. (2010) usaron aceites esenciales de tomillo y limón mexicano contra C. gloeosporioides en papaya, encontrando que es posible reducir la incidencia de la enfermedad en un 100% con aceite esencial de tomillo y limón mexicano a concentraciones de 0.1% y 0.5%.
De Corato et al. (2010) usaron el aceite esencial de laurel a concentraciones de 200, 400, 600, 800 y 1000 mg/mL en sistemas in vitro para la inactivación de Botrytis cinerea y Penicillium digitatum. P. digitatum fue parcialmente inhibida en todos los rangos de concentración, mientras que B. cinerea se inhibió completamente a la mayor concentración. Para ambos hongos se observó una acción fungistática.
Dado que se ha demostrado que los aceites esenciales funcionan como antimicrobianos para distintos microorganismos, es posible que resulten adecuados para inhibir el crecimiento de hongos fitopatógenos presentes en cultivos de alta importancia económica.
económicos causados por los hongos fitopatógenos establecen una necesidad persistente de desarrollar nuevos fungicidas más eficaces y amigables con el medio ambiente (como los basados en aceites esenciales), por lo que la búsqueda y desarrollo de nuevos métodos de control para los hongos fitopatógenos sigue siendo un tema actual y necesario.
Conclusiones
Los hongos fitopatógenos siguen siendo la causa de graves epidemias, pérdida total de rendimiento de los cultivos y elevadas pérdidas económicas, las cuales afectan día con día a los cultivos y, anualmente, conducen a la aplicación de miles de toneladas de agroquímicos en todo el mundo, ante la necesidad de establecer un sistema de control.
El control de hongos fitopatógenos es de gran importancia económica, ya que el crecimiento fúngico sobre las plantas reduce la cantidad y la calidad globales durante y después de la cosecha. Los continuos efectos
Agradecimientos
A la Universidad de las Américas Puebla y al Consejo Nacional de Ciencia y Tecnología (CONACyT, México) por el financiamiento recibido para la realización de este trabajo.
Referencias
Agrios, G. N. 2005. Plant Pathology. Quinta edición. Academic Press. Nueva York. 803 p
Arauz, L. F. 2000. Mango anthracnose: Economic impact and current options for integrated management. Plant Disease. 84(6):600-612.
Arya, A. y Perelló, A. E. 2010. Management of Fungal Plant Pathogens. India. 375 p.
Bajpai, V. K. y Kang, S. C. 2010. Antifungal Activity of Leaf Essential Oil and Extracts of Metasequoia glyptostroboides Miki ex Hu. Journal of the American Oil Chemists' Society. 87:327–336.
Benites, N. P., Melendez, E. y Stashenco, E. E. 2009. Composición química y actividad antibacteriana del aceite esencial de hojas de Piper lanceaefolium, planta usada tradicionalmente en Colombia. Boletín Latinoamericano y del Caribe de Plantas Medicinales y Aromática. 8(4):301–304.
Bosquez-Molina, E., Ronquillo-de Jesús, E., BautistaBaños, S., Verde-Calbo J. R. y Morales-López, J. 2010. Inhibitory effect of essential oils against Colletotrichum gloeosporioides and Rhizopus stolonifer in stored papaya fruit and their possible application in coatings. Postharvest Biology and Technology. 57:132–137.
De Corato, U., Maccioni, O., Trupo, M. y Sanso, G. 2010. Use of essential oil of Laurus nobilis obtained by means of a supercritical carbon dioxide technique against post harvest spoilage fungi. Journal of the American Oil Chemists' Society. 87:201–207.
Deferera, D. J., Ziogas, B. N. y Polissiou, M. G. 2003. The effectiveness of plant essential oils on the growth of Botrytis cinerea, Fusarium sp. and Clavibacter michiganensis Crop Protection. 22:39–44.
Di Masi, S. y Colodner, A. 2010. Control de enfermedades patológicas en frutas de pepita en poscosecha http://www.inta.gov.ar/altovalle/info/biblo/rompecab ezas/pdfs/fyd51_enferm.pdf, Accesada 25/09/10.
FAO, 2004. Manejo integrado de enfermedades en cultivos hidropónicos http://www.rlc.fao.org/es/agricultura/aup/pdf/integra 1.pdf, Accesada 02/11/10.
Fernández, R. B. 2006. Aislamiento y caracterización del tilirósido a partir de las semillas de Heliocarpus terebinthinaceus (Cuetla). Tesis de Licenciatura. Universidad Tecnológica de Huajuapan de León, Oaxaca. México.
FHIA, 2007. Deterioro poscosecha de las frutas y hortalizas frescas por hongos y bacterias. 4:25.http://fhia.org.hn/dowloads/fhiainfdic2007.pdf, Accesada 02/11/10.
Gamboa-Albarado, R., Hernández-Castillo, F. D. Guerrero-Rodríguez, E., Sánchez-Arizpe, A. y LiraSaldivar R. 2002. Inhibición del crecimiento micelial de Rizhoctonia solani Kuhn Phytophthora infestants Mont. (De Bary) con extractos vegetales metanólicos de hojasén (fluerencia cernua D.C), mejorana (Onigarum mejorana L.) y trompetilla. Revista Mexicana de Fitopatología. 21:13-18.
García, C. V. 2004. Introducción a la Microbiología Segunda Edición. Editorial EUNED. Costa Rica. pp 103-107.
García-Camarillo, E. A., Quezada-Viay, M. Y., Moreno-Lara, J., Sánchez-Hernández, G., MorenoMartínez, E. y Pérez-Reyes, M. C. J. 2006. Actividad antifúngica de aceite esencial de canela (Cinnamomun zeylanicum Blume) y orégano (Origanum vulgare L.) y su efecto sobre la producción de aflatoxinas en nuez pecarena. Revista Mexicana de Fitopatología. 24(001):8-12.
Guerra, M., y Born, H. 2007. Fresas: producción orgánica. Centro Nacional de Tecnología Apropiada. pp 1-32.
4 – 2 (2010): 14-23
www.attra.ncat.org/espanol/pdf/fresas.pdf, Accesada 21/09/10.
Hamlen, R. A. y Power, R. J. 1998. Distribution of sensitivity responses to cymoxanil within global populations of Phytophthora infestans. Pesticide Science. 53, 101-103.
Hansen, J. D. y Johnson, J. A. 2007. Introducción. En: Tang, J., Mitcham, E., Wang, S. y Lurie S (Eds). Heat Treatments for Postharvest Pest Control CABI, Wallingford, Reino Unido. 349 p.
He, L., Liu, Y., Musthapa, A. y Lin, M. 2010. Antifungal activityofzincoxidenanoparticles against Botrytis cinerea and Penicillium expansum. Science Direct. 03 (003): 1-9.
Holliday, P. 1995. Fungus diseases of tropical crops: Glomerella cingulata. Nueva York, US, Dover Publications. 607pp.
Investigación y Desarrollo, 2010.Hongos entomopatógenos y su uso como plagicidas. http://www.invdes.com.mx/index.php?option=com_ content&view=article&id=914:hongosentomopatogenos-y-su-uso-comoplaguicidas&catid=52:noticias&Itemid=272. Accesada 07/09/10.
Jay, J. 1994. Microbiología Moderna de los Alimentos. Acribía. Zaragoza, España.
Martínez, J., Sulbarán de Ferrer, B., Ojeda de Rodríguez G., Ferrel, A. y Naval, R. 2003 Actividad antibacteriana del aceite esencial de mandarina. Revista de la Facultad de Agronomía. 20: 502-512.
Mendoza, C. C. B., y Moreno, V. M. N. 2006. Evaluación del efecto de extractos vegetales sobre el crecimiento in vitro de Phytophthora palmivora y Colletotrichum gloeosporioides. Tesis de Licenciatura. Universidad Earth. Costa Rica.
Moffit, H. R, Drake, S. R., Toba, H. H. y Hartsell, P. L. 1992. Comparative efficacy of methyl bromide against codling moth (Lepidoptera: Tortricidae) larvae in ‘Bing’ and ‘Rainier’cherries and confirmation of efficacy of a quarantine treatment for ‘Rainier’ cherries. Journal of Economic Entomology. 85:1855–1858.
Mora, J. 2009. 38 exposición nacional de orquídeas. Asociación Costarricense de Orquideología. 1-12 pp.
Nameth, S., y Chatfield, J. 2010. Using Fungicide Sprays Effectively. Universidad de Ohio. http://ohioline.osu.edu/hyg-fact/3000/pdf/3038.pdf, Accesada 25/09/10.
G. P. Juárez-Becerra et al. / Temas
Palhano, F. L., Vilches, T. T. B., Santos, R. B., Orlando, M. T. D., Ventura, J. A. y Fernandes, P. M. B. 2004. Inactivation of Colletotrichum gloeosporioides spores by high hydrostatic pressure combined with citral or lemongrass essential oil. International Journal of Food Microbiology. 95:61– 66.
Pérez-Carrillo, E. y Yahia E. M. 2004. Effect of postharvest hot air and fungicide treatments on the quality of ‘Maradol’ papaya (Carica papaya L.). J. Food Quality 27: 127-139.
Ploetz, R. 1999. Anthracnose: the most important disease in much of the mangoproducing world. PLP News 3(9):1-6.
Silva, K. S.; Rebouças, T. N. H.; Lemos, O. L.; Bomfim, M. P.; Bomfin, A. A.; Esquivel, G. L.; Barreto, A. P. P.; José, A. R. S.; Dias, N. O. y Tavares, G. M. 2006. Patogenicidad causada pelo fungo Colletotrichum gloeosporioides (Penz) em diferentes espécies frutíferas. Revista Brasileira de Fruticultura. 28(1):131-133. http://www.scielo.br/pdf/rbf/v28n1/29710.pdf, Accesada 19/05/10.
Smith, I. M., Dunez, J., Lelliott, R. A., Phillips, D. H. y Archer, S.A. 1998. Manual de Enfermedades de las Plantas. GRAFO. Bilbao, España. 667 Pp.
Sosa-Morales, M. E. 2009. Aplicación de radio frecuencia y microondas sobre Colletotrichum gloeosporioides, sobre huevos y larvas de Anastrepha obliqua, y sobre las propiedades físicas de mango (Mangifera indica L.). Tesis de Doctorado. Instituto Tecnológico de Veracruz. Veracruz, Ver., México.
Sosa-Morales, M. E., Tiwari, G., Wang, C., Tang, J., García, H. S y Lopez-Malo A. 2009a. Dielectric heating as a potential post-harvest treatment of disinfesting mangoes, Part II: Development of RFbased protocols and quality evaluation of treated fruits. Biosystems Engineering. 103, 287–296.
Sosa-Morales, M. E., García, H. S. y López-Malo, A. 2009b. Colletotrichum gloeosporioides growth/no growth interface after selected microwave treatments. Journal of Food Protection. 72(7):14271433.
Tang, J., Mitcham, E., Wang, S. y Lurie, S. 2007. Heat Treatments for Postharvest Pest Control. CABI, Wallingford, Reino Unido. 349 p.
Trigos, A. Ramírez, K y Salinas, A. 2008. Presencia de hongos fitopatógenos en frutas y hortalizas y su
de
4 – 2 (2010): 14-23
relación en la seguridad alimentaria. Revista Mexicana de Micología. 28:125- 129.
U.S. Environmental Protection Agency (USEPA). 2001. Protection of stratospheric ozone: process for exempting quarantine and preshipment applications of methyl bromide. Rules and Regulations. Federal Register. 66(139):37752–37769.
UC Davis. Universidad de California en Davis 2005. Guía para el manejo de las plagas: Fresas. http://cesantacruz.ucdavis.edu/files/41844.pdf, Accesada 26/08/2008.
U.S. Department of Health and Human Services (USDHHS). 1992. Agency for Toxic Substances and Disease Registry (ATSDR). Toxicological Profile for 1,2-Dibromoethane. Public Health Service, Atlanta, GA.
United Nations Environmental Program (UNEP). 1995. Montreal Protocol on Substances that Deplete the Ozone Layer. Report of methyl bromide technical options committee: Assessment, Ozone Secretariat, Nairobi, Kenya.
Vásquez, R. O. Alva, A. Marreros, V. J. 2001. Extracción y caracterización del aceite esencial de jengibre (Zingiber officinale). Revista Amazónica de Investigación. 1(1):38.
Villa-Rojas, R. 2010. Desarrollo y evaluación de tratamientos con microondas de fresas y cinética de muerte microbiana de Botrytis cinerea. Tesis de Maestría. Universidad de las Américas Puebla. México.
Wang, S., Monzon, M., Johnson, J. A., Mitcham, E. J. y Tang, J. 2007. Industrial-scale radio frequency treatments for insect control in walnuts: I. Heating uniformity and energy efficiency. Postharvest Biology and Technology. 45(2):240–246.
Waskar D. P. y Gaikwad R. S. 2005. Postharvest hot water treatment for disease control in Kesar mango fruits. Indian Journal of Agricultural Research, 39(3):722-725.
Yahia, E. M. 2006. Effects of insect quarantine treatments on the quality of horticultural crops. Stewart Postharvest Review. 1:6.
Zhang, D., Spadaro D., Garibaldi A. y Gullino, M.L. 2010. Efficacy of the antagonist Aureobasidium pullulans PL5 against postharvest pathogens of peach, apple and plum and its modes of action. Biological Control. 103:279–285.

Temas Selectos de Ingeniería de Alimentos 4 – 2 (2010): 24-37

Estructura y funcionalidad de proteínas lácteas: Efecto de modificaciones inducidas por medios físicos, químicos y enzimáticos
K.
Zimmermann - Stein* y H. Ruiz - Espinoza
Departamento de Ingeniería Química, Alimentos y Ambiental, Universidad de las Américas Puebla. Sta. Catarina Mártir, Cholula, Puebla. C.P.72820. México.
Resumen
El objetivo de este trabajo fue el de estudiar los métodos más importantes de desnaturalización de las proteínas lácteas. Estos métodos cambian las propiedades de la leche, tales como solubilidad, emulsificación y coagulación, todas éstas pueden ser iniciadas por varias acciones y agentes. Dentro de los métodos estudiados se encuentran las altas presiones (hidrostáticas y de homogenización), cambios en el pH, etanol, renina y otras enzimas proteolíticas, entre otros. Las principales proteínas lácteas que son afectadas, dada su complejidad, son las caseínas. En general, los agentes de naturaleza química y enzimática ocasionan la coagulación y precipitación de éstas, permaneciendo las suero-proteínas en solución acuosa (por ejemplo el queso). Por el contrario, los agentes de naturaleza física, ocasionan la formación de agregados, un decremento en el tamaño de la micela y una re-configuración interna de éstas.
Palabras clave: proteínas lácteas, caseína, desnaturalización, agregación.
Abstract
The objective of this document was to study the most important methods of milk protein denaturation. These methods change milk properties, such as solubility, emulsification and coagulation, these all can be initiated by a number of different actions or agents. Within the agents studied are high pressures (hydrostatic and homogenization), changes in pH, ethanol, salts, rennets and other proteolytic enzymes and other non-less important agents. The main affected milk protein, because of its complexity, are caseins. In general, agents of chemical and enzymatic nature cause the coagulation and precipitation of these, remaining the whey protein in aqueous solution (e.g. cheese). Otherwise, agents of physical nature, cause the formation of aggregates, a decrease in micelle size and the internal reconfiguration of these.
Keywords: milk proteins, casein, denaturation, aggregation.
Introducción
*Programa de Maestría en Ciencia de Alimentos
Tel.: +52 222 229 2126, fax: +52 222 229 2727
Dirección electrónica: karin.zimmermannsn@udlap.mx
Las proteínas son macromoléculas conformadas por aminoácidos unidos mediante enlaces peptídicos. Sus propiedades nutritivas, características físicoquímicas y propiedades funcionales dependen directamente del tipo, concentración y secuencia de unión de los monómeros que las constituyen; a esta secuencia se le conoce como estructura primaria. Dependiendo del arreglo espacial que adquieren por interacciones entre aminoácidos adyacentes o
lejanos en su secuencia lineal, las proteínas pueden poseer estructuras secundarias o terciarias, respectivamente. Algunas de las estructuras secundarias más comunes son αhélice y β-laminar.
Las proteínas presentan cambios en su estructura al someterse a diferentes estímulos externos tales como tratamiento térmico, cambios en el pH por adición de ácidos o bases, procesamiento a alta presión hidroestática o dinámica, entre otros. Dependiendo de su complejidad, las proteínas pueden sufrir un desdoblamiento al que se le conoce como desnaturalización; las proteínas desnaturalizadas a su vez, pueden formar agregados con otras proteínas reactivas superficialmente (Walstra et al., 2006).
Las proteínas lácteas son quizá el grupo proteico alimenticio más estudiado. La leche está conformada principalmente por tres estructuras biológicas: dos en estado coloidal (proteínas, glóbulos de grasa) y una en solución (lactosa). Entre el grupo de proteínas lácteas se distinguen dos clases: las caseínas, fosfoproteínas organizadas en forma de conglomerados coloidales denominados micelas, estables al calor e insolubles a pH 4.6; y las proteínas séricas, con una estructura globular compleja, que precipitan a pH 4.6 y son inestables al calor.
Las proteínas juegan un papel importante en la formación de estructuras en productos lácteos como el queso y el yogurt, así como en la estabilización de los glóbulos de grasa en los productos homogenizados. Cuando estas proteínas se desnaturalizan, particularmente las séricas, tienen la habilidad de producir geles ácidos con buenas propiedades de textura (Guyumarc’ et al., 2007).
Considerando esto, se han buscado formas de mejorar las características de las lactoproteínas; tales modificaciones pueden ser de naturaleza física (Van Hekken y Holsinger, 2000; Kim et al., 2008), química (Adams et
al., 2008) y/o enzimática (Smiddy et al., 2006; Czernicka et al., 2009).
El objetivo de este trabajo es presentar un panorama general de las posibles modificaciones inducidas a las proteínas de leche, con énfasis en los estímulos externos relevantes para el procesamiento de productos lácteos. Revisión bibliográfica
1. Generalidades de las proteínas lácteas
Las caseínas son fosfoproteínas que se presentan como conglomerados coloidales dentro de la leche y confieren a la leche su opalescencia característica (Huppertz, 2009). La principal función de las micelas es la de fluidificar a las caseínas así como la de solubilizar el fosfato cálcico. Se reconocen 4 tipos de caseína: αs1-, αs2-, β- y κ-caseína, todas ellas se encuentran fosforiladas en residuos específicos de serina; así mismo, poseen cantidades importantes de prolina, lo cual limita la cantidad de la estructura terciaria que pueden exhibir. Presentan un marcado carácter aniónico en un medio neutro por la presencia de radicales fosfoserina y/o ácido glutámico. Las primeras tres precipitan en presencia de calcio por disminución de su carga eléctrica negativa y su hidrofilia, sin embargo la κ-caseína no sólo es soluble en calcio, sino que también interactúa y estabiliza a las caseínas insolubles en calcio formando un estado coloidal estable dentro de la leche. A los 4 tipos de caseína principales, se les pueden añadir otros grupos de proteínas minoritarias como la γ- caseína y la λ- caseína. La primera es un fragmento procedente de la proteólisis de la β- caseína y la segunda es derivada de la αs1– caseína. Todos los tipos de caseína, tanto las mayoritarias como las minoritarias, se encuentran en todos los tipos de leche de mamíferos estudiadas hasta hoy en
día, aunque en diferentes cantidades y proporciones.
Debido a su papel determinante en la estructura y funcionalidad de los productos lácteos, la conformación de las micelas de caseína ha sido abordada por varios autores desde principios del siglo pasado. La mayoría de los modelos propuestos para la micelas de caseína se clasifican en tres categorías: de núcleo y corteza (Mirsky y Pauling, 1936; Farrell, 1988; de Kruif, 2003; Dalgleish et al., 2004), de subunidades (McMahon y Brown, 1983; Dalgleish, 1992; Famelart et al., 1996; Van Hekken y Holsinger, 2000; Panouillé et al., 2004) y de estructura interna (Dalgleish el al., 2004; Farrell et al., 2006; Smiddy et al., 2006; Bouchoux et al., 2009). Sin embargo, a pesar de la gran cantidad de investigaciones que se han hecho para conocer su estructura a detalle, ésta aún no es conocida ni comprendida con exactitud (Considine et al., 2007). Actualmente, se sabe con certeza que las αs-caseína (αs1- y αs2- caseína) se encuentran en el núcleo de la micela mientras que la mayoría de los modelos estructurales localizan a la κ-caseína en la superficie de la micela por lo que juega un papel esencial en la regulación del tamaño micelar así como en el mantenimiento de la suspensión de las demás caseínas en la leche (Farrell et al., 2006; Ferrandini et al., 2006). La β-caseína se encuentra en el centro de la micela nativa bajo condiciones nativas (pH 6.6 - 6.7; temperatura ambiente), pero puede migrar a la superficie o hacia la fase sérica cuando la micela se encuentra en un ambiente no nativo, como por ejemplo a 10°C (Considine et al., 2007). Toda la micela se encuentra estabilizada por nanoaglomerados de fosfato de calcio, también denominado fosfato de calcio coloidal (Walstra et al., 2006). Un aspecto en común que presentan los últimos modelos desarrollados, es la característica de presentar una capa de finas vellosidades en la superficie de la micela. Esta capa crea un impedimento estérico contra la agregación. Esta
característica es la llave para las actuales discusiones de las formas de coagulación de la leche (IDF, 2007).
Por su parte las proteínas séricas son un grupo heterogéneo, conformado por βlactoglobulina, α- lactoalbúmina, albúmina bovina sérica, diversos tipos de inmunoglobulinas y proteínas minoritarias, algunas con importantes funciones biológicas, como la lactoferrina. La β- lactoglobulina y la α-lactalbúmina son las mayoritarias (60% y 20% en proporción másica, respectivamente) y poseen concentraciones apreciables de residuos de cisteína. En el caso particular de βlactoglobulina, los aminoácidos sulfurados quedan expuestos al desnaturalizarse la proteína, posibilitando la interacción de grupos sulfhidrilo con caseína, particularmente del tipo kappa (Fox y McSweeney, 1998).
2. Modificaciones estructurales en proteínas lácteas
Cuando las proteínas de leche se someten a diferentes estímulos externos, ya sean de naturaleza física, química, biológica o mixta, pueden sufrir modificaciones diversas, frecuentemente relacionadas con la pérdida de estabilidad estérica y/o electrostática de las micelas de caseína, a la desnaturalización de las proteínas séricas y a las interacciones entre ambas. Bajo condiciones selectas esto puede conducir a la agregación proteica (IDF, 2007). A continuación se describen los principales cambios inducidos por medios físicos, químicos y enzimáticos, con énfasis en los estímulos externos relevantes para el procesamiento de productos lácteos.
2.1. Medios físicos
2.1.1. Altas temperaturas
Singh y Waungana (2001) resumieron los principales cambios que sufre la leche al someterse a un tratamiento térmico y que
pueden afectar o beneficiar a la estabilidad estructural de las proteínas. Dentro de la primera categoría se encuentran: disminución de pH, depositación de fosfato de calcio sobre la superficie micelar, asociación de proteínas de suero con micelas, desfosforilación de caseína, disociación de κ-caseína, reducción del potencial zeta proteico y formación de enlaces covalentes. Por su parte, la estabilidad proteica se puede ver favorecida por la reducción en la actividad del ión calcio, reducción de la sensibilidad micelar a los iones calcio y la formación de algunos productos de degradación térmica de lactosa.
El tratamiento térmico de la leche (8595°C durante varios minutos) es tradicionalmente aplicado en la elaboración de yogurt y otras leches fermentadas, en las cuales la producción de ácido láctico es deseable desde un principio con la finalidad de obtener una textura firme así como una alta retención de suero (Guyomarc’ et al., 2007). Los cambios en sus partículas dependen de la temperatura y de la duración del tratamiento térmico, así como cambios pequeños en el pH de la leche durante el calentamiento, entre otros. Un tratamiento térmico medio (< 70°C, 20 min), al pH natural de la leche, causa un decremento pequeño en el tamaño de las micelas de caseína. En cambio, si la leche se calienta a más de 100°C, los cambios en el tamaño son marcadamente dependientes del pH de la leche a la temperatura a la que se calentó (Anema y Li, 2003; Considine et al., 2007; Guyomarc’ et al., 2007).
Guyumarc’ et al. (2007) trataron térmicamente leche descremada con diferentes pH con el fin de disminuir la carga de calor necesaria para formar agregados de proteína/κcaseína y/o incrementar las propiedades de gelatinización ácida de la leche descremada al desplazar estos agregados a la fase sérica. Los resultados demostraron que la transferencia inducida por el calor de las proteínas del suero a la fase micelar se inhibió a un pH de 7.5 o
mayor, mientras que la transferencia de la κcaseína de fase micelar a la sérica aumentó con el aumento del pH, aún a temperaturas bajas. Estos resultados sugieren que un pH alcalino de entre 7.5 – 8.0 fue necesario para prevenir la formación de agregados βlactoglobulina /κ-caseína.
2.1.2. Presión elevada
Los dos procesos a alta presión disponibles para aplicaciones en alimentos en nuestros días son el procesamiento a alta presión hidroestática (PAPH) y la homogenización a alta presión (HAP). La primera se basa en la conservación de alimentos al someterlos a compresión indirecta, empleando agua como fluido presurizante sobre un producto sólido o líquido pre-empacado. Por su parte, la HAP es una tecnología relativamente nueva, que comparte los principios de operación con la homogenización convencional, pero trabajando a presiones de operación hasta 20 veces mayores. Ambos procesos generan cambios importantes sobre las características de proteínas lácteas, pero esta revisión se centrará en el proceso de HAP.
Numerosos estudios se han realizado sobre las aplicaciones de la HAP en el procesamiento de leche y las posibles afectaciones que tiene sobre las estructuras proteicas. La micela de caseína se estabiliza por κ-caseína, fosfato de calcio coloidal e interacciones hidrofóbicas (Roach y Harte, 2008). Dado que la alta presión afecta estos sistemas (Huppertz et al., 2002), un cambio en la agregación o disgregación micelar, producto de la HAP, es esperado. Hayes y Kelly (2003) no observaron cambios en el tamaño micelar con HAP < 150 MPa y sólo reportan una disminución del 5% (180.75nm a 170.65nm) como consecuencia de HAP a 200 MPa a 7°C. Por otra parte, una HAP a 200 MPa con 5 ciclos a través de un homogenizador Emulsiflex, redujo el tamaño micelar 200-300 nm en leche pasteurizada a 150nm en leche
entera presurizada (50%). Los fragmentos de caseína interactuaron con nuevos glóbulos de grasa (producto de la HAP), integrándose a su membrana (Kheadr et al., 2002). Sandra y Dalgleish (2005) confirmaron la contribución de los ciclos múltiples en la reducción del tamaño micelar. Roach y Harte (2008) reportaron resultados con leche descremada presurizada a presiones de 100-350 MPa. La HAP afectó en gran medida el tamaño micelar, pues ésta disminuyó aprox. 30%, de 100 a 200 MPa (278 a 171 nm), mientras que a partir de 250 MPa el tamaño de micela comenzó a incrementar (178 nm) hasta alcanzar 180-210 nm a 350 MPa.
Hayes et al. (2005) estimaron la desnaturalización de β-lactoglobulina y αlactalbúmina por HPLC (cromatografía de líquidos de alta eficacia, por sus siglas en inglés) de fase reversa en leche entera presurizada a 150-250 MPa. La barorresistencia de la α-lactalbúmina es mucho mayor que la de β-lactoglobulina, ya que 10, 42 y 56% de β-lactoglobulina se desnaturalizó a 150, 200 y 250 MPa, respectivamente. Mientras tanto, α-lactalbúmina apenas si fue afectada por la HAP; el porcentaje de proteína desnaturalizada (<10%) se mantuvo aproximadamente constante en todas las presiones investigadas, sugiriendo que la desnaturalización fue por el incremento de temperatura inherente a la HAP, más que por el proceso de presurización en sí, además que la desnaturalización térmica de α-lactalbúmina es reversible en un 80-90%.
Datta et al. (2005) determinaron la contribución de la temperatura en la desnaturalización de β-lactoglobulina y αlactalbúmina. La α-lactalbúmina no fue desnaturalizada por combinaciones de presión (200 MPa) y distintas temperaturas de entrada (10-50°C), mientras que para la βlactoglobulina, el patrón de desnaturalización por la HAP, combinando presión y temperatura, varió en relación al observado
para el tratamiento térmico sólo. Mientras que la β-lactoglobulina se desnaturalizó sólo 10% con calentamiento a 80°C, su desnaturalización con HAP inició desde procesos con Tsalida de 65°C, hasta alcanzar un 40% de desnaturalización a Tsalida de 80°C. Por tanto, se concluyó que la desnaturalización de la β-lactoglobulina, bajo estas condiciones, podría deberse a un efecto sinérgico entre temperatura y las fuerzas asociadas con la HAP.
2.1.3.
Microfiltración / Ultrafiltración
Durante la ultrafiltración, es probable que el tamaño de la micela de caseína disminuya cambiando así su estructura a una reconfiguración por enlaces hidrofóbicos a una mucho más compacta. Estos rearreglos pudieran causar algunos cambios fisicoquímicos en las proteínas de la leche durante un tratamiento térmico. Sin embargo, se sabe que estos cambios durante la ultrafiltración son limitados. Erdem (2006) estudió la relación que existe entre la ultrafiltración y el tratamiento térmico que afecta al área hidrofóbica de las proteínas lácteas en leche descremada. En su trabajo concluyó que todos los sistemas lácteos estudiados se vieron afectados durante o después de la ultrafiltración. El sistema proteico de la leche se reorganizó en una estructura mucho más compacta tras la ultrafiltración y esta nueva estructura aumentó su firmeza cuando el factor de concentración se incrementó y la fracción retenida se calentó. Al aumentar la temperatura, la estructura se compactó aún más.
2.2. Medios químicos
2.2.1. Cambios en el pH
La reducción del pH en la leche provoca cambios en las características fisicoquímicas de las micelas de proteínas, llegando incluso a la formación de geles (si se alcanza un nivel
determinado de pH) debido a una desestabilización del complejo de las caseínas. Este proceso de desnaturalización puede ser alterado por numerosos factores, tales como: el calentamiento previo de la leche, la adición de calcio, alteración de la cinética de acidificación y la alteración de las caseínas en relación a las proteínas de suero. Además, el comportamiento de cada tipo de proteína presente en la leche (caseína y proteínas de suero) es completamente distinto.
Cuando el pH de la leche disminuye hasta 4.6 se induce una coagulación de las caseínas. Este proceso de agregación ocurre a cualquier temperatura, pero por debajo de 6°C, los agregados son bastante finos permaneciendo en suspensión, aunque pueden ser sedimentados por centrifugación a baja velocidad. A temperaturas más altas, entre 30 y 40°C, los agregados son bastante más grandes y precipitan fácilmente. Cuando la temperatura es aún mayor, por arriba de los 50°C, el precipitado muestra un aspecto fibroso y es difícil de manejar (Walstra et al., 2006).
En la Fig. 1 muestra algunos de los cambios en la micela de caseína, producto del descenso en el pH de la leche. El fosfato coloidal se traslada hacia la solución, llegando a ser completo este traslado a valores de pH de alrededor de 5.25; la completa remoción de todo el calcio requiere que se continúe el descenso del pH, llegando incluso a valores por debajo del punto isoeléctrico de las caseínas (Fig. 1A). En esta figura también se observa el descenso del valor absoluto del potencial z cuando se reduce el pH (Fig. 1B). Esto se debe a un incremento en la asociación de los iones hidrógeno con los grupos ácidos y básicos de las proteínas, además de un incremento en la actividad de los iones calcio y su asociación con grupos ácidos. En otras palabras, el calcio sustituye al fosfato de calcio en una cierta cantidad. Al seguir el descenso del pH, la carga negativa de las caseínas
incrementa, debido a un proceso de disociación de los iones calcio de las micelas, y eventualmente vuelve a descender debido a la asociación con los iones hidrógeno. Si continúa descendiendo el pH, la caseína se vuelve positivamente cargada. Además, la caída del pH conlleva primero a un hinchamiento de las partículas y eventualmente a un encogimiento considerable (Fig. 1C). Cuando el pH llega a valores de alrededor de 5.3, una considerable sección de la micela migra hacia la solución, con un incremento en la hidrofobicidad de esta sección. En la Fig. 1D se observa los efectos antes explicados a una temperatura de 20°C; si la temperatura aumenta, el resultado observado es mucho menor, mostrándose un efecto contrario al reducir la temperatura (Walstra et al., 2006).
Debido a que el pH de la leche se encuentra cercano a la neutralidad (6.6 - 6.8), resulta necesaria la adición de un ácido para disminuir su pH o un crecimiento importante de la flora microbiana nativa (compuesta principalmente por bacterias ácido lácticas). A nivel laboratorio, el ácido más utilizado es el clorhídrico; aunque, el ácido acético y láctico son también utilizados, pero con menor frecuencia. El ácido láctico producido in situ por bacterias ácido-lácticas también es ampliamente utilizado (Fox y McSweeney, 1998).
En las micelas de caseína, los cambios producidos por la reducción del pH se encuentran mediados en parte por los cambios en el fosfato de calcio coloidal contenido en la micela. El fosfato de calcio coloidal puede ser disuelto y removido de la micela por acidificación en frío, seguido por un proceso de diálisis. A pH de 4.9 el fosfato de calcio coloidal se encuentra completamente disuelto, siendo un proceso reversible cuando se reajusta el pH hacia 6.7, pero con una alteración de las propiedades de las micelas nativas (Fox y Kelly, 2004).

Fig. 1. Propiedades de la micela de caseína en leche en función del pH. (A) Porcentaje de calcio y fosforo inorgánico dentro de las micelas. (B) Potencial electrocinético negativo z. (C) Cantidad de agua por gramo de caseína seca en las micelas separadas por centrifugación. (D) Porcentaje de las diferentes caseínas que no puede ser separado por centrifugación a alta velocidad. (Adaptada de Walstra et al., 2006).
Para el caso de las proteínas de suero, los cambios de pH generan diversos procesos de asociación-disociación. La β-lactoglobulina tiene su punto isoeléctrico alrededor de 5.2, aunque a otros niveles de pH, incluyendo el de la leche (6.7), esta proteína es comúnmente encontrada como un dímero. En un rango de pH de 3.0 a 8.0 permanece como un monómero, pero en el rango 3.1 a 5.1, con la presencia de altas temperaturas y altas concentraciones proteicas, puede asociarse para formar octámeros en un proceso conocido
como gelación en frío, el cual es empleado en elaboración de surimi, mayonesa y algunos postres con formación de geles. Este proceso se lleva a cabo en dos etapas, en la primera se trata térmicamente una solución de proteínas globulares a un pH neutro y a concentraciones iónicas menores a las requeridas para la gelificación. En este paso, el desdoble de las proteínas es seguido por un proceso de agregación por medio de puentes disulfuro. En estas condiciones, se forman agregados solubles debido a que se obtiene una red
cargada y fuerzas repulsivas que evitan la agregación repentina. En un segundo paso, se pueden formar geles turbios por medio del descenso en el pH hasta acercarse al punto isoeléctrico de las proteínas o por medio de la adición de sal. Los geles formados por ácidos tienden a ser más fuertes que los formados por sales, a la misma concentración proteica (Cavallieri et al., 2007). Por otra parte, las propiedades emulsificantes de la βlactoglobulina también son afectadas por el pH. A pH ácido su capacidad emulsificante es menor que a pH 7 aunque su hidrofobicidad es mayor a estos valores de pH. En un estudio sobre adsorción competitiva en emulsiones estabilizadas por proteína aislada de suero a pH de 7 y 6, mostró una mayor cantidad de βlactoglobulina en la interfaz en comparación con la α-lactalbúmina, siendo un contenido contrario cuando el pH descendió a 3 (Fang y Dalgleish, 1997).
Una aplicación industrial del proceso de gelificación por acidificación es la elaboración de yogurt; en el cual, la leche es normalmente calentada antes de la fermentación, con la intención de favorecer la formación de los enlaces covalentes entre la κ-caseína y la βlactoglobulina y la agregación de las sueroproteínas (Lucey, 2002; IDF, 2007). Estos enlaces vuelven, el gel formado, menos permeable y robusto en las primeras 24 horas en comparación con los geles formados por procesos enzimáticos. En este producto, es común la separación de las proteínas de suero del gel formado después de un tiempo de almacenamiento (lo cual es visto como un defecto en el producto), la búsqueda de soluciones a este proceso sigue siendo una de las áreas de investigación más importantes.
2.2.2. Adición de etanol
La coagulación de la leche por adición de etanol es un método de análisis empleado para determinar la estabilidad de la leche, en especial si va a ser sometida a altas
temperaturas de procesamiento. Este procedimiento se basa en asumir que toda la leche ha desarrollado una acidez microbiana, y por tanto resulta positiva a esta prueba. Sin embrago, se ha demostrado que no todo resultado positivo se debe a una leche ácida, sino que se puede tratar de una leche con desbalance mineral, principalmente de calcio (Alvarado et al., 2006).
Otra característica altamente estudiada, es la adición de etanol en la leche y su calentamiento con la intención de desasociar la micela de caseína. En condiciones de 60°C y 30% (v/v) de etanol se produce un cambio en la leche que la vuelve de opaca a translúcida. Este cambio en la turbidez de la leche es debido a la disociación de las micelas de caseína en sus componentes proteicos solos, al llevarse a cabo un cambio en la hidrofobicidad de la leche. Con esta intención, Trejo y Harte (2010) llevaron a cabo un estudio sobre el uso de tratamientos térmicos y la adición de etanol, buscando cambiar la hidrofobicidad de la micelas de caseína y su eventual disociación, para obtener las proteínas constituyentes de las micelas separadas. Sus resultados muestran que es posible rastrear, por medio de la fluorescencia, los cambios en la hidrofobicidad de la leche sometida a las condiciones antes mencionadas, aunque en tratamientos con una concentración mayor a 30% de etanol y tratamientos térmicos mayores a 40°C, se reduce la respuesta obtenida. Esto puede ser debido a un proceso de inhibición competitiva, aunque el mecanismo exacto sigue siendo desconocido.
2.2.3 Adición de sales
Las sales neutras tienen una influencia muy marcada en la solubilidad de las proteínas globulares. Su efecto no sólo depende de su concentración, sino que también de las cargas eléctricas de sus cationes y aniones. Las proteínas, al ser macromoléculas ionizables, se ven alteradas por las interacciones
electrostáticas que establecen consigo mismas y con el medio que las rodea. Las sales modifican la estructura del agua e influyen también en la conformación de las proteínas mediante interacciones electrostáticas. Es así como, en función de la fuerza iónica, las sales pueden solubilizar o precipitar estos polipéptidos (Badui, 1993).
Con el objetivo de lograr micelas de caseína aisladas en la leche y sin la presencia de proteínas de suero, Hernández y Harte (2009) llevaron a cabo un estudio para obtener micelas de caseína aisladas, empleando un cambio en el balance mineral de la leche y un proceso de microfiltración. Empleando cloruro de calcio, fosfato de sodio o citrato de potasio en concentraciones en un nivel de 0 a 100 mM, con un proceso de microfiltración de flujo tangencial (0.22µm). Tratamientos selectos fueron capaces de aislar completamente micelas de caseína (usando
fosfato de sodio en un nivel de concentración de 10-50 mM), llegando inclusive a separar completamente las proteínas de suero.
2.3. Medios enzimáticos
2.3.1. Renina o quimosina
El uso de la renina, también conocida como quimosina, para coagular caseína es un proceso tradicional inicial en la elaboración de muchos tipos de queso. Esta coagulación ocurre en 2 fases principales (Fig. 2).
En la primera etapa, las micelas de caseínas se ven modificadas por una pequeña proteólisis de κ-caseína liberándose así la molécula cargada y glicosilada de κ-caseína, así como una disminución en el diámetro de la micela. La pérdida de la κ-caseína resulta en una reducción en el potencial zeta de las micelas, así como una pérdida de la estabilidad
Caseína (primaria, fase enzimática)
Para-caseína + pequeños péptidos
Ca2+, > 20°C (secundaria, fase noenzimática)
Coágulos (gel)
Fig. 2. Coagulación de la leche (Adaptada de Fox et al., 2000).
sérica que ésta proveía. La segunda etapa ocurre cuando el 60-85% de la κ-caseína total ya ha sido hidrolizado. Las micelas desestabilizadas se aglomeran por la combinación de interacciones de van del Waals’, hidrofóbicas, calcio dependientes y ión-par específicas. En este punto se forma una red proteica que atrapa a la grasa y a la humedad (IDF, 2007). Algunos autores afirman que existe una tercera etapa de coagulación llamada estabilización del gel (McMahon y Brown, 1984), donde ocurren más entrecruzamientos incrementándose así la firmeza del gel. McMahon y Brown (1990) describieron el proceso de coagulación de las proteínas de la leche como se muestra en la Fig. 3.
Los factores que afectan a la coagulación enzimática incluyen: a) concentraciones bajas de Ca2+, las cuales pueden inhibir la agregación, por lo que la adición de CaCl2 es recomendable; b) pH, muchos productos obtenidos por coagulación por efecto de la renina, también son acidificados por cultivos iniciadores o por acidificación directa. Cuando el pH en la leche es bajo, el proceso de coagulación es más rápido y se forman coágulos más firmes; c) concentración proteica; d) concentración de renina y e) temperatura de coagulación.
Agregación
Formación de una red de partículas de caseína en el punto de gelatinización
2.3.2. Reacciones catalizadas por transglutaminasas
Dentro de los métodos bioquímicos, el entrecruzamiento enzimático de las proteínas lácteas es particularmente importante. Dentro de este grupo de enzimas se encuentran la transglutaminasa, la lipoxigenasa, tirosinasa, peroxidasa, lisiloxidasa, bisulfuro isomerasa, lacasa y sulfidril oxidasa; pero únicamente se ha estudiado el efecto de la transglutaminasa sobre el entrecruzamiento enzimático de las proteínas lácteas (Huppertz, 2009).
La transglutaminasa cataliza la reacción de aciltransferencia entre los grupos γcarboxiamida de residuos glutámicos ligados a proteínas o péptidos y aminas primarias (Ando et al., 1989; Márquez et al., 2006; Barreiro y Seselovsky, 2003). Existen dos tipos de transglutaminasa, las calcio dependientes que se encuentran en el hígado y plasma sanguíneo de mamíferos, en pescados y en ciertos tejidos vegetales; y las calcio independientes obtenidas de la fermentación de algunos microorganismos tales como Streptoverticillum cinnamoneum y Streptoverticillum mobaraense (Barreiro y Seselovsky, 2003; Færgemand y Murray, 1998; Motoki y Kumazawa, 2000; Chobert,
Continuación de incorporación de micelas de caseína dentro de la red y reacomodo de las cadenas de caseína Fusión y consolidación de las micelas dentro de gruesas cadenas con rechazo al suero
3. Proceso de coagulación de las proteínas lácteas (McMahon y Brown, 1990).
Fig.
2003). Las tranglutaminasas se muestran activas en un rango de pH de 4.5 a 9 con un óptimo entre 6 y 7 pueden ser inactivadas por un aumento en la temperatura interna (2 h a 65°C, 15 min a 70°C, 5 min a 75°C ó 1 min a 80°C) (Barreiro y Seselovsky, 2003).
Las propiedades funcionales de las proteínas se ven mejoradas por la acción de cohesión producida por esta enzima; entre estas propiedades se encuentran la textura, capacidad de retención de agua y capacidad de formación de geles (Barreiro y Seselovsky, 2003; Márquez et al., 2006). Las proteínas que presentan estructuras muy variables como es el caso de las caseínas son buenos sustratos para la transglutaminasa, ya que son especialmente susceptibles al entrecruzamiento inducido por esta enzima siempre y cuando se presente una pre-desnaturalización como por ejemplo a causa de un tratamiento térmico (Huppertz, 2009). Se recomienda que se encuentre en solución acuosa, ya que algunos solventes orgánicos, como el etanol por ejemplo, pueden desnaturalizar a la enzima. Específicamente en la leche, aumentan la viscosidad de ésta (Barreiro y Seselovsky, 2003).
La susceptibilidad al entrecruzamiento de cada tipo de caseína está primordialmente relacionada a la accesibilidad de la proteína. En el caso de las micelas de caseína, las que se encuentran en la superficie son más susceptibles que las que se encuentran en el núcleo. Cuando las caseínas se encuentran en agregados pequeños, como por ejemplo en forma de caseinato de sodio, su susceptibilidad al entrecruzamiento aumenta. En el caso de la leche fluida, el entrecruzamiento de las caseínas por transglutaminasa aparece primero dentro de las micelas de caseína (intramicelar); la formación de un entrecruzamiento entre las micelas de caseína cercanas (entrecruzamiento inter-micelar) no puede ser observado (Huppertz, 2009).
Como consecuencia del entrecruzamiento intra-micelar de las caseínas por transglutaminasa, las propiedades de las micelas de caseínas se ven alteradas considerablemente. Las caseínas que no han sido tratadas se pueden clasificar como una agrupación coloide, cuya estructura es mantenida por interacciones de varios solventes débiles entre las moléculas de proteínas y la interacción de residuos de aminoácidos fosforilados de las caseínas con los nanoclusters del fosfato de calcio, los cuales se encuentran aleatoriamente dispersos por toda la micela de caseína. Tal es el caso de la interrupción de las interacciones entre proteínas o bien entre las proteínas y los nanoclusters de fosfato de calcio que las micelas de caseína se ven fácilmente alteradas. Por medio de mediciones de dispersión de luz se ha demostrado que el entrecruzamiento intra-micelar no altera la estructura de la micela de caseína (Huppertz y de Kruif, 2007). Sin embargo, otros estudios de dispersión luminosa, han demostrado que el entrecruzamiento intra-micelar disminuye considerablemente la susceptibilidad de rompimiento de las micelas de caseínas, finalmente ablandando las partículas de caseína las cuales son completamente estables contra el rompimiento, hinchamiento o encogimiento bajo la influencia de los cambios en la calidad del solvente, por ejemplo partículas de nanogel de caseína (Smiddy et al., 2006; Huppertz y de Kruif, 2007).
La estabilidad del coloide formado por las micelas de caseínas así como el mantenimiento de la estabilidad del sistema durante el tratamiento térmico o bien en un medio con alcohol, se ve fuertemente afectado por el entrecruzamiento de caseína por efecto de la transglutaminasa. La estabilidad del coloide formado por las micelas de caseína se logra por el rompimiento de la κ-caseína proveniente de la superficie de la micela. La estabilidad del coloide puede ser reducida
removiendo o bien colapsando ese fragmento de la proteína (De Kruif, 1999).
Los cambios producidos en las propiedades funcionales de las caseínas, como consecuencia del entrecruzamiento enzimático, ofrecen un amplio rango de aplicaciones en alimentos. Como por ejemplo las propiedades de coagulación ácida en micelas de caseínas tratadas con transglutaminasa permiten el mejoramiento en la textura y estabilidad de yogurt bajo en grasa, así como la opción de disminuir la cantidad de proteína necesaria para lograr una textura agradable en este mismo producto. Su aplicación en la elaboración de quesos obtenidos por coagulación enzimática con renina no es recomendable, ya que limita la coagulación de las caseínas. Sin embargo, su aplicación en la elaboración de leche ultrapasteurizada sí es muy aconsejable, ya que, al incrementar la estabilidad de las caseínas a la coagulación enzimática, se evita así la degradación de ésta por efecto de reacciones de bacterias conteniendo proteasas o con acción proteolítica. Además de esto, existe la posibilidad de evitar la labilidad a gelatinizar causada por la disociación de las caseínas en la elaboración de leche evaporada y concentrada (Huppertz, 2009).
enzimas, cambios de pH, etc.) será el tipo de desnaturalización que sufrirá, con una alteración única en sus propiedades funcionales. El conocimiento, así como la combinación de nuevas tecnologías con los métodos tradicionales, permiten el desarrollo de nuevos productos con propiedades funcionales únicas aprovechando lo mejor de cada tecnología.
Conclusión
Las proteínas lácteas son muy susceptibles a sufrir modificaciones en su estructura dando como resultado un proceso de desnaturalización. En muchos casos, este fenómeno es un proceso intencional para la obtención de derivados de la leche, tales como queso y yogurt, entre otros. Sin embargo, la desnaturalización puede ser una señal de mala calidad en la leche fluida, como en el caso de una separación de fases o acidez. Dependiendo del tratamiento aplicado en la leche (altas presiones, temperatura, presencia de sales,
Agradecimientos
A la Universidad de las Américas Puebla y al Consejo Nacional de Ciencia y Tecnología (CONACyT, México) por el financiamiento recibido para la realización de este trabajo.
Referencias
Adams, A., De Kimpe, N. y Van Boekel, A.J.S. 2008. Modification of casein by the lipid oxidation product malondialdehyde. Journal of Agricultural and Food Chemistry. 56:1713-1719.
Alvarado, C., Zerpa, G., Meléndez, B., Gimenez, O. y Vivas, I. 2006. Uso de la prueba del alcohol en la estimación de la estabilidad protéica en leche de un rebaño holstein de la zona central de Venezuela. Resumen. XIII Congreso Venezolano de Producción en Industria Animal. San Juan de los Morros, Venezuela.
Ando, H. Adachi, M., Umeda, K., Matsuura, A., Nonaka, M., Uchio, R., Tanaka, H. y Motoki, M. 1989. Purification and characteristics of a novel transglutaminase derived from microorganisms. Agricultural Biology and Chemistry. 53(10):26132617.
Anema, S.G. y Li, Y. 2003. The association of denatured whey proteins with casein micelles in heated reconstituited milk and its effect on casein micelle size. Journal of Dairy Research. 70:73-83.
Badui, S. 1993. Química de las Alimentos. Pearson Educación, México. pp. 125-209.
Barreiro, J.F. y Seselovsky, R. 2003. Usos de la transglutaminasa en la industria alimentaria.
Elaboración de carne recosntrituida. Invenio. 6(010):157-164.
Bouchoux, A., Cayemitte, P-E., Jardin, J., GésanGuiziou, G. y Cabane, B. 2009. Casein micelle dispersions under osmotic stress. Biophysical Journal. 96:693-706.
Cavallieri, F.A.L., Costa-Netto, A.P., Menossi, M. y Da Cunha, L.R. 2007. Whey protein interactions in acid cold-sets gels at different pH values. Lait. 87:535554.
Chobert, J-M. 2003. Milk protein modification to improve funcional and biological properties.
Considine, T., Patel., H.A., Anema, S.G., Singh, H. y Creamer, L.K. 2007. Interaction of milk proteins during heat and high hydrostatic pressure treatments - A review. Innovative Food Science and Emerging Technologies. 8:1-23.
Czernicka, M., Domagala, J., Sady, M. y Wieteska, I. 2009. Functional properties of milk proteins modified by transglutaminase depending on incubation conditions with the enzyme. Biotechnology in Animal Husbandry. 25:737-743.
Dalgleish, D.G. 1992. Bovine milk protein properties and the manufacturing quality of milk. Livestock Production Science. 35:75-93.
Dalgleish, D.G., Spagnuolo, P.A., Goff, H.D. 2004. A possible structure of the casein micelle based on high-resolution field-emission scanning electron microscopy. International Dairy Journal. 14:10251031.
Datta, N., Hayes, M.G., Deeth, H., y Kelly, A.L. 2005. Significance of frictional heating for effects of high pressure homogenisation on milk. Journal of Dairy Research. 72:1–7.
de Kruif, C.G. 1999. Casein micelle interactions. International Dairy Journal. 9:183-188.
de Kruif, C.G. 2003. Caseins. Progress in Biotechnology. 23: 219-269.
Erdem, Y.K. 2006. Modification of casein micelle structure caused by ultrafiltration and heat treatment: A spectofluorimetric and kinetic approach. Journal of Food Engineering. 74:536-541.
Færgemand, M. y Murray, B.S. 1998. Interfacial dilatational properties of milk proteins cross-linked by transglutaminase. Journal of Agricultural and Food Chemistry. 46:884-890.
Famelart, M.H., Lepesant, F., Gaucheron, F., Graet, Y.L. y Scuck, P. 1996. pH-Induced physicochemical modifications of native phosphocaseinate suspensions: influence of aqueous phase. Lait. 76:445-460.
Fang, Y. y Dalgleish, D.G. 1997. Conformation of βlactoglobulin studied by FTIR: Effect of pH, temperature, and adsorption to the oil-water interface. Journal of Colloid and Interface Science. 196:292-298.
Farrell, H.M. 1988. Physical equilibria: proteins. En: N.B Wong (Ed). Fundamentals of Dairy Chemistry. Tercera edición. Reinhold, Nueva York. pp. 461510.
Farrell, H.M., Malin, E.L., Brown, E.M. y Qi, P.X. 2006. Casein micelle structute: What con be learned from milk synthesis and structural biology?. Current Opinion in Colloid & Interfacial Science. 11:135147.
Ferrandini, E., Castillo, M., López, M.B. y Laencina, J. 2006. Modelos estructurales de la micela de caseína. Facultad de Veterinaria de la Universidad de Murcia. 22:5-18.
Fox, P.F. y McSweeney, P.L.H. 1998. Dairy Chemistry and Biochemistry. Blackie Academic & Professional. Cork. Irlanda. p. 461.
Fox, P.F., Guinee, T.P., Cogan, T.M. y McSweeney, P.L.H. 2000. Fundamentals of Cheese Science Aspen Publishers. Gaithersburg, Maryland. p.99.
Fox, P.F. y Kelly, A.L. 2004. The caseins. En: R.Y. Yada (Ed.). Proteins in food processing. CRC Press. Boca Ratón EUA. pp 52-53.
Guyomarc'H, F., Mahieux, O., Renan, M., Chatriot, M., Gamerre, V., Famelart, M-H. 2007. Changes in the acid gelation of skim milk as affected by heattreatment and alkaline pH conditions. Lait. 87:119137.
Hayes, M.G, Fox, P.F. y Kelly, A.L. 2005. Potential applications of high pressure homogenisation in processing of liquid milk. Journal of Dairy Research. 72:25–33.
Hayes, M.G. y Kelly, A.L. 2003. High pressure homogenization of milk (b) effects on indigenous enzymatic activity. Journal of Dairy Research 70:307-313.
Hernández, A. y Harte, F.M. 2009. Isolation of caseins from whey proteins by microfiultration modifying
K. Zimmermann – Stein et al. / Temas Selectos de Ingeniería de Alimentos 4 – 2 (2010): 24-37
the mineral balance in skim milk. Journal of Dairy Science. 92(11):5357-5362.
Huppertz, T., Kelly, A.L. y Fox, P. 2002. Effects of high pressure on constituents and properties of milk. Journal of Dairy Scince. 12:561–572.
Huppertz, T. y de Kruif, C.G. 2007. Rennet-induced coaguation of enzymatically cross-linked casein micelles. International Dairy Journal. 2007:442447.
Huppertz, T. 2009. Enzymatic cross-linking of milk proteins: effects on structure, stability and functionality. SciTopics. Disponible: http://www.scitopics.com/Enzymatic_cross_linking of_milk_proteins_effects_on_structure_stability_and _functionality.html. Adquirido: 20/08/10.
IDF. 2007. Coagulation of milk processes and characteristics. Bulletin of the International Dairy Federation. 420:1-28.
Kheadr, E., Vachon, J.F., Paquin, P. y Fliss, I. 2002. Effect of dynamic high pressure on microbiological, rheological and microstructural quality of cheddar cheese. Journal of Dairy Science. 12:435–446.
Kim, H.Y., Kim, S.H., Choi, M.J., Min, S.G. y Kwak, H.S. 2008. The effect of high pressure-low temperature treatment on physicochemical properties in milk. Journal of Dairy Science 91:4174-4182.
Lucey, J.A. 2002. Formation and physical properties of milk protein gels. Journal of Dairy Science. 85:281294.
Márquez, E., Arévalo, E., Barboza, Y., Benítez., Rangel, L. y Archile, A. 2006. Efecto de la concentración de transglutaminasa y tiempo de reacción en ka estructura en la estabilidad de productos reestructurados. Revista Científica 16(6):662-667.
McMahon, D.J. y Brown, R.J. 1983. Composition, structure, and integrity of casein micelles: a review. Journal of Dairy Science. 67(3):499-512.
McMahon, D.J. y Brown, R.J. 1984. Enzymatic coagulation of casein micelles: a review. Journal of Dairy Science. 67(5):919-929.
McMahon, D.J. y Brown, R.J. 1990. Development of surface functionality of casein as the controlling parameter of enzymatic milk coagulation. Colloids and Surfaces. 44:263-279.
Mirsky, A.E. y Pauling, L. 1936. On the structure of native, denatured, and coagulated proteins. California Institute of Technology. 22:439-447.
Motoki, M. y Kumazawa, Y. 2000. Recent research trends in transglutaminzase technology for food processing. Food Science and Technology Research. 6(3):151-160.
Panouillé, M., Nicolai, T. y Durand, D. 2004. Heat induced aggregation and gelation of casein submicelles. International Dairy Journal. 14:297303.
Roach, A. y Harte, F. 2008. Disruption and sedimentation of casein micelles and casein micelles isolates under high-pressure homogenization. Innovative Food Science and Emerging Technologies. 9:1-8.
Sandra, S. y Dalgleish, D.G. 2005. Effects of ultra-highpressure homogenization and heating on structural properties of casein micelles in reconstituted skim milk powder. Journal of Dairy Science. 15:1095–1104.
Singh, H. y Waungana, A. 2001. Influence of heat treatment of milk on cheesemaking properties. Internationa Dairy Journal. 11:543-551.
Smiddy, M.A., Martin, J.-E. G. H., Kelly, A.L., de Kruif, C.G. y Huppertz, T. 2006. Stability of casein micelles cross-linked by transglutaminase. Journal of Dairy Science. 89:1906-1914.
Trejo R. y Harte, F. 2010. The effect of ethanol and heat on the functional hydrophobicity of casein micelles. Journal of Dairy Science. 93 :2338–2343.
Van Hekken, D.L. y Holsinger, V.H. 2000. Use of cold microfiltration to produce unique β-casein enriched milk gels. Lait. 80:69-76.
Walstra, P., Wouters, J.T. y Geurts, T.J. 2006. Dairy Science and Technology. Segunda edición. CRC. EE.UU. 763 p.

Temas Selectos de Ingeniería de Alimentos 4 – 2 (2010): 38-47

Efectos del calentamiento con microondas en alimentos fluidos
V. Reyes-García*, A. López-Malo y M. E. Sosa-Morales
Departamento de Ingeniería Química, Alimentos y Ambiental, Fundación Universidad de las Américas Puebla. Ex Hacienda Sta. Catarina Mártir, Cholula, Puebla. C.P.72820. México.
Resumen
Las microondas son ondas electromagnéticas, con frecuencias de 915 o 2450 MHz, que pueden generar calentamiento en un material. Los hornos de microondas son comunes en uso doméstico, pero también es posible aplicar microondas a nivel industrial, con fines de pasteurización o esterilización. A través de esta revisión, se pretende mostrar y discutir de forma general la situación actual del uso de la tecnología de microondas para el tratamiento de algunos alimentos fluidos (jugo de manzana, leche, agua de coco, puré de chícharo, puré de zanahoria), así como los efectos que esta forma de calentamiento puede tener en sus propiedades fisicoquímicas, en la inactivación de microorganismos o de enzimas de interés y sobre algunos componentes importantes del alimento.
Palabras clave: microondas, calentamiento, alimentos.
Abstract
Microwaves are electromagnetic waves with frequencies of 915 or 2450 MHz, which can generate heat in a material. Microwave ovens have a domestic use, but it is also possible to apply them at industrial scale for pasteurization or sterilization of foods. This review intends to show and discuss an overview of the current use of microwave technology for food treatments of certain fluids such as apple juice, milk, coconut water, green pea puree and carrot puree, as well as, the effects that this heating can have on their physicochemical properties, on the inactivation of important microorganisms and enzymes or on some food compounds.
Keywords: microwave heating, food.
Introducción
La aplicación de calor para la conservación de los alimentos ha dado lugar al desarrollo de varias metodologías. La finalidad de los tratamientos térmicos es reducir la carga
*Programa de Maestría en Ciencia de Alimentos
Tel.: +52 222 229 2126, fax: +52 222 229 2727
Dirección electrónica: veronica.reyesga@udlap.mx
microbiana del alimento, y de modo particular los patógenos, o bien llegar a la asepsia total (Bello, 2000). En otros casos, el objetivo es la destrucción de enzimas de interés, u otros fines particulares.
Los tratamientos térmicos aplicados por la industria alimentaria incluyen escaldado, pasteurización y esterilización comercial,
mediante el empleo de vapor o agua caliente, dependiendo de la temperatura deseada. El término pasteurización hace referencia a tratamientos térmicos, el cual consiste en aplicación de calor a temperaturas que se sitúan por debajo del punto de ebullición del agua. Por consiguiente, se trata de un método de conservación que sólo conduce a una destrucción selectiva de la población microbiana patógena que está presente en un alimento. La elección de la temperatura a aplicar y el tiempo necesario depende del objetivo del tratamiento térmico, y no debe provocar cambios en la composición química del alimento (Bello, 2000). Sin embargo, las esporas termorresistentes no resultan inactivadas bajo estas condiciones y para lograr una conservación más prolongada se precisa una forma más drástica de tratamiento térmico (Lewis, 1993), como la ultrapasteurización. La pasteurización ha sido utilizada para diversos alimentos, entre ellos, leche, huevo líquido, jugos de fruta y cerveza. Algunos alimentos pasteurizados requieren de refrigeración después del proceso térmico, como temperaturas de 10°C o menores.
El calentamiento con microondas se refiere al uso de ondas electromagnéticas de ciertas frecuencias para generar calor en un material (Datta y Davidson, 2003). El calentamiento de los alimentos por microondas resulta de la conversión de la energía de microondas en calor por fricción de las moléculas (principalmente polares, como las del agua) debido a la rápida fluctuación en el campo electromagnético (Potter y Hotchkiss, 1996; Decareau, 1992). Las microondas generan calor por calentamiento dieléctrico, lo que en términos simples involucra la conversión de energía eléctrica en calor. En comparación con otros métodos de calentamiento tradicionales, las principales ventajas del uso de microondas son la penetración de calor inmediata, la reducción en el tiempo de calentamiento y el ahorro de energía. Esta revisión presenta los principios de tratamientos térmicos y de
microondas, el estado actual del uso de la tecnología de microondas en los alimentos fluidos, así como los efectos que esta forma de calentamiento puede tener sobre microorganismos o enzimas de interés, así como sobre algunos constituyentes importantes del alimento.
Revisión Bibliográfica
1. Generalidades sobre tratamientos térmicos
Los tratamientos térmicos en alimentos se han usado por años con fines de conservación. Entre ellos se incluyen el escaldado, la pasteurización, la esterilización y el freído. El calentamiento aplicado a los alimentos, puede seguir alguno de los siguientes mecanismos: conducción, convección ó radiación (Kern, 1999). En algunos casos, un mismo tratamiento térmico implica más de un mecanismo de transferencia.
1.1. Mecanismos de transferencia de calor
Conducción: Cuando el calor se transmite por conducción, la energía cinética es transmitida de molécula a molécula y es el mecanismo principal de transferencia a través de un sólido. Un objeto frío se calienta por conducción sólo cuando está en contacto directo con una fuente de calor. La conducción es un método comparativamente lento de transmitir calor, aunque algunos materiales son mejores conductores que otros (Vaclavik y Christian, 2002). La transferencia de calor por conducción se da en la cocción de algunos alimentos, como en sartén.
Convección: En este caso, la transferencia de energía es mediante corrientes de convección. La energía llega a través del aire, agua o grasas líquidas. Cuando un gas o un líquido se calienta, se hace menos denso que su parte fría. Los gases y líquidos calientes se
elevan y los fríos se dirigen hacia abajo, en donde se aplica el calor. Esto origina un flujo desde el fondo hacia arriba y desde arriba hacia el fondo. Por lo tanto, este flujo circular de corrientes de convección tiende a mantener la temperatura algo uniforme en todo el medio (Vaclavik y Christian, 2002). En muchas situaciones prácticas se consideran tanto la conducción como la convención simultáneamente; ya que la mayor parte de los procesos en alimentos las involucran, como el horneado, el freído y la esterilización comercial (Lewis, 1993).
Radiación: Las unidades de energía que viajan como ondas o rayos electromagnéticos, son una fuente de calor. Estas ondas tienen longitudes de onda mayores que la luz visible. Existen dos tipos de radiación: ionizante, como la de los rayos γ y la no ionizante, como las microondas y las ondas de radiofrecuencia (Potter y Hotchkiss, 1996). La radiación es un método rápido de calentamiento, ya que la energía radiante se mueve a la velocidad de la luz (Vaclavik y Christian, 2002).
1.2. Pasteurización
La pasteurización es un tratamiento térmico que elimina parte de los microorganismos vegetativos de un alimento, permitiendo consecuentemente periodos mayores para su almacenamiento y manejo. El tratamiento específico para pasteurizar un alimento en particular, depende de varios factores como la resistencia térmica del microorganismo vegetativo o patógeno que se busque eliminar y la sensibilidad del producto al calor. Para el caso de la leche se usan métodos de alta temperatura-corto tiempo (HTST) continuo a 72 °C por 15 s, o de baja temperatura-largo tiempo (LTLT) proceso típico a 63 °C por 30 minutos (Lewis, 1993).
Los métodos de pasteurización más comunes incluyen el uso de intercambiadores de calor, como el de doble tubo ó el de placas, en donde
el calor se transmite por conducción y por convección (Casp y Abril, 1999). Sin embargo, en los últimos años se han estado reportando opciones de pasteurización usando microondas, donde el mecanismo de transferencia de calor principal es por radiación.
1.3. Efecto del calor sobre los microorganismos
Los microorganismos responden de forma diferente a la exposición a altas temperaturas. Algunos son sensibles al calentamiento y mueren a temperaturas relativamente bajas, otros, los termófilos, pueden soportar altas temperaturas sin que lleguen a morir (Frazier, 1993).
Las bacterias se destruyen a una velocidad proporcional a su número presente en el alimento. Esto es conocido como velocidad de destrucción logarítmica, lo que significa que a una temperatura constante, se destruirá el mismo porcentaje de una población bacteriana en un intervalo de tiempo determinado, independientemente del tamaño de la población superviviente. En otras palabras, si el 90 % de la población bacteriana se destruye en el primer minuto de calentamiento, el 90 % de la población restante se destruirá en el segundo minuto de calentamiento y así sucesivamente. Por ejemplo, si el alimento contiene 1 millón de microorganismos y 90 % se destruyen en el primer minuto, 100 mil microorganismos sobrevivirán. Un parámetro importante que puede ser obtenido a partir de la gráfica de supervivencia es el valor D o tiempo de reducción decimal. El valor D se define como el tiempo en minutos a una temperatura determinada necesario para destruir el 90 % de los microorganismos de una población dada. También se puede describir como el tiempo requerido para reducir la población en un factor de 10, o en un ciclo logarítmico. El valor D varía para las
diferentes especies microbianas (Vaclavik y Christian, 2002).
2. Descripción de microondas
2.1. Definición de microondas
Las microondas son ondas que se encuentran después de la región de infrarrojo en el espectro electromagnético, con menores frecuencias y mayores longitudes de onda que el infrarrojo, el espectro visible y la región ultravioleta (Fig. 1).
En un horno de microondas, el dispositivo que genera las ondas es llamado magnetrón, las ondas son conducidas a través de un canal hasta la cavidad donde se coloca el alimento. Existen dos frecuencias de microondas autorizadas para su uso con fines de investigación, que son 915 y 2450 MHz (USDA, 2000). En el campo electromagnético generado existe un rápido cambio de orientación de las moléculas, del orden de millones de ciclo por segundo (Charley, 1989). Cuando las microondas penetran en el alimento, las moléculas dipolares del agua que están presentes oscilan alrededor de sus ejes en respuesta a este cambio de carga, generando calor en el interior del alimento mismo como resultado de esta rápida oscilación, a veces nombrado fricción molecular. Debido a que el calor se genera dentro del alimento, los
tratamientos con microondas son eficientes y rápidos; el tiempo de cocción varía con la carga del horno y con la humedad contenida en los alimentos (Potter y Hotchkiss, 1996; Vaclavik y Christian, 2002).
Los tratamientos con microondas se encuentran dentro de las llamadas tecnologías emergentes, entre las que se encuentran también los sistemas de alta presión, aplicación de pulsos eléctricos, ultrasonido, y ultravioleta, entre otros. Estas tecnologías se están utilizando en la actualidad en diversos procesos agro-alimentarios (Richardson, 2004).
2.2. Principios del calentamiento con microondas
El mecanismo de calentamiento por microondas se fundamenta en la alineación de moléculas polares dentro de un campo eléctrico. El campo eléctrico oscilante es aplicado a un componente dieléctrico polar, y el campo obliga a los dipolos a alinearse (polarizarse). El cambio en la polarización genera una corriente de desplazamiento en el material dieléctrico generando calor. El grado de calentamiento dependerá de los factores del horno y las características del material, como tamaño, contenido de humedad, propiedades dieléctricas, etc. (Peyre et al., 1997). Las

propiedades dieléctricas son la constante dieléctrica y el factor de pérdida dieléctrica. La constante dieléctrica es una medida de la capacidad que tiene el material para almacenar energía electromagnética y el factor de pérdida dieléctrica es la capacidad que tiene el material para convertir la energía electromagnética en calor (Sosa-Morales et al., 2010).
2.3. Ventajas y limitaciones del calentamiento con microondas
Como las microondas calientan desde el interior del material, existe la posibilidad de reducir el tiempo de procesamiento y mejorar la calidad global de los productos tratados (Matsui et al., 2008). El calentamiento con microondas es una herramienta innovadora que puede ser aplicada a nivel industrial por su reducido tiempo de proceso, además de que es considerada una tecnología “verde”, ya que no produce humos, ni genera residuos, lo que la hace ambientalmente amigable (Huang et al., 2007). Los usos de microondas son muchos, entre ellos horneado, concentración, cocción, secado, escaldado, pasteurización, esterilización, remoción de solventes y descongelado, entre otros (Potter y Hotchkiss, 1996).
Las limitaciones de los tratamientos con microondas incluyen el costo de inversión y un calentamiento no uniforme. Sin embargo, se han diseñado sistemas de flujo continuo, y caracterizando los parámetros del proceso (entrada de alimentación, tamaño de la carga de volumen, tasas de flujo volumétrico, la viscosidad del producto y temperaturas de entrada), se puede mejorar dicha uniformidad de calentamiento (Matsui et al., 2008).
3. Estudios de pasteurización con microondas
Los estudios realizados para pasteurizar con microondas incluyen tratamientos en hornos domésticos por lotes a diferentes niveles de potencia, o bien, propuestas para tratamientos continuos, bombeando el fluido a través de la cavidad. Los reportes incluyen potencias bajas para nivel laboratorio, del orden de 500 a 2000 W, mientras que los tratamientos continuos alcanzan potencias de 5 KW para nivel piloto y 60 kW para escala industrial. Las Figs. 2-4 muestran algunas propuestas para la pasteurización de fluidos. A continuación, se presentarán las condiciones y resultados reportados para la pasteurización con microondas de varios alimentos fluidos.

Fig. 2. Esquema de la pasteurización por lotes a nivel laboratorio, de agua de coco (Adaptada de Matsui et al., 2008).

Fig. 3. Esquema de pasteurización continuo para sidra de manzana (Adaptada de Gentry y Roberts, 2005).

Fig. 4. Esquema de la pasteurización de purés de zanahoria y chícharos, a nivel industrial, proceso continuo (Kumar et al., 2008).
3.1. Jugo de manzana
Cañumir et al. (2002) evaluaron el efecto de pasteurización en jugo de manzana en hornos de microondas a niveles de potencia entre 270 y 900 W, dando lugar a una reducción de 2 a 4 ciclos logarítmicos en la población de Escherichia coli. Los datos obtenidos fueron comparados con los convencionales de pasteurización (83°C durante 30 s). El pH no fue afectado por el tipo de tratamiento, siendo de 3.42, pero la acidez titulable y los sólidos solubles fueron ligeramente mayores en los jugos tratados con microondas (0.37% de ácido málico y 16°Bx en jugos después del tratamiento convencional, 0.41% de ácido y 18°Bx en jugos tratados con microondas). El color también fue afectado por el tratamiento: el jugo tratado con microondas no cumplió con el color de acuerdo a las normas, ya que fue más oscuro que el jugo pasteurizado por convección. Los resultados mostraron que no hay un efecto no térmico atribuido a las microondas sobre los microorganismos, y que la inactivación es únicamente debida al calor.
3.2. Leche
La leche cruda se sometió a un tratamiento por microondas (2450 MHz, 532 W) de flujo continuo a 80 o 92 °C durante 15 s, y en un intercambiador de calor convencional en las mismas condiciones por Valero et al. (2000). Una vez pasteurizadas, las muestras fueron envasadas en recipientes estériles y se almacenaron a 4.5°C durante 15 días. Las muestras se tomaron cada dos días para analizar pH, propiedades sensoriales, compuestos volátiles y monosacáridos. En las muestras recién pasteurizadas, los volátiles (incluidos los aldehídos, cetonas, alcoholes, ésteres e hidrocarburos aromáticos) fueron muy similares a los encontrados en la leche cruda. No se observaron diferencias importantes en los valores de pH en todas las muestras tratadas a 80 ó 92 °C por microondas y convencionales, durante los 15 días de
almacenamiento, aunque el pH disminuyó a partir del día 15. El sabor no fue afectado por el tratamiento, según pruebas sensoriales de ensayo triangular después del tratamiento y durante su almacenamiento. Como se ha comentado, el estudio se enfocó en determinar el efecto del tratamiento sobre compuestos volátiles, monosacáridos y percepción sensorial, sin mostrar el efecto del tratamiento sobre algún microorganismo objetivo.
3.3. Salsa con queso
Kumar et al. (2007) combinaron las ventajas de un proceso aséptico, junto con las de calentamiento por microondas. Los perfiles de temperatura en la salida durante el procesamiento de la salsa con queso en una unidad de microondas de 5 kW de potencia mostraron una estrecha distribución de la temperatura entre el centro y la pared del tubo. Por lo tanto, el flujo de calentamiento por microondas continua podría superar los problemas (degradación de color, sabor, textura y nutrientes) asociados a la distribución de temperaturas más amplio entre el centro y la pared en un sistema de calentamiento convencional. El estudio mostró la viabilidad de procesamiento aséptico de la salsa con queso con un sistema de flujo continuo de microondas.
3.4. Agua de coco
La cinética de inactivación de las enzimas polifenoloxidasa (PPO) y peroxidasa (POD) se estudió durante el proceso (discontinuo) por microondas de agua de coco verde por Matsui et al. (2008). La inactivación de la PPO comercial y POD añadida al agua de coco también fue investigada. Los perfiles completos de las corridas experimentales se utilizaron para la determinación de los parámetros cinéticos D y z: PPO (D92.2°C = 52 s y z = 17.6 °C); POD (D92.2°C = 16 s y z = 11.5 °C); PPO / agua de coco estéril: (D84.45°C = 43 s y z = 39.5 °C) y POD / agua de coco
estéril: (D86.54°C = 20 s y z = 19.3 °C). Las enzimas endógenas presentes en el agua de coco presentaron una mayor resistencia en comparación con las que se añadieron al medio esterilizado u otras soluciones de simulación. La inactivación térmica de PPO y POD durante el procesamiento con microondas del agua de coco verde fue significativamente más rápida en comparación con los procesos convencionales. Los autores también analizaron pH (4.89-5.22), acidez (0.032-0-056% expresado como ácido málico), sólidos solubles (2.9-4.02 °Bx) y turbidez (15.19- 35.39%) de tres lotes procesados por microondas, argumentando que las diferencias se debieron a variaciones en la materia prima y no al tratamiento.
3.5. Sidra de manzana
Gentry y Roberts (2004) diseñaron un tratamiento de flujo continuo para pasteurizar sidra de manzana. Los autores consideraron que el seguimiento de temperatura con fibras ópticas en equipos de microondas es caro, y que estos sensores son frágiles. Por ello, propusieron usar un bio-indicador, el 5hidroximetilfurfural. Se determinó la formación de HFM en una solución modelo de sidra de manzana a pH=3.8, que se procesó en un equipo de microondas escala piloto (frecuencia de 2450 MHz, potencia de 0 a 2.5 kW). La concentración de HMF fue mayor en la solución modelo de sidra tratada en el pasteurizador de microondas que aquélla tratada en un sistema convencional, un intercambiador de calor de tubos y coraza a nivel piloto. Posteriormente, Gentry y Roberts (2005) usaron el equipo probado en la solución modelo para pasteurizar dos cidras de manzana (una obtenida por prensado en frío y otra por prensado caliente). La potencia usada fue entre 900 y 2000 W, con lo que se logró reducir la población de Escherichia coli en 5 ciclos-log.
3.6. Purés de chícharo y de zanahoria
La aplicación de microondas para un alimento con flujo continuo es una alternativa prometedora al calentamiento convencional para el procesamiento aséptico de purés de vegetales de baja acidez. Sin embargo, la distribución no uniforme de temperatura y el control de los parámetros de procesamiento son los principales obstáculos en la aplicación. Kumar et al. (2008) realizaron un estudio para superar los problemas asociados a la ampliación de un sistema de flujo continuo con microondas de escala de planta piloto a escala industrial. Las propiedades dieléctricas y perfiles de temperatura se midieron durante la elaboración de puré de chícharos verdes y puré de zanahoria de 20 a 130 ° C en un sistema de flujo continuo de microondas a una potencia de 5 kW. Para el nivel industrial, el puré de chícharos verdes y el puré de zanahoria fueron procesados en un sistema de microondas de 60 kW. En la propuesta, los autores incluyeron mezcladores estáticos a la salida de cada uno de los aplicadores de microondas, con los que la uniformidad de temperatura fue mejorada. En este estudio, no se comprobó la letalidad de algún microorganismo de interés.
Conclusiones
Varios estudios han demostrado el uso de microondas como una tecnología con alto potencial para ser aplicada a nivel industrial, algunos ejemplos de su aplicación para pasteurización de alimentos incluyen leche, jugos, agua de coco, salsa con queso y purés, sin efectos negativos en la calidad de los alimentos pasteurizados. El uso de microondas se ha desarrollado a escala piloto y de nivel comercial, sin embargo, hay que considerar la composición de los materiales para el correcto
diseño ó selección del tipo de equipo.
Agradecimientos
A la Universidad de las Américas Puebla y al Consejo Nacional de Ciencia y Tecnología (CONACyT, México) por las becas recibidas apoyando los estudios de maestría de V. Reyes García.
Huang, Y. Sheng, J. Yang, F. Hu, Q. 2007. Effect of enzyme inactivation by microwave and oven heating on preservation quality of green tea. Journal of Food Engineering, 78: 687-692
Kern Q. D. 1999. Procesos de transferencia de calor. Continental . México, D.F.
Kumar, P., Coronel, P., Simunovic, J. & Sandeep, K.P. (2007). Feasibility of aseptic processing of a lowacid multiphase food product (salsa con queso) using a continuous flow microwave system. Journal of Food Science, 72(3), E121-E124.
Referencias
Bello, G. J. 2000. Ciencia Bromatológica. Principios generales de los alimentos. Ediciones Días de Santos S. A. Juan Bravo 3-A, 28006 Madrid España.
Cañumir, J. A., Celis, J. E, De Bruijn, J. y Vidal, L. V. 2002. Pasteurisation of Apple Juice by Using Microwaves. Lebensmittel-Wissenschaft undTechnologie, 35: 389-392.
Casp, V.A., y Abril, R. J. 1999. Procesos de conservación de los alimentos. Ediciones Mundiprensa. España.
Charley, H. 1989. Tecnología de alimentos: procesos físicos y químicos en la preparación de alimentos. Editorial Limusa. México.
Datta, A y Davidson, P. 2000. Microwave and radio frequency processing. Journal of Food Safety, 65: 32-41.
Decareau, R. V., 1992. Microwave Science and Technology. Encyclopedia of Food Science Technology, vol. 3. 1772-1778.
Frazier, W. C. 1993. Microbiología de los Alimentos. Acribia. Zaragoza, España.
Gentry, T. S. y Roberts, J.S. 2004. Formation kinetics and application of 5-hydroxymethylfurfural as a time–temperature indicator of lethality for continuous pasteurization of apple cider. Innovative Food Science and Emerging Technologies, 5: 327–333.
Gentry, T.S. y Roberts, J.S. 2005. Design and evaluation of a continuous flow microwave pasteurization system for apple cider. LebensmittelWissenschaft und-Technologie, 38: 227-238.
Kumar, P., Coronel, P., Truong, V.D., Simunovic, J., Swartzel, K.R., Sandeep, K.P & Cartwright, G. (2008). Overcoming issues associated with the scale-up of a continuous flow microwave system for aseptic processing of vegetable purees. Food Research International, 41: 454-461.
Lewis, M. J. 1993. Propiedades físicas de los alimentos y de los sistemas de procesado. Acribia. Zaragoza, España.
Matsui, K.N., Wilhelms Gut, J.A., de Oliveira, P.V. y Tadini, C.C. 2008. Inactivation kinetics of polyphenol oxidase and peroxidase in green coconut water by microwave processing. Journal of Food Engineering, 88: 169-176.
Peyre, F., Datta, A., y Seyler, C. 1997. Influence of the dielectric property on microwave oven heating patterns: application to food materials. Journal of Microwave Power and Electromagnetic Energy, 32(1): 3-15.
Potter y Hotchkiss, 1996. Irradiation, Microwave, and Ohmic Processing of Foods. En: Food Science. 5ª. Edición. Aspen. Gaithersburg, Maryland. Pp. 245379
Quimica web. 2007. Espectro electromagnético. Disponible en www.quimicaweb.net. Consultado 30/09/2010.
Richardson, P. 2004. Improving the thermal processing of food. CRC Press. 507p.
Sosa-Morales, M.E., Valerio-Junco, L. García, H.S. y López-Malo, A. 2010. Dielectric properties of foods: Reported data in the 21st Century and their potential applications. LWT- Food Science and Technology, 43: 1169-1179.
U.S. Food and Drug Administration. 2000. Kinetics of microbial inactivation for alternative food processing technologies. Microwave and radio frequency processing. Disponible en:
V. Reyes-García et al. / Temas Selectos de Ingeniería en Alimentos 4-2 (2010): 38-47
http://vm.cfsan.fda.gov/~comm/ift-micr.html. Consultado 01/10/2009.
Vaclavik, V.A. y Christian,, E.W. 2002. Fundamentos de ciencia de los alimentos. Acribia. Zaragoza, España.
Valero, E. Villamiel, M. Sanz, J. Martínez, I. 2000. Chemical and sensorial changes in milk pasteurized by microwave and conventional systems during cold storage. Food Chemistry 70: 77-81.

Temas Selectos de Ingeniería de Alimentos 4 – 2 (2010): 48 - 57

Probióticos: resistencia gastrointestinal y microencapsulación
V. Rodríguez - Guerrero*, J. A. Guerrero - Beltrán
Departamento de Ingeniería Química, Alimentos y Ambiental. Fundación Universidad de las Américas Puebla. Ex Hacienda Sta. Catarina Mártir, Cholula, Puebla. C.P.72810. México.
Resumen
Los probióticos constituyen una interesante alternativa en la prevención y tratamiento de algunas enfermedades humanas; y para ejercer dichos efectos benéficos a la salud, la concentración de bacterias probióticas vivas que se requiere es aproximadamente de 107 UFC /g. La microencapsulación es una de las tecnologías que pueden usarse para mantener la viabilidad de las bacterias probióticas durante el tránsito por el tracto gastrointestinal. Existen varios estudios relacionados con la microencapsulación de probióticos usando diferentes tipos de matrices encapsulantes. Sin embargo, no sólo es importante la microencapsulación y supervivencia de los probióticos durante el proceso de microencapsulación sino que también es importante que éstos se mantengan vivos en el material encapsulante y que lleguen vivos hasta el intestino en donde harán su función benéfica en el huésped.
Palabras clave: probióticos, microencapsulación, tracto gastrointestinal, flora intestinal.
Abstract
Probiotics are an interesting alternative to prevent and treat some humane gastrointestinal illnesses; and to exert health benefits, the concentration of live probiotics bacteria is required of approximately 107 CFU/g. Microencapsulation is a technology that can be used to maintain the viability of probiotics along the transit through the gastrointestinal tract. Actually, there are several of studies regarding the microencapsulation of probiotics using different types of encapsulating agents. However, is important the microencapsulation process and surviving of the probiotics during encapsulation process is not the only important issue but to maintain probiotics alive in the encapsulation matrix as well as to make possible that they reach to the intestine alive where they will provide their beneficial function inside the host.
Keywords: probiotics, microencapsulation, gastrointestinal tract, gut flora.
Introducción
*Programa de Maestría en Ciencia de Alimentos
Tel.: +52 222 229 2126, fax: +52 222 229 2727
Dirección electrónica: veronica.rodriguezgo@udlap.mx
La microbiota intestinal de un adulto sano es relativamente estable. Contiene diversas poblaciones bacterianas benéficas constituidas principalmente por especies de lactobacilos y bifidobacterias; éstas juegan un papel importante en la salud del huésped. El desbalance de la microbiota benéfica puede contribuir al desarrollo de diferentes trastornos en los que se incluyen infecciones del tracto gastrointestinal, constipación, síndrome de colon irritado, enfermedad
inflamatoria del colon y alergias, entre otras. Para prevenir estos riesgos, la Organización Mundial de la Salud (OMS) ha recomendado explotar el potencial terapéutico y profiláctico de microorganismos benéficos o probióticos (Alvarado-Rivas y Díaz-Rivero, 2009).
Los probióticos son definidos como microorganismos no patógenos, que ingeridos, pueden ejercer una influencia positiva en la salud del consumidor. En los probióticos están incluidas bacterias ácido lácticas, las bifidobacterias y algunas levaduras (especialmente Saccharomyces) presentes en alimentos tales como las leches fermentadas, suplementos alimenticios o medicamentos (Marteau y Shanahan, 2003). En la actualidad, los suplementos alimenticos que contienen bacterias probióticas viables son cada vez más reconocidos por los beneficios que éstos pueden aportar a la salud (Komenan et al., 2009). Estos organismos tienen que resistir las condiciones adversas encontradas en el tracto gastrointestinal superior del huésped. Sin embargo, muchas bacterias probióticas carecen de la habilidad de sobrevivir a condiciones extremas de acidez y a concentraciones de sales biliares comúnmente encontradas en el tracto gastrointestinal (Ding y Shah, 2009). Debido a ello, es necesario que los microorganismos sean protegidos con una barrera física que evite su exposición a las condiciones adversas del entorno. Una alternativa es la microencapsulación que consiste en el recubrimiento de pequeñas cantidades de un determinado compuesto o agente biológico mediante un material protector, generalmente de naturaleza polimérica (Ferrer y Dalmau, 2001). El objetivo de la inmovilización o microencapsulación de los microorganismos probióticos es aumentar su integridad y supervivencia para que sean capaces de resistir las condiciones extremas del tracto digestivo, así como su estabilidad
en productos alimenticios y puedan ejercer una acción positiva en la salud del consumidor (Vidal, 2006).
En el presente artículo se realiza una revisión general de bacterias probióticas dentro del contexto de la flora intestinal del humano, los efectos benéficos sobre la salud y los problemas que éstos presentan durante su paso por el sistema gastrointestinal; así mismo se revisan conceptos básicos de microencapsulación de probióticos.
Revisión bibliográfica
1. Tracto gastrointestinal
En el humano, el tracto gastrointestinal constituye la principal superficie de intercambio y comunicación entre el medio interno y el medio ambiente externo que lo rodea. Es una de las principales zonas del cuerpo que se pone en contacto con agentes ambientales potencialmente nocivos tales como las bacterias, virus, toxinas y alérgenos. Desempeña una función primordial en la defensa del organismo frente a estos factores perjudiciales (Sanz et al., 2006; Guarner, 2007). En el humano adulto, la mucosa gastrointestinal alcanza una superficie de 300 a 400 metros cuadrados considerando la superficie total con las vellosidades desplegadas; está dotada de estructuras y funciones (sensores, receptores, glándulas, secreciones, actividad mecánica, etc.) adaptadas específicamente al reconocimiento analítico y bioquímico de las sustancias que transitan por el tubo digestivo. Como resultado de la actividad del tracto gastrointestinal, el individuo obtiene dos importantes beneficios: nutrición, por la digestión y absorción de nutrientes, agua y vitaminas del alimento y defensa, por reconocimiento de elementos externos, desarrollo de sistemas de prevención y
rechazo de posibles agresiones provenientes del mundo exterior (Guarner, 2007). Ambas funciones dependen, no sólo de los componentes estructurales y funcionales de la mucosa intestinal y del sistema inmune asociado, sino también de la presencia y actividad de las comunidades microbianas residentes y en tránsito. La microflora intestinal se puede considerar como un “órgano” más, que está perfectamente integrado a la fisiología del individuo. Los dos elementos funcionales (tubo digestivo y microflora) son interdependientes y su equilibrio condiciona la homeostasis del individuo dentro de su entorno ambiental (Sanz et al., 2006; Guarner, 2007).
A principios del siglo XX, muchas funciones de la flora intestinal eran completamente desconocidas; fue hasta finales del siglo cuando se esclareció que la microflora intestinal tenía varias funciones importantes en el organismo (Del Piano et al., 2006). La flora intestinal es un complejo ecosistema colonizado por varias especies de microorganismos. Este ecosistema es amplio, tanto cuantitativamente como en términos de diversidad; los integrantes mejor conocidos son las bacterias, pero también la integran virus, hongos y protozoos, aunque estos dos últimos sólo representan el 0.05 y 1% del ecosistema, respectivamente (Guarner, 2002; Hart et al., 2002). La distribución de las bacterias varía ampliamente a lo largo del tracto gastrointestinal. La concentración bacteriana es creciente desde tramos digestivos superiores, como el estómago (>103 UFC/g) o el yeyuno (103-106 UFC/g), hasta segmentos distales como el íleon (107-109 UFC/g) y el colon (1011-1012 UFC/g). Esta comunidad bacteriana consta de unas 1200 especies y más de 7000 cepas. La composición de las especies varía con el desarrollo, la edad y la influencia del ambiente externo del individuo (Hart et al.,
2002; Del Piano et al., 2006).
La flora gastrointestinal tiene una parte estática residente (especies nativas) y una parte transitoria, el volumen de la última depende de la composición de la microflora nativa, del ingreso de microorganismos oportunistas y de la destrucción relativa causada por factores exógenos como el estrés, uso de antibióticos, radioterapia o quimioterapia, gastroenteritis, cambios dietéticos y situación inmunológica de huésped, entre otros, que inducen cambios cualitativos y cuantitativos importantes en el organismo (Collins y Gibson, 1999; Vanderplass, 2002). Las bacterias nativas se adquieren al nacer y durante el primer año de vida, mientras que las bacterias en tránsito se ingieren continuamente a través de los alimentos (Guarner, 2007). A los dos años de edad, la flora establecida en el tracto gastrointestinal es prácticamente definitiva, de modo que cada individuo mantiene una flora predominante, variable y relativamente estable; sin embargo, puede haber modificaciones transitorias que suelen ser reversibles (Guarner, 2002).
La flora residente en el tubo digestivo previene la invasión de microorganismos patógenos debido al llamado “efecto barrera”. Esta flora ocupa las fosas ecológicas accesibles y administra, consume y agota todos los recursos para la proliferación de otras bacterias (Guarner, 2002). Intervienen también en el desarrollo normal del sistema inmunitario y en la regulación de respuestas contra patógenos; son esenciales para el establecimiento y el mantenimiento de la tolerancia inmunitaria de las mucosas; participan en varios procesos fisiológicos tales como la digestión y motilidad y en funciones metabólicas del organismo tales como la producción de vitaminas (Del Piano et al., 2006; Peña, 2007).
2. Probióticos
El reconocimiento de determinados microorganismos que pueden ejercer efectos saludables en el huésped ha cobrado especial atención en los últimos años. A dichas especies se les conoce como probióticos (Guarner, 2002); que, cuando son administrados en dosis adecuadas, ejercen un efecto benéfico en la salud del huésped más allá de lo exclusivamente nutricional (Mombelli y Gismondo, 2000; McMaster et al., 2005; Miranda-Novales, 2008). Los probióticos deben ser de origen humano, no patógenos, resistentes al procesamiento, estables en secreciones ácidas y biliares, adherirse a la pared epitelial, tener capacidad de persistir en el tracto gastrointestinal y tener influencia en la actividad metabólica local del organismo (Miranda-Novales, 2008). El uso de bacterias probióticas como complemento en la dieta, puede proveer varios beneficios en el sistema digestivo. El más frecuentemente mencionado, es que ayuda a controlar los microorganismos
indeseados en el tracto gastrointestinal (Zhao et al., 2008), así como también ayudan con problemas relacionados con la intolerancia a la lactosa, gastroenteritis aguda, alergia a algún alimento, dermatitis atópica, enfermedad de Crohn, artritis reumatoide y cáncer de colon, entre otros (Anal y Singh, 2007).
El grupo de bacterias ácido lácticas que comprenden a los Lactobacillus, así como las bifidobacterias, son los microorganismos probióticos típicamente asociados con el tracto gastrointestinal humano. En la Tabla I se muestran las cepas más reportadas en la literatura y las más utilizadas en alimentos fermentados, especialmente en productos lácteos. También se utilizan especies de bacterias no patógenas tales como Streptococcus, Enterococcus y levaduras como Saccharomyces boulardii, además de ser “Generalmente Reconocidos como seguros” (GRAS) (Nomoto, 2005, Anal y Singh, 2007; Rokka y Rantamäki, 2010).
Lactobacillus acidophilus
L. plantarum
L. casei
L. casei spp. Rhamnosus
L. delbruekii spp. bulgaricus
L. fermentum
L. reuteri
Saccharomyces boulardii
Lactococcus lactis spp. lactis
a Adaptado de Anal y Singh, 2007; Rokka y Rantamäki, 2010.
Bifidobacterium bifidum
B. infantis
B. adolescentis
B. longun
B. breve
Strep. salivarius spp. thermophilus
Enterococcus faecalis
Entericoccus faecium
Lactococcus lactis spp. cremoris
Tabla I. Microorganismos probióticos en humanos a Microorganismos
Los aspectos a considerar para la selección de probióticos se enlistan a continuación (Peregrina et al., 2006):
a) Estado fisiológico del microorganismo probiótico adicionado (fase de crecimiento) al sistema biológico.
b) Condiciones de almacenamiento del producto, tales como temperatura y humedad relativa.
c) Composición química del sistema en el cual se añade el probiótico (acidez, carbohidratos disponibles, fuentes de nitrógeno, contenido de minerales, actividad de agua, oxígeno, entre otros).
d) Posibles interacciones del probiótico con otros cultivos iniciadores (producción de bacteriocinas, antagonismo y sinergismo).
3. Efecto de probióticos en el sistema gastrointestinal
El efecto benéfico de los probióticos está relacionado con su habilidad para interactuar y adherirse a la pared intestinal. La adhesión de las bacterias probióticas al intestino ocurre por la asociación de las bacterias con la mucosa o por adherencia al epitelio; para ello, deberá de haber una interacción de fuerzas atractivas y repulsivas entre las superficies participantes (Iñiguez-Palomares et al, 2006). Las bacterias probióticas tienen efectos benéficos en el epitelio intestinal ejerciendo acciones diversas sobre la salud del individuo mediante distintos mecanismos de acción (Ewaschuk y Dieleman, 2006).
3.1. Alteración de flora intestinal
Los probióticos suprimen el crecimiento e invasión de patógenos por varias maneras: excluyendo completamente a las bacterias patógenas porque ellas ocupan el espacio
físico en la capa de la mucosa y las células epiteliales y consumiendo los sustratos que podrían estar disponibles para otros microorganismos, incluyendo patógenos. Por otro lado, los probióticos generan microambientes inapropiados para los patógenos al secretar sustancias inhibidoras de crecimiento tales como peróxido de hidrógeno, ácidos orgánicos y bacteriocinas (Krasaekoopt et al., 2003; Ewaschuk y Dieleman, 2006).Tal es el caso de los Lactobacillus spp., los cuales pueden ayudar a prevenir o tratar diversas enfermedades gastrointestinales, ya sea, impidiendo la ocupación de sitios específicos en el tracto gastrointestinal o produciendo sustancias antagónicas como los ácidos grasos de cadena corta, peróxido de hidrógeno o ácido láctico, que disminuye el pH del medio, impidiendo el desarrollo de diversos microorganismos (García et al., 2009). La razón para utilizar probióticos en diarrea infecciosa, por ejemplo, se fundamenta por la competencia de éstos por los nutrientes y sitios de unión intestinal con los enteropatógenos; se crea además un microambiente ácido y mecanismos de defensa específicos y no específicos (Miranda-Novales, 2008). Rolfe (2000) reporta que las bacterias ácido lácticas inhiben el crecimiento de muchos patógenos entéricos, incluyendo Salmonella typhimurium, Staphylococcus aureus, Escherichia coli, Clostridium perfringens y Clostridium difíile; algunas de estas bacterias ácido lácticas han sido usadas en humanos y animales para tratar diferentes desórdenes gastrointestinales.
3.2. Alteración del sistema inmune de la mucosa
La presencia de probióticos ha mostrado varias modificaciones en la respuesta inmune; estos incluyen aumento de la producción de anticuerpos, aumento de fagocitos, aumento de la actividad de las
células K y facilidad de captación de antígenos en la placa de Peyer (Ewaschuk y Dieleman, 2006). Los probióticos aumentan la actividad de las hidrolasas de las sales biliares que se unen al colesterol ayudando a su eliminación, por lo que tienen un efecto hipocolesterolémico. Mediante la producción de triglicéridos de cadena corta inhiben la síntesis de colesterol o lo redistribuyen desde el plasma al hígado y por de-conjugación de las sales biliares, evitan que éste se reabsorba utilizándolo para la síntesis de ácidos biliares. Mediante la supresión del crecimiento de bacterias indeseables, que convierten los procarcinógenos en carcinógenos, el consumo de enzimas procarcinogénicas o a través de la producción de sustancias inhibidoras de dichas enzimas, es posible que disminuyan el desarrollo de determinados tumores (Ferrer y Dalmau, 2001; Rodríguez et al., 2003).
3.3. Mejora de la función de la barrera
Varios probióticos pueden aumentar la función de la barrera en el epitelio intestinal, por ejemplo el Lactobacillus GG mejora dicha función porque inhibe la apoptosis en las células del epitelio intestinal (Ewaschuk y Dieleman, 2006). Algunas bacterias probióticas producen β-galactosidasa la cual es benéfica para las personas que son intolerantes a la lactosa. Por ejemplo, Lactobacillus delbrueckii ssp., L. bulgaricus y Streptococcus thermophilus, producen dicha enzima en el yogurt; sin embargo, estas bacterias tienen una baja tolerancia a las sales biliares (Krasaekoopt et al., 2003).
4. Factores que afectan la supervivencia de probióticos en el sistema gastrointestinal
Para ejercer un beneficio a la salud, la concentración de bacterias probióticas vivas que se requiere consumir es de aproximadamente 107 UFC/g en el producto.
La viabilidad y actividad de los probióticos son necesarias en el intestino humano por lo que deberían soportar las condiciones adversas encontradas en el tracto gastrointestinal del huésped (Ding y Shah, 2009). Los factores que pueden influenciar fuertemente en la capacidad del probiótico para sobrevivir en el producto y su actividad dentro del tracto gastrointestinal del huésped son:
a) Acidez gástrica: las pruebas de acidez gástrica son imprescindibles ya que las respuestas varían de una especie a otra. El pH del estómago es de 1.5 y según Chou y Weimer (1999) el tiempo promedio de tránsito del alimento, desde que entra hasta que sale del estómago, es de 90 minutos. Las pruebas in vitro de resistencia de microorganismos susceptibles de ser catalogados como probióticos deben verificar que éstos sean capaces de resistir estas condiciones sin perder viabilidad (González y González-Martínez, 2006).
b) Sales biliares: por otro lado, en el intestino delgado, el obstáculo más importante para los microorganismos son las sales biliares. Para que los probióticos puedan ejercer sus efectos beneficiosos deberán resistir la acción de este bactericida natural. La concentración de sales biliares en el intestino humano es variable y difícil de predecir (Chou y Weimer, 1999; González y González-Martínez, 2006).
c) Adherencia al mucus y las células epiteliales: la capacidad de adhesión a las células epiteliales del intestino es un criterio importante para la selección de los probióticos. Sólo las cepas que se puedan adherir a las mucosas y células epiteliales podrán llevar a cabo una colonización efectiva y ejercer los efectos beneficiosos en el huésped. Es más importante la capacidad de adhesión que el tamaño de la bacteria a la hora de competir con el resto de la flora
intestinal que no se adhiere a la mucosa. Si la capacidad de adhesión no es adecuada, la concentración de probióticos sería diluida, hasta un nivel insignificante, después del consumo de alimentos o bebidas (González y González-Martínez, 2006).
d) Flora competitiva: el probiótico deberá tener la habilidad para reducir la adhesión de la flora competitiva, además de la actividad antimicrobiana que favorezca el desplazamiento de patógenos (Sanz et al., 2003).
e) Antibióticos: el probiótico deberá tener resistencia a los antibióticos de amplio espectro. Una de las funciones de los microorganismos probióticos es su eficiencia para restablecer el equilibrio de la flora intestinal después de la terapia antimicrobiana (Peregrina et al., 2006).
5. Microencapsulación de probióticos
A pesar de los efectos benéficos de los probióticos, existe el problema de su estabilidad en productos alimenticios. Una alternativa a la liberación de bacterias vivas directamente en el tracto gastrointestinal, es a través del uso de microcápsulas (McMaster et al., 2005). Se han desarrollado técnicas de microencapsulación y se han aplicado con éxito usando diversas matrices para proteger las células bacterianas del daño causado por ambientes externos (estrés ambiental, oxígeno, sales biliares, ácido, etc.), garantizando y mejorando su supervivencia durante el tránsito gastrointestinal y aumentando su estabilidad (Del Piano et al., 2006). La microencapsulación es un proceso en el cual las células son envueltas por una capa que produce cápsulas que van del orden de micrómetros hasta milímetros de diámetro. La microencapsulación permite separar el núcleo funcional (bacterias probióticas) del ambiente externo por medio de una capa protectora, para su posterior
liberación en el colon (Krasaekoopt et al., 2003; Del Piano et al., 2006). Se debe elegir un sistema que aumente la supervivencia y estabilidad de la bacteria; pueden incluirse estructuras biopoliméricas para protegerlas y lograr un incremento en la liberación de las células viables (Komenan et al., 2009).
Las técnicas de microencapsulación son ampliamente utilizadas en aditivos alimentarios, preparación de enzimas y productos microbiológicos. La microencapsuación puede cambiar la forma, la cantidad y el volumen del material base, controlar la liberación del principio activo y protegerlo (Zhao et al., 2008) contra cambios adversos. Las técnicas más comúnmente usadas para microencapsular probióticos son la extrusión, la emulsión y el secado por aspersión. El tamaño de los microencapsulados es de suma importancia por la influencia que éste puede tener en las propiedades sensoriales del alimento al cual serán incorporados (Rokka y Rantamäki, 2010). El secado por aspersión es una buena alternativa entre los métodos de encapsulación, debido a que se puede producir a gran escala y a bajo costo (Zhao et al., 2008). Hasta la fecha, se han utilizado como materiales encapsulantes gomas comestibles tales como el alginato, κcarragenina, algarrobo, goma xantana, goma guar, carboximetilcelulosa, polímeros derivados de celulosa y pectina, entre otras (McMaster et al., 2005; Anal y Singh, 2007; Ding y Shah, 2009).
Krasaekoopt et al. (2003) mencionan que la encapsulación facilita la fabricación de productos lecheros fermentados, en donde la bacteria tiene características constantes, alta estabilidad durante su almacenamiento y productividad, con respecto a las bacterias no encapsuladas. Se han reportado varias técnicas para la microencapsulación, usando gelatina o gomas vegetales para proveer protección de Bifidobacterium y
Lactobacillus en condiciones ácidas (Del Piano et al., 2006; Ding y Shah, 2009; Rokka y Rantamäki, 2010).
6. Supervivencia de probióticos microencapsulados en el tracto gastrointestinal
De manera general, el objetivo de la microencapsulación de probióticos es protegerlos durante el paso a través del estómago y liberarlos en el órgano al cual van destinadas: el colon. Aquí deberán estar presentes en cantidad suficiente para tener un impacto en la salud del huésped (Del Piano et al., 2006; Rokka y Rantamäki, 2010). La supervivencia de las bacterias probióticas, en condiciones gástricas, depende ampliamente de la estabilidad de la cepa usada, así como de los materiales utilizados para la microencapsulación (Rokka y Rantamäki, 2010). La evaluación de la resistencia de las cepas probióticas es comúnmente estudiada bajo condiciones fisiológicas simuladas (en jugo gástrico, sales biliares y jugo pancreático). Se han realizado pruebas in vitro utilizando jugo gástrico simulado; el cual consiste típicamente en una solución de pepsina y cloruro de sodio ajustada a pH de 1-3 con ácido clorhídrico. La solución intestinal simulada consiste en bilis de bovino o puerco y varios tipos de extractos pancreáticos a un pH de 7.4-7.5 (Del Piano et al., 2006; Rokka y Rantamäki, 2010).
Se han realizado diversos estudios in vitro simulando las condiciones gastrointestinales y utilizando diferentes materiales encapsulantes que protegen a las bacterias probióticas incrementando su supervivencia (Ainsley et al., 2007). Estudios realizados por McMaster et al. (2005) quienes encapsularon Bifidobacteruim lactis usando una mezcla de gelatina hidratada y goma xantana, probaron que la supervivencia de las bifidobacterias después de un periodo de
almacenamiento en buffer fosfato de sodio (pH 7), fue mayor que las bacterias sin encapsular. Ding y Shah (2009) y Ki-Yong y Tae-Ryeon, (2000) utilizando diferentes bacterias (Lactobacillus rhamnosus, L. salivarius, L. plantarum, L. acidophilus, L. paracasei, Bifidobacteruim longum KCTC 3128, entre otras) y materiales encapsulantes como goma xantana, carragenina y alginato de calcio, obtuvieron resultados similares; en general las microcápsulas mejoraron la supervivencia de las bacterias probióticas expuestas en condiciones ácidas y con sales biliares.
Conclusiones
La flora intestinal constituye un complejo ecosistema que desempeña una importante función en la salud del humano y debido a esto es posible hacer uso de bacterias probióticas para prevenir la invasión de patógenos, contrarrestar alteraciones del sistema inmune y de manera general restablecer el equilibrio normal de esa flora. Debido a que la viabilidad y actividad de los probióticos es necesaria en el sistema gastrointestinal, estos microorganismos deben soportar las condiciones adversas de acidez y sales biliares que se encuentran en el sistema gastrointestinal. La microencapsulación puede ayudar a los probióticos a sobrevivir durante el paso a través del estómago permitiendo que lleguen al colon en una cantidad considerable para que puedan ejercer efectos benéficos a la salud del huésped. La microencapsulación, como técnica para proteger compuestos activos delicados, usando diferentes tipos de gomas, es una alternativa para la producción y protección de probióticos que podrían usarse como suplementos alimenticios para la contribución de la salud del humano.
Agradecimientos
V. Rodríguez-Guerrero agradece al Consejo Nacional de Ciencia y Tecnología (CONACyT) por el financiamiento para la culminación de sus estudios de maestría.
Referencias
Ainsley, R.A., Champagne, C.P., Gardner, P.N., Fustier, P. y Vuillemard, J.C. 2007. Survival in Food Systems of Lactobacillus rhamnosus R011 Microentrapped in Whey Protein Gel Particles. Journal of Food Science. 72(2): M31-M37.
Alvarado-Rivas, C.C. y Díaz-Rivera, C.G. 2009. Estudio preliminar del potencial probiótico de lactobacilos aislados de pastizal de una finca lechera. Revista Facultad de Farmacia. 51(1):814.
Anal, A.K. y Singh, H. 2007. Recent advances in microencapsulation of probiotics for industrial applications and targeted delivery. Trends in Food Science and Technology. 18: 240-251.
Chou, Ch. y Weimer, B. 1999. Isolation and Characterization of Acid- and Bile-Tolerant Isolates from Strains of Lactobacillus acidophilus Journal Dairy Science. 82:23–31.
Collins, D. y Gibson, G.R. 1999. Probiotics, prebiotics, and synbiotics: approaches for modulating the microbial ecology of the gut. American Journal Clinical Nutrition. 69:1052S–1057S.
Del Piano, M., Morelli, L., Strozzi, G.P., Allesina, S., Barba, M., Deidda, F., Lorenzini, P., Ballaré, M., Montino, F., Orsello, M., Sartori, M., Garello, E., Cramagnola, S., Pagliarulo, M. y Carpuso, L. 2006. Probiotics: from research to consumer. Digestive and Liver Disease. 38(2):S248–S255.
Ding, W.K. y Shah, N.P. 2009. Effect of various encapsulating material on the stability of probiotic bacteria. Journal of Food Science. 74(2):M100M107.
Ewaschuk, J.B. y Dieleman L.A. 2006. Probiotics and prebiotics in chronic inflammatory bowel Diseases. World Journal of Gastroenterology. 12(37):5941-5950.
en Alimentos 4-2 (2010): 48-57
Ferrer, L.B. y Dalmau, S.J. 2001. Alimentos funcionales: probióticos. Acta Pediátrica Española. 59: 150-155.
García, C.A., Henríquez, A.P., Retamal, R.C., Pineda, C.S., Delgado, Sch. C. y González, C.C. 2009. Propiedades probióticas de Lactobacillus spp aislados de biopsias gástricas de pacientes con y sin infección por Helicobacter pylori. Revista Médica Chile. 137: 369-376.
González, R.F. y González-Martínez, B.E. 2006. Criterios de calidad de los microorganismos probióticos y evidencias sobre efectos hipocolesterolémicos. Revista Salud Pública y Nutrición. 7(1): 1-8.
Guarner, F. 2002. El colon como órgano: hábitat de la flora bacteriana. Nutrición Hospitalaria. 17:7-10.
Guarner, F. 2007. Papel de la flora intestinal en la salud y en la enfermedad. Nutrición Hospitalaria 22(2):14-19.
Hart, A.L., Stagg, A.J., Frame, M., Graffner, H., Glise, H., Falk, P. y Kamm, M. A. 2002. The role of the gut flora in health and disease, and its modification as therapy. Alimentary Pharmacology Therapeutic. 16: 1383–1393.
Iñiguez-Palomares C., Pérez-Morales R., y AcedoFélix E. 2006.Mecanismo de adhesión al tracto intestinal y antagonismo de Bifidobacterium Revista Salud Publica y Nutrición. 7(2):1-10.
Ki-Yong, L. y Tae-Ryeon, H. 2000. Survival of Bifidobacterium longum inmovilized in calcium alginate beads in simulated gastric juices and biles salt solution. Applied and Environmental Microbiology. 66(2):869-873.
Komenan, G. G., Vandamme, T. Ennahar, S. y Marchioni, E. 2009. Microencapsulation of Lactobacillus plantarum spp in an alginate matrix coated with whey proteins. International Journal of Food Microbiology. 129:103-105.
Krasaekoopt, W., Bhandari, B. y Deeth, H. 2003. Evaluation of encapsulation techniques of probiotics for yoghurt. International Dairy Journal. 13:3–13.
Marteau, P. y Shanahan, 2003. F. Basic aspects and pharmacology of probiotics: an overview of pharmacokinetics, mechanisms of action and sideeffects. Best Practice & Research Clinical Gastroenterology. 17(5):725–740.
McMaster, L.D., Cocotte, S. A., y Slater. P. 2005. Micro-encapsulation of Bifidobacterium lactis for incorporation into soft foods. World Journal of Microbiology & Biotechnology. 21:723–728.
Miranda-Novales, M.G. 2008. Probióticos y Micronutrimentos ¿Son útiles para el tratamiento de la diarrea aguda? Boletín Médico del Hospital Infantil México. 65: 157-166.
Mombelli, B. y Gismondo, M.R. 2000. The use of probiotics in medical practice. International Journal of Antimicrobial Agents. 16:531–536.
Nomoto, K. 2005. Prevention of Infections by Probiotics. Journal of Bioscience and Bioengineering. 100(6):583–592.
Peña, A. S. 2007. Flora intestinal, probióticos, prebióticos, simbióticos y alimentos novedosos. Revista Española de Enfermedades Digestivas 99(11): 653-658.
Peregrina, G.R., Orozco, H.L.O. y Torres, V.M.R. 2006. Probióticos. En Torres, V.M.R. y Castillo, A.A. (Eds). Microbiología de los Alimentos. Universidad de Guadalajara. Guadalajara. México. pp.485-514.
Rodríguez, M.B.S., Monereo, M.S. y Molina, B.B. 2003. Alimentos funcionales y nutrición óptima. ¿Cerca o lejos?. Revista Española de Salud Pública. 77(3): 317-331.
Rokka, S. y Rantamäki, P. 2010. Protecting probiotic bacteria by microencapsulation: challenges for
en Alimentos 4-2 (2010): 48-57
industrial applications. European Food Reserch Technology. 231:1-12.
Rolfe, R.D. 2000. The Role of Probiotic Cultures in the Control of Gastrointestinal Health. Journal of Nutrition. 130: 396S–402S.
Sanz, Y., Collado, M.C. y Dalmau J. 2003. Probióticos: criterios de calidad y orientaciones para el consumo. Acta Pediatríca Española. 61: 476-482.
Sanz, Y., Collado, M.C., Dalmau, J. 2006. Contribución de la microbiota intestinal y del género Bifidobacterium a los mecanismos de defensa del huésped frente a patógenos gastrointestinales. Acta Pediátrica Española. 64: 74-78.
Vanderplass, I. 2002 Papel de los Agentes Bioterapéuticos en el Tratamiento de la Diarrea Medwave. http://www.mednet.cl/link.cgi/Medwave/Congres os/2001ped1/1180. Accesada 10/09/2010.
Vidal, R.D. 2006. Probióticos: aspectos microbiológicos y tecnológicos. Alimentación, Nutrición y Salud. 13(2):48-52.
Zhao, R., Sun, J., Torley, P., Wang, D. y Niu, S. 2008. Measurement of particle diameter of Lactobacillus acidophilus microcapsule by spray drying and analysis on its microstructure. World Journal Microbiology & Biotechnology. 24:1349–1354

Temas Selectos de Ingeniería de Alimentos 4 – 2 (2010): 58 - 67
Frutas conservadas por métodos combinados
M.E. González-Miguel *, A. López-Malo

Departamento de Ingeniería Química, Alimentos y Ambiental. Fundación Universidad de las Américas Puebla. Ex Hacienda Sta. Catarina Mártir, Cholula, Puebla. C.P.72810. México.
Resumen
Esta revisión bibliográfica presenta una breve descripción del mecanismo de acción de algunos factores de estrés microbiano, que al aplicarlos de manera combinada, dan lugar a la llamada conservación por métodos combinados o tecnología de obstáculos. La estabilidad microbiana y la seguridad de muchos alimentos se basan en la combinación de varios factores (obstáculos). El concepto obstáculo explica el hecho de que las interacciones complejas entre factores de estrés microbiano tales como aw, pH, temperatura y adición de antimicrobianos, son significativas para la estabilidad microbiana de los alimentos. Se toma como ejemplo de aplicación de esta tecnología a las frutas, que por su naturaleza ácida y dulce, permite de manera relativamente sencilla y económica, la aplicación combinada de factores para conservarlas. Así mismo, se incluyen resultados de algunas investigaciones en la aplicación de la tecnología de obstáculos en la conservación de frutas por periodos prolongados.
Palabras clave: métodos combinados, pH, actividad de agua, agentes antimicrobianos, bacterias, mohos.
Abstract
This review presents a brief description of the mechanism of action of some microbial stress factors which when applied in combination offer the so-called preservation by combined methods or hurdle technology. Microbial stability and safety of many foods are based on a combination of several factors (hurdles). The hurdle concept explains the complex interactions between microbial stress factors such as aw, pH, temperature, and addition of antimicrobials which are significant to the microbial stability of foods. A good example of the application of this technology is in fruits, which result in a simple and economic application of combined methods due to its acid and sweet nature. This review also includes research results on the application of hurdle technology in the preservation of fruits for extended periods.
Keywords: combined methods, pH, water activity, antimicrobial agents, bacteria, molds.
Introducción
Las frutas forman un grupo muy variado de alimentos y son una fuente importante de nutrientes para los seres humanos. La mayoría de las frutas se pueden consumir en su estado fresco; y con algunas excepciones
su vida útil o de anaquel es relativamente corta. En algunos casos el almacenamiento refrigerado puede prolongar la vida útil de las frutas frescas. Sin embargo, para aprovechar las frutas por periodos prolongados es necesario transformarlas en productos menos perecederos mediante el
empleo de diversas técnicas o metodologías de conservación. Estas metodologías se basan en eliminar todos aquellos microorganismos patógenos y disminuir y controlar la proliferación de la flora deteriorativa, así como en la inactivación de todas las reacciones bioquímicas, producto de la actividad enzimática, que pueden deteriorar el producto (Vergara y LópezMalo, 2004).
Una forma simple y de bajo costo para la conservación de frutas es la tecnología de los obstáculos o métodos combinados, la cual se basa en la aplicación simultánea de varios factores de conservación, que por sí mismos aplicados de forma individual no son suficientes para conservar el alimento. Estos factores se aplican en forma leve, de tal manera que cada uno de ellos es un obstáculo para el crecimiento de los microorganismos, pero causa un daño mínimo a la calidad del producto (Fernández y Sluka, 2005).
El fundamento de la aplicación de métodos combinados es exponer a las células vegetativas de los microorganismos simultáneamente a varios factores adversos, de manera que los mecanismos homeostáticos que poseen los microorganismos y que son altamente consumidores de energía, trabajen de más al tratar de ajustarse al medio. De este modo, los microorganismos no tendrán energía disponible para el crecimiento y reproducción por lo que quedarán en un estado latente o morirán (Yáñez y Reyes, 2006).
La importancia práctica de la tecnología de obstáculos es reconocida por la industria alimentaria y es ampliamente empleada en el diseño de nuevos productos, en el cual se busca desarrollar productos de alta calidad que cubran necesidades específicas. Los obstáculos que se elijan deben mantener la
seguridad, una calidad parecida a la de los productos frescos, y aumentar la vida de almacenamiento del producto (Wiley, 1994).
El objetivo de este trabajo es hacer una revisión de estudios, en los que se haya evaluado la aplicación de métodos combinados en frutas para su conservación
Revisión bibliográfica
1. Frutas
Las frutas son un conjunto de alimentos vegetales que proceden del fruto de determinadas plantas, ya sean hierbas como la melonera o árboles como el manzano y poseen un sabor y un aroma característico. Aun después de cosechadas, las células de las frutas no mueren inmediatamente. Sin embargo, para no morir y seguir siendo comestibles, las células vegetales requieren energía. Ésta la obtienen de la oxidación de nutrientes ricos en energía, principalmente carbohidratos, almacenados en las células. Comúnmente se utiliza oxígeno y se elimina bióxido de carbono a medida que estos constituyentes almacenados son empleados como fuente de energía. Este proceso que es llamado respiración, entre más lento sea, las células pueden vivir más tiempo. El almacenamiento a bajas temperaturas es la técnica que más se utiliza para disminuir la respiración y prolongar el periodo de almacenamiento durante el cual las frutas tienen una calidad aceptable. La regulación de la concentración de oxígeno y de bióxido de carbono en la atmósfera del ambiente para controlar la respiración, se emplea en la actualidad a fin de prolongar la vida de almacenamiento de ciertas frutas (Vargas et al., 2000).
La gran variedad de texturas que se pueden encontrar entre las frutas se debe en
muchos casos a componentes celulares específicos y a su relación con la gran cantidad de agua presente. (Vergara y López-Malo, 2004).
Durante la maduración de las frutas ocurren cambios importantes en el contenido de sustancias pécticas, celulosas y hemicelulosas lo que contribuye al ablandamiento. Los procesos de envejecimiento de las frutas, después de alcanzar la maduración, en general se acompañan de un ablandamiento de los tejidos, muchas veces atribuido a la acción de las enzimas naturalmente presentes las frutas. Las enzimas hidrolizan a la pectina en un punto donde se pierde su acción como gelificante. La enzima responsable de esto es conocida como pectinmetilesterasa o pectinesterasa (Vergara y López-Malo, 2004).
Los tejidos de las frutas dañados expuestos al aire sufren un oscurecimiento rápido debido a la acción de las enzimas peroxidasa y polifenoloxidasa, las que catalizan la oxidación de compuestos fenólicos incoloros a o-quinonas que producen pigmentos marrones u oscuros por polimerización o reaccionan con las antocianinas (Badui, 2006).
La composición proximal en general de las frutas es de un 85% de agua, 13% de carbohidratos, 0.9% proteína, 0.5% de grasa y 0.5% de cenizas; el contenido de vitaminas y otros compuestos orgánicos difiere según la especie. Este contenido de nutrientes favorece el crecimiento de bacterias, levaduras y mohos. Sin embargo, el pH de las frutas es inferior al nivel que generalmente favorece el crecimiento bacteriano, lo que explica la ausencia de las bacterias en el deterioro de frutas. El intervalo de pH al cual crecen las levaduras y los mohos es inferior a 4.0, de ahí que estos microorganismos son considerados
como los principales causantes del deterioro de frutas (Jay et al., 2006).
2. Factores de estrés microbiano
2.1 Actividad de agua
El término contenido de humedad se emplea para referirse a la cantidad de agua presente en un alimento (Welti-Chanes y Vergara, 1997). La actividad de agua (aw) puede ser considerada como una medida indirecta del agua que está disponible en un producto para participar en diferentes reacciones deteriorativas y en el crecimiento microbiano (Fennema, 2000). Por lo tanto, hay una relación estrecha entre la estabilidad de un producto y su actividad de agua.
Christian (2000) menciona que la aw óptima para el crecimiento de la mayor parte de los microorganismos está en el intervalo 0.99-0.98. Cuando un microorganismo se coloca en una solución acuosa concentrada de un soluto de aw reducida, el agua es extraída del citoplasma de la célula y se pierde la presión de turgor. Gould (1998) señala que la homeostasis (o equilibrio interno) se perturba y el organismo no se multiplica pero permanece en fase lag hasta que se restablezca el equilibrio. El microorganismo reacciona para recuperar el agua perdida acumulando en el citoplasma los llamados solutos compatibles hasta que la osmolaridad interna sea ligeramente mayor a la de la solución y así el agua vuelve a entrar en la célula. Se restablece la presión de turgencia (estado de rigidez de la célula) y el microorganismo continúa creciendo. Los solutos compatibles no interfieren con las actividades normales de la célula y pueden ser sintetizados dentro de la misma o transportados desde el medio. En cualquiera de los dos casos, el proceso consume energía y, por lo tanto, la energía disponible para el crecimiento disminuye. Si la reducción en la aw es extrema, la célula
microbiana es incapaz de reparar la homeostasis y no puede ya proliferar e incluso puede morir. La capacidad osmoregulatoria, y en consecuencia los límites de aw que permiten el crecimiento, difieren entre los microorganismos.
En general, las bacterias de deterioro comunes se inhiben a aw aproximadamente 0.97; los clostridios patógenos a aw 0.94, y la mayoría de los Bacillus a aw 0.93. Staphylococcus aureus es el patógeno que posee mayor tolerancia a la aw y puede crecer en aerobiosis a aw de 0.86. Muchos mohos y levaduras son capaces de proliferar a aw debajo de 0.86; algunas levaduras osmofílicas y hongos xerófilos pueden crecer en forma lenta a aw ligeramente mayor a 0.60. En consecuencia, para conservar un alimento utilizando como factor de estrés sólo la reducción de aw, ésta debiera disminuirse a 0.60. Los alimentos totalmente deshidratados, por ejemplo, tienen valores de aw aproximadamente iguales a 0.30 para controlar no sólo el crecimiento microbiano sino también otras reacciones de deterioro (Leistner, 2000).
2.2 Potencial de hidrógeno (pH)
Booth y Stratford (2003) mencionan que el pH es uno de los obstáculos más importantes en la conservación de frutas de alta humedad mínimamente procesadas, debido a que juega el principal papel en la determinación del tipo de microorganismos que pueden crecer, el índice de crecimiento, su resistencia térmica y la actividad de los agentes antimicrobianos. Hocking y Pitt (2009) realizó estudios en los que identificó que los mohos y las levaduras son los microorganismos más ácido-tolerantes encontrados en los alimentos. Son capaces de crecer y causar deterioro en alimentos con pH por debajo de 4. En alimentos conservados mediante acidificación por adición de ácido, su velocidad de
crecimiento y su índice de producción de metabolitos como productos finales, puede exceder a los de las bacterias contaminantes. El deterioro causado por levaduras, regularmente limita la vida de anaquel de los productos de frutas. El crecimiento microbiano durante el almacenamiento puede alterar el pH. El metabolismo de los carbohidratos por los microorganismos puede generar ácidos débiles, especialmente bajo condiciones anaerobias, los cuales pueden disminuir el pH. Por el contrario, cuando el pH aumenta es signo de que las fuentes fermentables de carbohidratos en el alimento se han agotado y el metabolismo de compuestos nitrogenados ha comenzado. Para controlar el crecimiento microbiano totalmente, el pH requerido en ausencia de otros factores de conservación sería tan bajo que causaría el rechazo de los productos por sus características sensoriales (Argaiz et al., 1995).
2.3 Agentes antimicrobianos
Son compuestos que se utilizan para controlar el crecimiento microbiano; algunos tienen un alto grado de especificidad contra cierto tipo de microorganismos, mientras que otros presentan un espectro de acción muy amplio y pueden inhibir una gran variedad de ellos. La efectividad de los antimicrobianos depende de varios factores intrínsecos del propio alimento, como son su composición, pH, el nivel inicial de contaminación microbiana y la forma en que se maneje y distribuya el producto terminado. Entre los más comunes están los agentes antimicrobianos clasificados como ácidos orgánicos débiles, como el ácido benzoico y el ácido sórbico y sus respectivas sales como el benzoato de sodio y sorbato de potasio (Sofos, 1989).
La actividad antimicrobiana del benzoato está relacionada con el pH, siendo su mayor actividad a valores de pH bajos. A través de
la forma no disociada tiene su acción antimicrobiana, ya que puede penetrar al interior de la célula y disociarse, lo que da como resultado un decremento del valor de pH afectando la respuesta de crecimiento de microorganismos. El pK del benzoato es 4.20; A pH de 4.0 el 60% lo constituye la forma no-disociada mientras que a pH de 6.0 la forma no-disociada representa tan sólo el 1.5%. El benzoato actúa mejor en su forma no disociada porque facilita la pérdida de protones en la célula y, por lo tanto, aumenta la necesidad de energía para mantener el pH habitual. El sorbato tiene un pK de 4.8; a pH de 4.0 la fracción no disociada es aproximadamente del 80% y a pH de 6.0 sólo se encuentra no-disociado un 6% (Jay et al., 2006).
El crecimiento microbiano en presencia de agentes antimicrobianos se impide al inhibir el consumo por la célula de moléculas de sustrato, tales como aminoácidos, fosfatos, ácidos orgánicos y similares. La inhibición de los mohos por el sorbato de potasio se debe a la inactivación de los sistemas enzimáticos tales como la deshidrogenasa (Sofos, 1989). El benzoato y sorbato son metabolizados en el cuerpo a CO2 y H2O, de la misma manera que los ácidos grasos de los alimentos (Jay et al., 2006).
2.4 Temperatura
La temperatura es un factor ambiental que influye de manera importante en la velocidad de crecimiento, la actividad metabólica, los requerimientos nutricionales, la composición química y la velocidad de captación de sustratos de los microorganismos. De esta manera, durante el tratamiento térmico se aplican temperaturas mayores a las que el microorganismo puede crecer, provocando, de acuerdo a su severidad y tiempo de aplicación, inactivación o lesión subletal de los microorganismos. El calor causa
múltiples efectos en los componentes celulares de los materiales biológicos. Sin embargo, se han identificado cuatro blancos principales relacionados al daño térmico letal y no letal: el ADN, el ARN, los ribosomas, las membranas citoplasmáticas y enzimas específicas (Brock y Madigan, 1993).
Por otro lado, la refrigeración provoca la inhibición o inactivación de algunas células vegetativas, inhibición del crecimiento de mesófilos y termófilos, así como disminución de la velocidad de crecimiento de los microorganismos psicrótrofos (Alzamora et al., 1995).
2.4.1. Escaldado
Es una operación relacionada con la transmisión de calor, pero no es un proceso de esterilización ni de conservación. La finalidad del escaldado es la inactivación de enzimas presentes en ciertos alimentos que posteriormente van a ser enlatados, congelados o deshidratados. De no proceder de esta forma, la actividad enzimática residual de estos alimentos podría dar lugar a la aparición de colores, sabores y olores indeseables. Además el escaldado presenta una serie de ventajas importantes, ya que al realizase con agua, es un sistema eficaz de lavado y limpieza de los alimentos al tiempo que los reblandece mejorando su textura. Asimismo, el aumento de la temperatura provoca el desprendimiento de los gases ocluidos en el alimento (Seoánes, 2003). Estos gases son parte del metabolismo celular, ya que la eliminación de los gases en los espacios intercelulares permite que se genere un vacío relativo (Sanchez-Pineda, 2003) y esta desgasificación favorece las operaciones posteriores. Los métodos de escaldado más utilizados son la inmersión en agua caliente y el tratamiento con vapor de agua y el menos usual es la radiación por microondas (Seoánes, 2003). También el
escaldado contribuye a fijar el color y retener el sabor (Sanchez-Pineda, 2003).
2.4.2.
Refrigeración
El enfriamiento de un producto frena el crecimiento microbiológico y la alteración bioquímica, lo que trae como consecuencia el aumento en la vida útil del producto. El almacenamiento a bajas temperaturas reduce el nivel de respiración y de maduración de las frutas. También es importante el efecto de la temperatura sobre el tiempo de germinación de las esporas fúngicas; en la medida que se cuenta con condiciones de almacenamiento a temperaturas bajas, el grado de expansión del micelio se reduce (Ulloa, 2007).
3. Métodos combinados
Las técnicas de conservación se aplican para controlar el deterioro de la calidad de los alimentos. Este deterioro puede ser causado por microorganismos y/o por una variedad de reacciones físico-químicas que ocurren después de la cosecha. Sin embargo, la prioridad de cualquier proceso de conservación es minimizar la probabilidad de ocurrencia y crecimiento de microorganismos deteriorativos y patógenos. Desde el punto de vista microbiológico, la conservación de alimentos consiste en exponer a los microorganismos a un medio hostil para prevenir o retardar su crecimiento, disminuir su supervivencia o causar su muerte. Leistner y Gould (2002) mencionan que factores como la acidez, la limitación del agua disponible para el crecimiento, la presencia de conservadores, las temperaturas bajas, la limitación de nutrientes, entre otros, contribuyen a la creación de un medio adverso para el crecimiento microbiano.
Para las células vegetativas, en las que la homeostasis depende de la energía, el
objetivo es reducir la disponibilidad de energía, lo cual puede lograrse removiendo oxígeno, limitando los nutrientes o reduciendo la temperatura, o bien, incrementar la demanda de energía, reduciendo la actividad de agua o el pH. En el caso de las esporas, en los que la homeostasis depende de la estructura del microorganismo y no de la energía disponible, el objetivo es dañar las estructuras clave o bien, hacer germinar las esporas (con el uso de altas presiones) y posteriormente tratarlas como células vegetativas (Alzamora et al., 1995).
La tecnología de obstáculos (también llamada métodos combinados, procesos combinados, conservación por combinación, técnicas combinadas) conserva los alimentos mediante la aplicación de factores de estrés microbiano en combinación (Leistner y Gorris, 1995).
En los países industrializados, con disponibilidad de energía e infraestructura y con amplio uso de la refrigeración, el concepto de obstáculo se ha aplicado principalmente a desarrollar una gran variedad de alimentos con procesamiento térmico leve, distribuidos en forma refrigerada o congelada. Por el contrario, en muchos países en desarrollo, la refrigeración es cara y no está siempre disponible. De la misma forma, los procesos de enlatado y los procesos asépticos requieren una inversión importante y la demanda energética es muy alta. Por tanto, el énfasis del enfoque combinado se ha puesto en el desarrollo de alimentos estables a temperatura ambiente, con requerimientos energéticos, de equipamiento y de infraestructura mínimos, tanto para el procesamiento como para la distribución y el almacenamiento (Leistner y Gould, 2002).
3.2. Aplicaciones
Las aplicaciones más comunes de los métodos combinados, comprenden alimentos con aw reducida (por ejemplo por deshidratación parcial o por agregado de sales o azúcares), usualmente combinada con acidificación y adición de antimicrobianos; alimentos fermentados; alimentos con pH reducido y antimicrobianos naturales (tales como hierbas y especias y sus extractos) o sintéticos; y alimentos envasados con exclusión del oxígeno (por ejemplo alimentos envasados al vacío o alimentos cubiertos con una capa de aceite) (Leistner y Gould, 2002).
Argaiz (2004) propuso un método para la conservación de frutas por medio de la tecnología de obstáculos, aplicando el procedimiento de lavar el producto, pelar, cortar, escaldar y estabilizar osmóticamente con un jarabe adecuado de composición tal que en el equilibrio se tengan los niveles deseados de aw, pH y concentración de antimicrobianos. Una vez alcanzado el equilibrio (100-120 horas) la fruta se reempaca con la mínima cantidad de jarabe.
La Tabla I muestra las condiciones de tratamiento para la conservación de frutas por métodos combinados. En todos los casos se encontró que la vida de anaquel a temperatura ambiente fue superior a 6 meses (Argaiz, 2004).
López-Malo et al. (1994) preservaron papaya mínimamente procesada logrando una estabilidad microbiológica y sensorial de 5 meses a 25°C, por medio de la tecnología de métodos combinados, reduciendo la aw y el pH, y adicionando sorbato de potasio y bisulfito de sodio. Estos autores encontraron que no hubo diferencias significativas entre los productos almacenados a 5°C y 25°C, mostrando una buena aceptabilidad.
Argaiz et al. (1994) evaluaron la estabilidad durante el almacenamiento a 5°C y 35°C de trozos de papaya conservados por factores combinados aplicando concentración osmótica y un secado superficial final. La papaya estabilizada y deshidratada alcanzó una aw de 0.97 y un pH de 3.9. Para ambas temperaturas los conteos microbianos demostraron que el producto es estable durante 2 meses. Los resultados de los análisis sensoriales indicaron que los productos fueron iguales durante las primeras seis semanas y fueron diferentes pero igualmente preferidos el resto de los dos meses de almacenamiento.
En duraznos se realizó una sustitución parcial de sacarosa por glucosa como depresor de la actividad de agua y ácido cítrico por ácido fosfórico como acidulante obteniendo buena aceptación, utilizando como antimicrobianos sorbato de potasio y bisulfito de sodio (Argaiz et al., 1993).
Entre los productos que representan la aplicación racional del enfoque combinado y que pueden ser almacenados a temperatura ambiente pueden citarse las frutas de alta humedad similares a las frescas conservadas por la interacción de reducción de la awtratamiento térmico suave – reducción del pH- antimicrobianos (Alzamora et al., 1995).
Las frutas mínimamente procesadas (FMP) por métodos combinados, también llamadas frutas de alta humedad, son la respuesta al creciente énfasis de los consumidores en su demanda por los productos similares al fresco con una alta calidad sensorial y nutritiva; que les garanticen seguridad a su salud, y que además ofrezcan ventajas de facilidad y comodidad. Esta tecnología fue desarrollada con el objeto principal de obtener un producto con características de frescura (sensorialmente similar al producto fresco),
M. E. González - Miguel et al. / Temas
en Alimentos 4-2 (2010): 58-67
Tabla I. Condiciones de tratamiento para la conservación de frutas por métodos combinados.
Producto aw Agente depresor de aw
Cereza 0.95 - 0.96
0.92 - 0.96
Durazno
Sacarosa, 70% jarabe de maíz-sacarosa-agua (5/3/1)
Sacarosa, glucosa
0.94 Glucosa 51%
Manzana 0.98 Sacarosa 37.5%
Papaya 0.98 Sacarosa 37.5%
0.97 Glucosa 40%
Piña
0.98 Sacarosa 37.5%
Otros factores de conservación
AA=1%, EV pH= 3.6
P=75°C, 30´
E= 100°C, 5´ pH= 3.3 - 3.9
S= 420-560 ppm
SK = 0.1 - 0.22%
E= 100°C, 2´ pH= 3.5
S= 150 ppm
SK = 0.1 %
E= 93°C, 2´ pH= 3.7
S= 150 - 440 ppm
SK = 0.1 %
E= 93°C, 2´ pH= 3.8
S= 150 ppm
SK = 0.1 %
E= 100°C, 2´ pH= 3.1
S= 150 ppm
SK = 0.1 %
E= 93°C, 2´ pH= 3.7
S= 150 ppm
SK = 0.1 %
AA = ácido ascórbico, EV = empacado al vacío, P = pasterización, E = escaldado, SK = sorbato de potasio y S = sulfitos.
*Adaptada de Argaiz (2004)
con la vida de anaquel extendida (aún bajo condiciones de almacenamiento a temperatura ambiente), utilizando una tecnología simple y energéticamente eficiente. Esto conduce a concluir que la tecnología de métodos combinados aplicada a frutas mínimamente procesadas, ofrece una alternativa interesante para el procesamiento
de frutas con relación a los métodos convencionales de conservación (Alzamora et al., 1995).
Conclusiones
Las investigaciones científicas realizadas hasta ahora han demostrado que el daño que
sufren los alimentos por contaminación microbiana se puede prevenir y controlar mediante la aplicación de la tecnología de métodos combinados, utilizando para ello la reducción de la actividad de agua y el pH, la adición de agentes antimicrobianos, el almacenamiento en refrigeración, entre otros. Por lo anterior, las frutas procesadas y preservadas por métodos combinados cumplen con las demandas y expectativas actuales de los consumidores, respecto a la existencia de alimentos con características similares a los productos frescos, con una vida útil satisfactoria y atributos sensoriales aceptables.
Agradecimientos
M.E. González-Miguel agradece al Consejo Nacional de Ciencia y Tecnología (CONACyT) por el financiamiento de sus estudios de maestría.
Referencias
Alzamora, S.M., Cerrutti, P., Guerrero, S. y LópezMalo, A. 1995. Minimally processed fruits by combined methods. En J. Welti-Chanes y G. Barbosa-Cánovas (Eds). Food preservation by moisture control fundamentals and applications Technomic, Lancaster, EE.UU. pp. 463-492.
Argaiz, A. 2004. Frutas tropicales, alternativas para su procesamiento o transformación. En: Conservación de productos de frutas. Sociedad Solidaridad Social Yancuitzin Tonatlzin. Departamento de Ingeniería Química, Alimentos y Ambiental. Universidad de las Americas Puebla Mexico.120 p.
Argaiz, A., López- Malo, A y Welti-Chanes, J.1995. Cinética de primer cambio en el sabor, desarrollo de sabor a cocido e inactivación de pectinesterasa en néctares y purés de mango y papaya. Rev. Esp. Cienc. Tecnol. Aliment. 35 (1):55-58.
Argaiz, A., Palou, E. y López-Malo, A. 1994. Estabilidad durante el almacenamiento de papaya
conservada por factores combinados aplicando concentración osmótica y secado. Boletín de divulgación de los grupos mexicanos. CYTED. 4: 9-17.
Argaiz, A., Welti-Chanes, J. y López-Malo, A. 1993. Durazno Conservado por factores combinados. Boletín Internacional de Divulgación. CYTED. 1: 22-30.
Badui, D.S. 2006. Química de los alimentos. Cuarta edición. Pearson Educación, México.716 p.
Booth, I.R y Stratford, M. 2003. Acidulants and low pH. En: N.J. Russell y G.W. Gould (Eds) Food Preservatives. Segunda edición, Springer, Inglaterra. 320 p.
Brock, T.D. y Madigan, M.T. 1993. Microbiología Sexta edición. Prentice Hall, México. 956 p.
Christian, J. H. 2000. Drying and reduction of water activity. En: B. M. Lund, T. C. Baird-Parker y G. W. Gould (Eds). The Microbiological Safety and Quality of Food. Vol.1. Aspen Publishers, Inc. EE.UU. 2080 p.
Fennema, O.R. 2000. Química de los alimentos Segunda edición. Acribia. Barcelona, España. 1258 p.
Fernández, R.E.,y Sluka, E.E. 2005. Conservation technologies applying combined methods in pepper, bean and eggplant. Rev. FCA UNCuyo Tomo XXXVII. N° 2. 73-81.
Gould, G. W. 1998. Interference with homeostasisfood. En: R. Whittenbury, G. W.Gould, J. G.Banks y R. G. Board (Eds). Homeostatic Mechanisms in Micro-organisms. Bath University Press. Inc. EE.UU. 281 p.
Hocking, A. D. y Pitt, J.I. 2009. Fungi and food spolaige. Tercera edición. Springer. Australia. 519 p.
Jay, J.M., Loessner, M.J., y Golden, D.A. 2006. Modern Food Microbiology. Seventh edition. Springer. New Dheli, India. 790 p.
Leistner, L. y Gorris, L. G. 1995. Food preservation by hurdle technology. Trends in Food Science Technology. 6:41-46.
Leistner, L. y Gould, G. W. 2002. Hurdle Technologies: Combination Treatments for Food Stability, Safety and Quality. Kluwer Academic/Plenum Publishers, Nueva York, EE.UU. 194 p.
M. E. González - Miguel et al. / Temas Selectos de
Leistner, L. 2000. Hurdle technology in the design of minimally processed foods. En: S. M. Alzamora, M. S. Tapia y A. López-Malo (Eds). Minimally Processed Fruits and Vegetables. Fundamentals Aspects and Applications. Springer. India. pp. 1327.
López-Malo, A., Palou, E. y Welti-Chanes, J.1994. Shelf-stable high moisture papaya minimally processed by combined methods. Food Res. Int 27: 545-55.
Sánchez-Pineda, M.T. 2003. Procesos de elaboración de alimentos y Bebidas. Primera edición. Mundi Prensa. Madrid, España. 518 p.
Seoánes, C.M. 2003. Manual de tratamiento reciclado, aprovechamiento y gestión de las aguas residuales de las industrias agroalimentarias. Primera edición. Mundi Prensa, Madrid, España. 465 p.
Sofos, J.N. 1989. Sorbate Food Preservatives. CRC Press. EE.UU. 231 p.
Ulloa, J.A. 2007. Frutas auto estabilizadas en envases por la tecnología de obstáculos. Primera edición. Universidad Autónoma de Nayarit. Mexico.158 p.
en Alimentos 4-2 (2010): 58-67
Vargas, O.W., Cepeda, O.R. y Barriga,O.R.2000. Tecnología de manejo de postcosecha de frutas y hortalizas. Quinta edición. Instituto interamericano de cooperación para la agricultura. Colombia. 245 p.
Vergara, B. F. y López-Malo A. 2004. Conservación de productos de frutas. Sociedad Solidaridad Social Yancuitzin Tonatlzin. Departamento de Ingeniería Química, Alimentos y Ambiental. Universidad de las Américas Puebla Mexico.7273p.
Welti-Chanes, J. y Vergara, F. 1997. Actividad de agua. Conceptos y aplicación en alimentos con alto contenido de humedad. En: Aguilera, J.M. Temas en la tecnología de alimentos. Vol. 1 CYTED. Instituto Politécnico Nacional. Mexico.481 p.
Wiley, R.C. 1994. Minimally processed refrigerated fruits and vegetables. Primera edición. Chapman & Hall. Nueva York, EE.UU. 368 p.
Yañez, F.J. y Reyes, C.R. 2006. Estabilización de pulpa de mamey por métodos combinados. Ciencia y Tecnología de Alimentos 16(3):121-125.